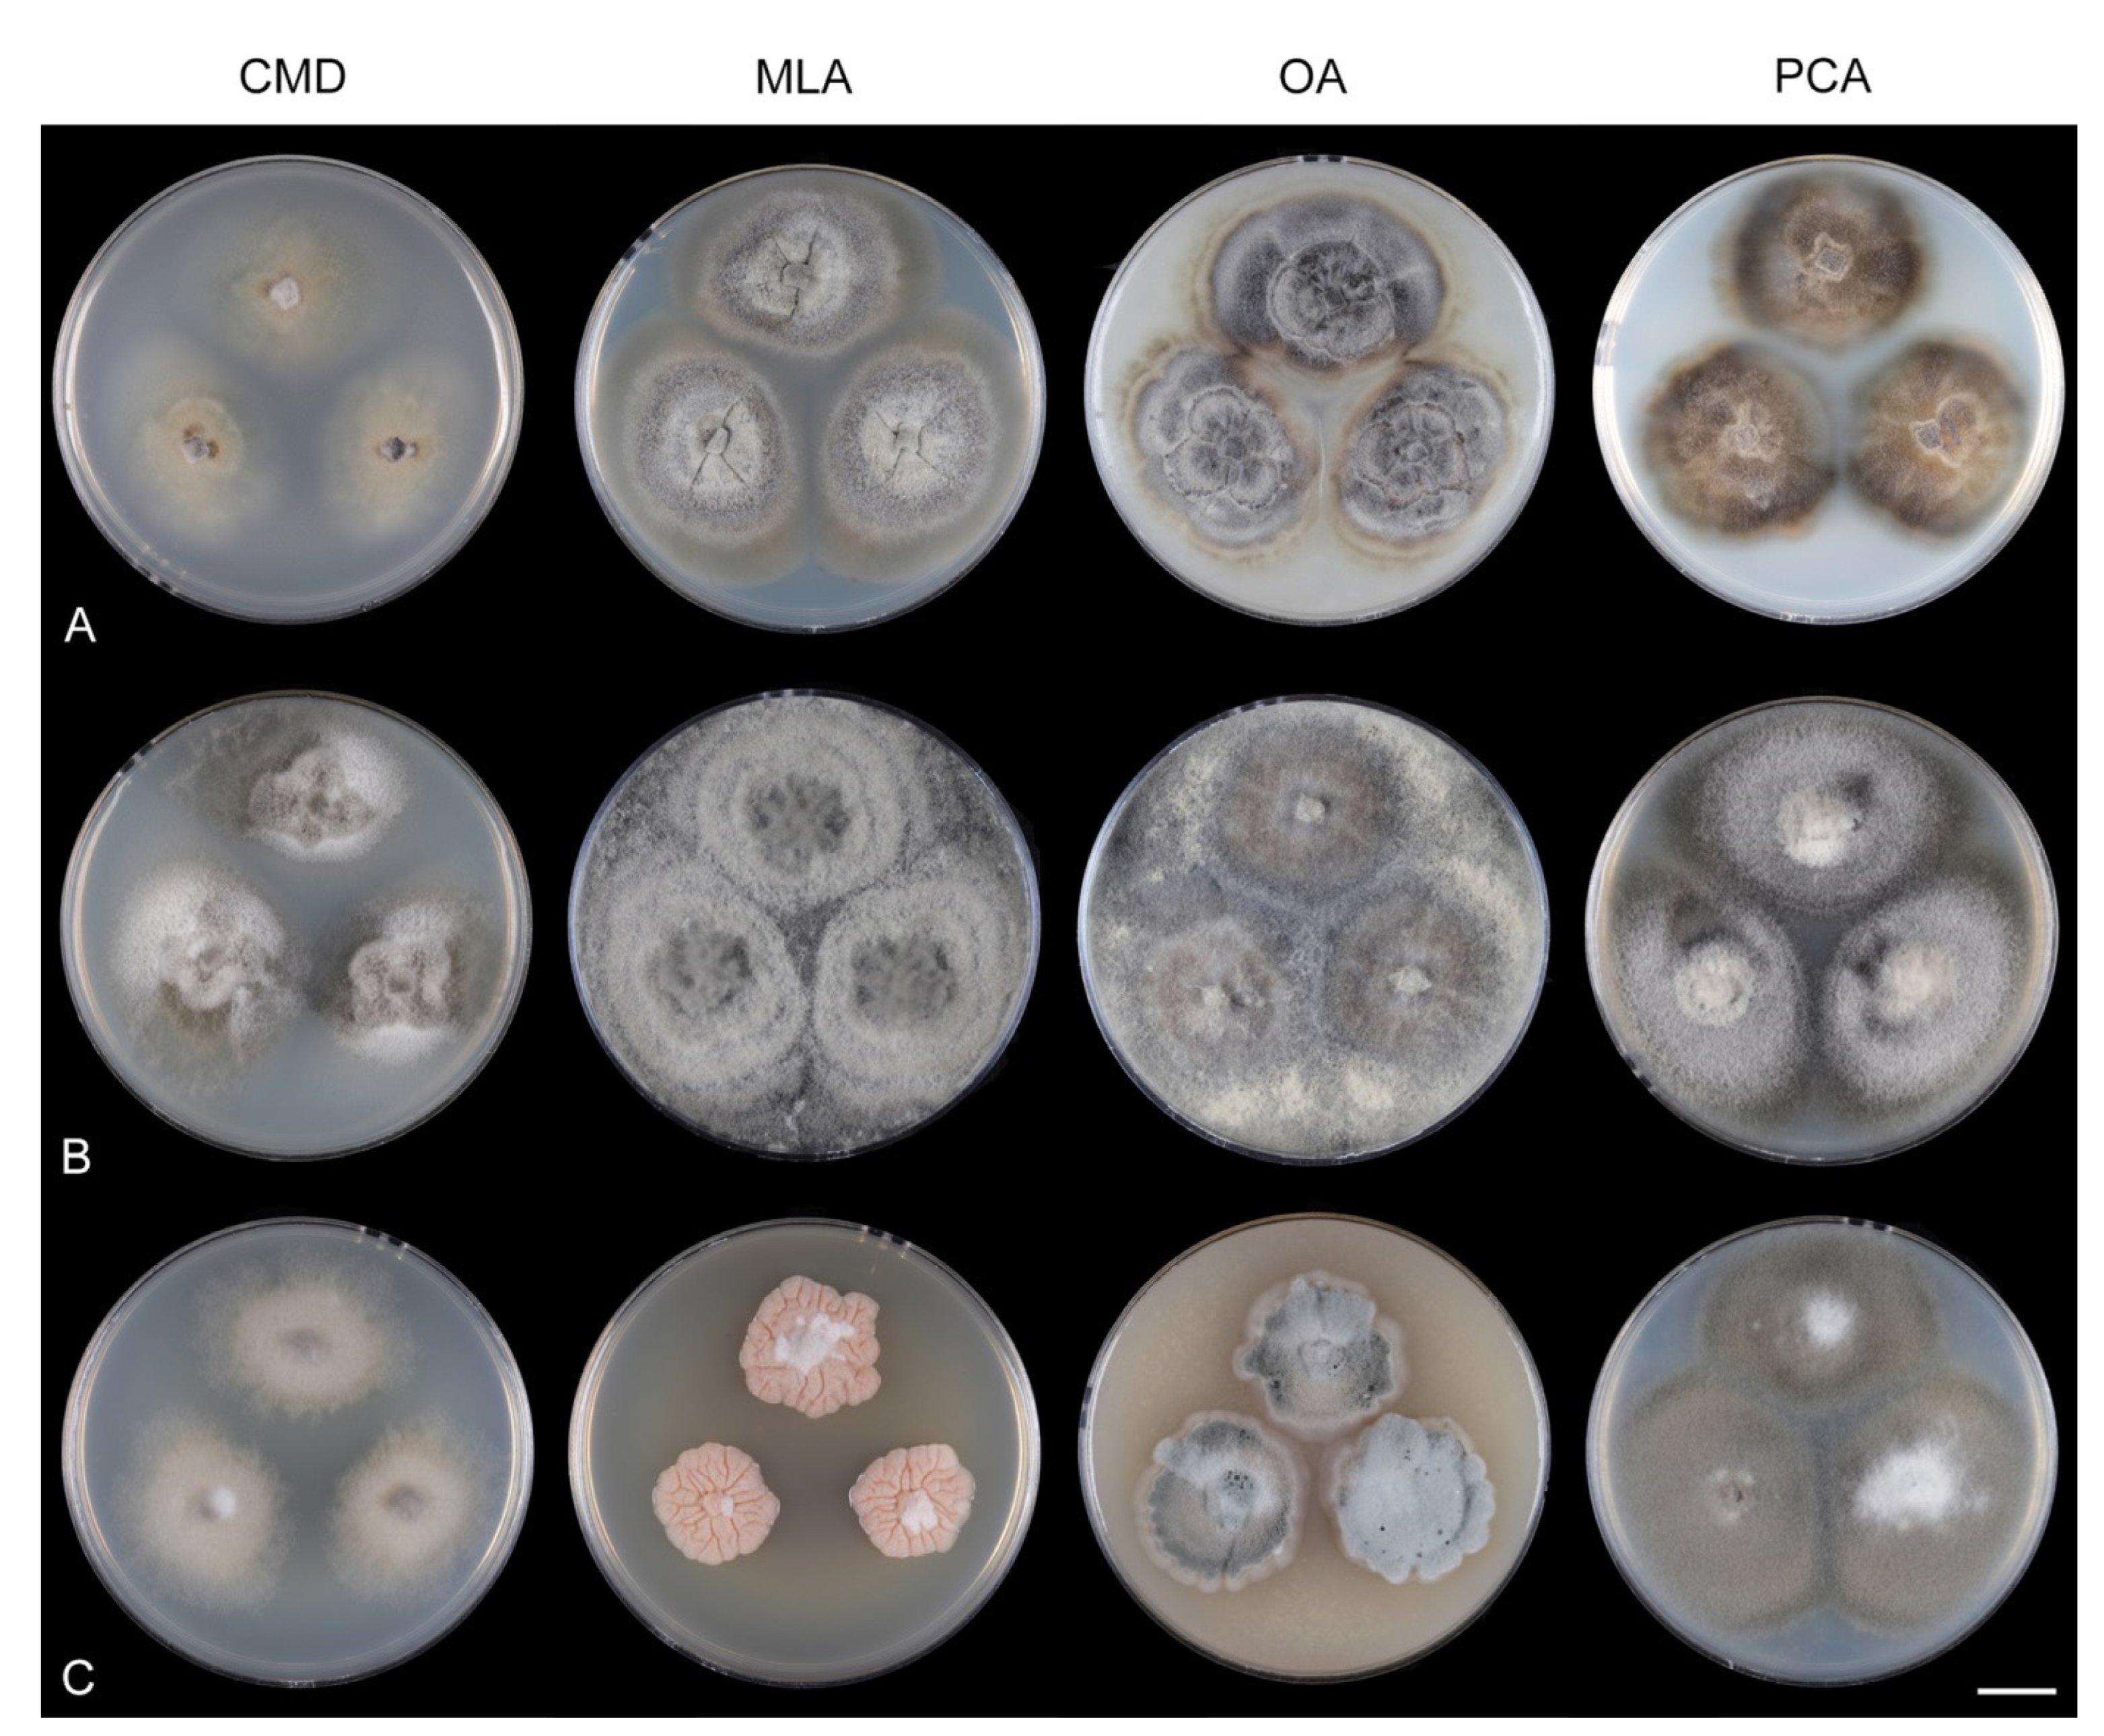
Jof 07 01097 g011 Jof 07 01097 g011

Abstract
The genus Codinaea is a phialidic, dematiaceous hyphomycete known for its intriguing morphology and turbulent taxonomic history. This polyphasic study represents a new, comprehensive view on the taxonomy, systematics, and biogeography of Codinaea and its relatives. Phylogenetic analyses of three nuclear loci confirmed that Codinaea is polyphyletic. The generic concept was emended; it includes four morphotypes that contribute to its morphological complexity. Ancestral inference showed that the evolution of some traits is correlated and that these traits previously used to delimit taxa at the generic level occur in species that were shown to be congeneric. Five lineages of Codinaea-like fungi were recognized and introduced as new genera: Codinaeella, Nimesporella, Stilbochaeta, Tainosphaeriella, and Xyladelphia. Dual DNA barcoding facilitated identification at the species level. Codinaea and its segregates thrive on decaying plants, rarely occurring as endophytes or plant pathogens. Environmental ITS sequences indicate that they are common in bulk soil. The geographic distribution found using GlobalFungi database was consistent with known data. Most species are distributed in either the Holarctic realm or tropical geographic regions. The ancestral climatic zone was temperate, followed by transitions to the tropics; these fungi evolved primarily in Eurasia and Americas, with subsequent transitions to Africa and Australasia.
1. Introduction
The genus Codinaea [1] is a phialidic dematiaceous hyphomycete and although it was originally clearly defined, its taxonomy has undergone many changes over the years. The genus name was created by Maire [1] as a tribute to his good friend Joaquim Codina i Vinyes, a Catalan physician and mycologist. Codinaea was introduced for a single species, C. aristata, occurring on a decaying stem of Rubus sp. lying on the ground in Spain. According to the original description and illustration, it was characterized by colonies composed of sterile, thick-walled, dark brown, several-septate setae accompanied by shorter, simple, pale brown conidiophores arising with these setae in tufts, terminal phialidic conidiogenous cells abruptly contracted at the apex (indicating the presence of a flared collarette) and hyaline, falcate, aseptate conidia with an indistinct basal scar and a simple setula at both ends (Figure 1). Codinaea aristata has since become a taxonomic enigma. This species has not been recorded in the literature since its description. The holotype material could not be traced [2], and neither living cultures nor molecular data are available. Hughes and Kendrick [2] examined the holotype of Menisporella assamica, the type species of Menisporella [3], originating from India; they concluded that this species is congeneric with Codinaea and transferred the genus to its synonymy.

Figure 1.
Illustration of a seta, conidiophores, and conidia of Codinaea aristata (holotype, Maire 1937).
To date, the genus Codinaea is composed of 55 species [4] with a worldwide distribution. In addition to the morphotype of C. aristata, other morphological characteristics were consequently included, leading to the expansion of the generic concept and the acceptance of species with extralimital morphotypes. Some admitted species lacked setae or setae were present but grew separately among the conidiophores; some species had discrete conidiogenous cells, either lateral on the conidiophore and stalks or on collar-like and nodose hyphae, sometimes conidiophores branched or were synnematous, and the conidia contained septa and sometimes lacked setulae e.g., [2,5,6,7,8,9,10].
The genus Dictyochaeta [11,12], typified by D. fuegiana, comprises fungi very similar to Codinaea in habitat and morphology, but differs mainly in the conidia without setulae, which are more distinctly asymmetrical, and in the arrangement of setae and conidiophores. Arambarri and Cabello [13] proposed a solution to stabilize the generic concept of Codinaea by reducing it to synonymy with the rival genus Dictyochaeta. They based their study on a numerical taxonomic analysis of 114 species belonging to 13 genera and a set of 28 characters to which they assigned different weights. Arambarri and Cabello [13] emphasized the importance of characters of the conidiophores including their branching pattern, shape of conidiogenous cells, and their position on the conidiophore, whereas the characters of the conidia (septation, symmetry, presence or absence of setulae) and collarettes were down weighed. The morphological similarity between Codinaea and Dictyochaeta, the multitude of morphotypes that have been associated with them over time, and the lack of knowledge of the phylogenetic significance of some taxonomic characters used in the classification of hyphomycetes have led to a preference for using the broad generic concept of Dictyochaeta. Kuthubutheen and Nawawi [14] questioned the mass transfer of Codinaea names to Dictyochaeta proposed by Arambarri and Cabello [13] without resolving the ambiguity regarding the teleomorphs, which would further complicate the taxonomic status of this already problematic conglomeration. They provided a key to species to distinguish between Codinaea and Dictyochaeta and proposed four morphological groups of species based on characters of conidia. Réblová and Winka [15] suggested that species with and without setulae should be kept in two separate genera, Codinaea and Dictyochaeta. This opinion, followed by Seifert et al. [16], was based on phylogenetic analysis of ribosomal DNA of a limited number of representatives of the Chaetosphaeriaceae.
A total of 116 species [4] have been accommodated in Dictyochaeta so far. The taxonomic studies of these fungi have relied mainly on morphological criteria, and until recently species of Dictyochaeta have rarely been studied using molecular data. In addition, the studies have been hampered by the lack of living cultures and ex-type strains. The first insights into the taxonomy and diversity of Dictyochaeta (including Codinaea) were provided mainly by Hughes and Kendrick [2], Matsushima [5,17,18], and Kuthubutheen and Nawawi e.g., [14,19,20,21,22,23,24,25]. Hughes and Kendrick [2] made a significant contribution to the taxonomy of this group, demonstrating a rich representation of species native to temperate and subtropical regions of New Zealand. Species described by Matsushima, largely studied in culture, come from various parts of East and Southeast Asia, such as Guadalcanal, Japan, Papua New Guinea, and the Republic of China (Taiwan). Kuthubutheen and Nawawi e.g., [14,19,20,21,22,23,24,25] investigated Dictyochaeta in Malaysia, often on submerged plant remnants; they also frequently isolated species in axenic cultures and published their observations in a series of papers in the 1990s. Other authors e.g., [6,26,27] presented a rich diversity of Dictyochaeta from the temperate zone of Europe and North America. Recently, several new species were described from China and Thailand e.g., [28,29,30]. Other, mostly single records, originate from different parts of the world e.g., [31,32,33,34,35,36,37,38].
The morphological heterogeneity of Dictyochaeta, which has been used as an umbrella name for similar fungi for more than three decades, has been addressed several times. Species with branched conidiophores and lateral phialides were the first to be excluded and segregated into new genera. The existence of extralimital and intermediary species that share features partly of Chloridium [39], Codinaea, Dictyochaeta, Gonytrichum [40], and Menispora [41], causing the morphology-based generic concept of Dictyochaeta to become unsustainable, led to the description of genera such as Codinaeopsis [42] and Dictyochaetopsis [43]. Morgan-Jones [42] introduced Codinaeopsis for Codinaea gonytrichodes [6], an intermediate species that is similar to Gonytrichum in terms of lateral phialides and branches arising from the collar hyphae. Later, the significance of taxonomic characters of C. gonytrichodes was re-evaluated and the species was combined in Dictyochaeta [21] and Dictyochaetopsis [44]. Following the practice of emphasizing conidiophore and phialide characters over conidial characters at the generic level, Arambarri and Cabello [43] proposed the genus Dictyochaetopsis for species of Dictyochaeta with branched conidiophores and lateral phialides, however, they accepted species with septate and aseptate conidia with and without setulae. Samuels and Müller [45] described Striatosphaeria for ascomycetes with dark brown, furrowed ascospores, unitunicate asci, and perithecial ascomata producing a Codinaea-like state in vitro with brown, septate, ellipsoidal-fusiform conidia that were later discovered to form setulae at each end [46].
Recent phylogenetic studies have provided the first DNA sequence data for this group of fungi and demonstrated polyphyly of Dictyochaeta e.g., [12,28,29,30,46,47,48,49]. Lin et al. [30] presented an overview of the Chaetosphaeriaceae and applied the name Dictyochaeta to five monophyletic clades. Réblová et al. [12] revised the concept of Dictyochaeta and showed that the core of the genus is only a small part of a large species complex. Dictyochaeta was circumscribed as a monophyletic, morphologically well-defined genus of the Chaetosphaeriaceae. Using morphological and molecular characters, several genera were separated from Codinaea and Dictyochaeta, such as Achrochaeta [12], Multiguttulispora [30], Phialolunulospora [50], and Tubulicolla [12]. Réblová et al. [49] provided phylogenetic evidence that Dictyochaeta dimorpha [51] and D. triseptata [18] are congeneric with Multiguttulispora sympodialis [30], the type species of the genus, and reduced the later species to synonymy of M. dimorpha. In addition, Striatosphaeria with the Codinaea-like anamorph was confirmed as a separate genus, distantly related to other Codinaea species with setulae [15].
The fungi that remain classified in Codinaea and Dictyochaeta are dematiaceous phialidic hyphomycetes that, based on literature and herbarium records, are globally distributed in major centers of diversity in Australasia, Holarctic realm, and the tropics, and thrive on decaying plant material such as bark, wood, wooden fruits, bamboo culms, palm fronds, fallen leaves and petioles in freshwater and terrestrial environments e.g., [2,5,6,20,21,22,23,24,25,26,27,28,29,30,31,32,33,34,35,36,37,38,52]. They also occur as endophytes in living plants e.g., [53], or plant pathogens [54,55,56]. Seldom, they have been linked with their sexual counterparts classified in the genus Chaetosphaeria [2,57].
Although recent molecular studies of members of Codinaea and Dictyochaeta have improved our understanding of this heterogeneous assemblage, the systematic placement of most of their representatives remains unexplored. The unknown placement of C. aristata, presumably in one of the five Dictyochaeta clades in the Chaetosphaeriaceae [30], remains a pressing issue. Therefore, we studied a large set of strains including all available ex-type strains of Codinaea and similar fungi. Based on our preliminary multilocus analysis, these taxa formed several monophyletic groups that seem to correlate with morphological data. The present study aims to clarify the delimitation of Codinaea, its relationship with Dictyochaeta and other unnamed clades containing Codinaea-like and Dictyochaeta-like fungi using phylogenetic analyses for three ribosomal and protein-coding loci combined with morphological and RNA structural data and data on geographic range. We evaluate their intraspecific and interspecific relationships and the diagnostic value of taxonomic characters used in the classification of these fungi. The performance of used loci as barcoding markers is evaluated. We also attempt to assess their global geographic distribution and ecology. To date, research on geographical distribution of fungi has relied on traditional approaches (i.e., field sampling, cultivation) and public nucleotide sequences databases, such as NCBI GenBank [58] and UNITE [59]. However, most of the barcode sequences generated to date have come from massively parallel sequencing technologies. The data have been stored in various public repositories, which does not allow easy retrieval of data from multiple studies. This gap has been filled by creating the GlobalFungi ITS barcode database [60,61], an important tool for studying fungi, especially those that are poorly known due to their slow growth and rarity. In this context, our research is a pioneering study evaluating the applicability of the GlobalFungi database in exploring geographic distribution at a fine species level scale. In addition, we perform reconstruction of ancestral states of morphological characters and ancestral climate zones and areas of species distribution of Codinaea and similar fungi.
2. Materials and Methods
2.1. Fungal Strains and Morphology
Material for this study was collected in the temperate regions in the Northern and Southern Hemispheres in lowland and mountain forests in Europe (Czech Republic, France and The Netherlands), North America (USA), New Zealand, and in the tropical region in the evergreen rainforest in Puerto Rico. Other specimens were obtained from the Canadian National Mycological Herbarium, Ottawa, Canada (DAOM) and the Kew herbarium, Kew, United Kingdom (K and IMI). Type material designated in this study and other specimens, as dried voucher specimens and dried cultures, were deposited at Herbarium of the Institute of Botany, Průhonice, Czech Republic (PRA), New Zealand Fungarium, Auckland, New Zealand (PDD) and Westerdijk Fungal Biodiversity Institute, Utrecht, The Netherlands (CBS). Axenic cultures were derived from freshly collected specimens and deposited at CBS and the International Collection of Microorganisms from Plants, Auckland, New Zealand (ICMP). Other living strains were obtained from American Type Culture Collection, Rockville, Maryland, USA (ATCC), BCCM/MUCL Agro-food & Environmental Fungal Collection, Louvain, Belgium (MUCL), CABI-IMI Culture Collection, Egham, United Kingdom (IMI), CBS, ICMP, and Texas Therapeutics Institute, Houston, Texas, USA (TTI). Fungal novelties were registered in MycoBank.
The descriptions of fungi given in this study are based on morphological characters obtained from our observations on natural substrates and in culture. Fresh and herbarium material were examined with an Olympus SZX12 dissecting microscope (Olympus America, Inc., Melville, NY, USA); ascomata, conidiophores and conidia were rehydrated with tap water. Microscopic preparations containing sections of ascomatal wall, asci, ascospores, paraphyses, conidiophores with conidiogenous cells and conidia were mounted in 90% lactic acid, water or Melzer’s reagent. Measurements were taken in Melzer’s reagent. Means ± standard deviation (SD) based on a minimum of 20–25 measurements were given for sizes of asci, ascospores, and conidia. Microscopic observations were performed using an Olympus BX51 compound microscope with differential interference contrast (DIC) and phase-contrast (PC) illumination. An Olympus DP70 camera operated by Imaging Software Cell^D (Olympus) was used to capture images. Macroscopic images of colonies were documented using a Canon EOS 77D digital camera with Canon EF 100 mm f/2.8 L Macro IS USM objective (Canon Europe Ltd., Middlesex, UK) with daylight spectrum 5500 K 16 W LED lights. All images were processed with Adobe Photoshop CS6 (Adobe Systems, San Jose, CA, USA).
Fungi from fresh collections were isolated into axenic cultures. Slimy conidial masses and the content of ascomata were removed with the tip of a sterile needle and placed on water agar (WA) (1000 mL distilled water, agar 10 g, Oxoid Limited, Hampshire, UK) and incubated for 2–5 days. Germinating spores were transferred to a new medium, i.e., single and multiple ascospore and conidial isolates were obtained with the aid of a single-spore isolator (Meopta, Přerov, Czech Republic) and incubated on WA or Modified Leonian’s agar (MLA) [62] at a temperature of 20–25 °C. Species were cultured on several different nutrient media for observation of microscopic characters, comparison of colony characters, and evaluation of pigment production and growth optimum. Fungi were inoculated on cornmeal dextrose agar (CMD) (Oxoid Limited; 2% dextrose), MLA, oatmeal agar (OA) and potato-carrot agar (PCA) [63]. Characteristics of colonies were based on 4-week-old cultures grown in darkness at 22–23 °C. Strains were also inoculated on cornmeal agar (CMA) with sterile stems of Urtica dioica and synthetic nutrient agar (SNA) with pine needles [63] to induce sporulation and growth of setae.
2.2. DNA Extraction, PCR Amplification, and Sequencing
Total genomic DNA was extracted from mycelium removed from 3–4-week-old cultures grown on MLA using the DNeasy® UltraClean® Microbial Kit (Qiagen GmbH, Hilden, Germany) following the manufacturer’s protocol for filamentous fungi. PCR amplifications were carried out in 25 μL volume reactions using a Q5 High Fidelity DNA polymerase kit (New England Biolabs Inc., Hitchin, UK) according to the manufacturer’s protocol.
Three regions were amplified with the following primers: V9G/LR8 primer pair [64,65] was used for the internal transcribed spacer (ITS1-5.8S-ITS2) (ITS) of the nuclear rRNA cistron and the nuclear large subunit 28S rDNA gene (28S) (approximately the first half, 1800 base pairs at the 5′-end), and EF1-983F/EF1-2218R [66] for the intermediate section of the coding region of the translation elongation factor 1-alpha (tef1-α).
PCR was carried out in a BioRad C1000 thermal cycler (Bio-Rad Laboratories Inc., Hercules, CA, USA) as follows: (ITS-28S) 98 °C for 30 s; 40 cycles of denaturation (98 °C for 10 s), annealing (62 °C for 30 s) and elongation (72 °C for 90 s) and a final extension step at 72 °C for 5 min; (tef1-α) 98 °C for 30 s; 40 cycles of denaturation (98 °C for 10 s), annealing (57 °C for 10 s) and elongation (72 °C for 60 s) and a final extension step at 72 °C for 2 min. Amplicons were purified from agarose gels using a NucleoSpin® Gel and PCR Clean-up Kit (Macherey-Nagel GmbH & Co. KG, Düren, Germany) following the manufacturer’s instructions, with an elution volume of 25 μL. The DNA concentration was assessed fluorimetrically using Quant-iTTM PicoGreenTM dsDNA Assay Kit and Qubit fluorometer (Invitrogen/Thermo Fisher Scientific Inc., Waltham, MA, USA) to assure the required sequencing concentrations adjusted for the length of amplicons/number of reads required.
The obtained amplicons were sequenced in both directions using the PCR and nested primers ITS5, ITS4, JS1, JS7, JS8, and LR7 [65,67,68,69]. Automated sequencing was carried out by Eurofins GATC Biotech Sequencing Service (Cologne, Germany), the Roy J. Carver Biotechnology Center at the University of Illinois Urbana-Champaign (Champaign, IL, USA), and Westerdijk Fungal Biodiversity Institute (Utrecht, The Netherlands). Raw sequence data were analyzed using Sequencher v.5.4.6 (Gene Codes Corp., Ann Arbor, MI, USA).
2.3. Gene Markers, Alignments and Phylogenetic Analyses
Representatives of the Chaetosphaeriaceae have traditionally been studied using ITS and 28S and more recently also tef1-α markers. The same loci were analyzed in the present study. Strains, their sources, and the GenBank accession numbers of sequences of ITS, 28S and tef1-α determined in this study are listed in Table 1. Accession numbers for sequences retrieved from GenBank and published in other studies [12,15,28,29,30,47,48,49,50,70,71,72,73,74,75,76,77,78,79,80,81,82,83,84,85,86] are listed in Table 1 and the Supplementary File: Table S1.

Table 1.
Taxa, isolate information, and GenBank accession numbers for sequences. New sequences determined for this study and taxonomic novelties are given in bold face.
Sequences were aligned in Mafft v.7.487 [87] implemented in the CIPRES Science Gateway v.3.3 [88,89] and manually corrected in Bioedit v.7.1.8 [90], if necessary. Consensus secondary structure (2D) models for the ITS1 and ITS2 of Codinaea and related fungi and other members of the Chaetosphaeriaceae (see Section 2.4.) were used to improve the alignment by comparing nucleotides at homologous positions (in helices and loops). A predicted 2D model of the 28S of Saccharomyces cerevisiae [91] was used to improve the alignment of this gene. The three individual datasets, for which we assumed rate heterogeneity, were evaluated using MrModeltest v.2.4 [92] to find the best partitioning scheme and to select best-fit models under Akaike information criteria. The GTR+I+G model was selected for all partitions. The concatenated dataset of three loci (ITS, 28S and tef1-α) contained 181 sequences. The final alignment (deposited in TreeBASE 29053) was subjected to phylogenetic analysis. It consisted of 3424 characters including gaps (ITS = 640 characters; 28S = 1784; tef1-α = 1000) and 1682 unique character sites (RAxML). We analyzed the entire dataset with the exception of 90 nucleotides (nt) at the 5′-end of 28S, because most sequences retrieved from GenBank were incomplete. Tracylla aristata and T. eucalypti (Tracyllales) served as outgroup.
Phylogenetic reconstructions were performed using Bayesian Inference (BI) and Maximum Likelihood (ML) analyses through the CIPRES Science Gateway v.3.3. The ML analysis was conducted with RAxML-HPC v.8.2.12 [93] with a GTRCAT approximation. Nodal support was determined by non-parametric bootstrapping (BS) with 1000 replicates. BI analysis was performed in a likelihood framework as implemented in MrBayes v.3.2.7 [94]. Two Bayesian searches were performed using default parameters. The B-MCMCMC (Bayesian-Metropolis-coupled Markov chain Monte Carlo) analyses lasted until the average standard deviation of split frequencies was below 0.01 with trees saved every 1000 generations with burn-in 25%. The BI and ML phylogenetic trees were compared visually for topological conflict among supported clades.
For ITS and tef1-α markers, histograms of intraspecific and interspecies distances of Codinaea, Codinaeella, and Stilbochaeta were generated to illustrate the degree of overlap (i.e., barcoding gap) for both genes. Matrix of pairwise distances was computed with MEGAX [95] using the Kimura two parameters (K2P) model [96], and the histogram was plotted in GraphPrism software v.7.03 (Graphpad Software Inc., LaJolla, CA, USA) using a bin size of 0.001 and 0.0005 (only ITS data in Codinaeella). The estimates of evolutionary divergence between ITS rDNA and tef1-α sequences of members of Codinaea, Codinaeella, and Stilbochaeta are provided in the Supplementary File: Table S2.
2.4. Prediction of 2D Structure Models ITS2
Multiple sequence alignment of homologous RNA sequences can be improved using secondary (2D) structure information by comparing positions in helices and loops. We employed PPfold program v.3.0 [97], which uses an explicit evolutionary model and a probabilistic model of structures and takes as input multiple sequence alignment of related RNA sequences in order to build consensus ITS2 2D structure models. Final 2D models were adjusted with UNAfold web server [98,99] which employs mFold program [100] to improve the initial multiple sequence alignment of members of the Chaetosphaeriaceae. The 2D models were visualized using VARNA: Visualization Applet for RNA program [101]. We also employed CBC analyzer program [102], which calculates a number of CBC (Compensatory Base Change) changes for input sequences and their 2D structures.
2.5. Identification of Base-Pair Changes in 2D Structures of ITS
We performed an in-depth analysis of the ITS2 molecule of Codinaea and two newly proposed segregate genera Codinaeella and Stilbochaeta to further explore inter- and intraspecific variability of their species at the structural level. All three genera have good species representation and available DNA sequence data. The evolutionary processes at the RNA structural level, responsible for preserving the RNA helix structure (described below), are widely accepted as a basis for the CBC species concept used to delimit biological species [103,104,105,106,107,108].
There are three different types of substitutions in helixes. First event represents compensatory base change (CBC), which perfectly maintains 2D structure of helices, for instance G=C pair can change to C=G, A-U or U-A. These canonical base pairs (bp) are isosterical [109], i.e., they can be substituted for each other within stems without causing structural perturbations. Second event is hemi-compensatory base change (hCBC), where standard canonical pairs A-U and G=C change to near-isosteric “wobble pairs” G/U, A+/C (adenine is protonated in this pair), or vice versa. The wobble pairs are similar, retaining the base pairing in RNA molecules, but are not spatially identical to C=G, A-U, so they induce minor perturbation in the helix structure [109]. Third event is non-compensatory base change (non-CBC) that involves the replacement of a canonical pair or a wobble pair with any non-canonical pair and produces the largest structural perturbation into the helix structure. Incorporation of non-WC pairs (WC = standard Watson-Crick base pairs or canonical base pairs) into helix does not mean that helix structure disrupts, rather the tertiary structure of the helix is changed, which can subsequently modulate its function.
2.6. Ancestral State Reconstruction
Based on the groups that were determined in the current phylogenetic tree, we have selected 16 well-supported monophyletic lineages that represent Codinaea, its segregates and other morphologically similar taxa, and we have scored five characteristics traditionally used to separate hyphomycetous genera. Software package RASP v.4.2 [110] was used for the reconstruction of ancestral states of morphological characters and ancestral areas of species distribution. The phylogenetic trees used as input were calculated in MrBayes v.3.2.7 [94] using partitioned analysis of ITS, 28S, and tef1-α; suitable models of evolution for each locus were selected in jModelTest v.2.1.7 [111].
The reconstruction of morphological states was performed using Multistate function in Bayestraits with the following options: mcmc; number of iterations 5,050,000; sample 10,000; burn-in 50,000. We tested five morphological characters with the following states: I. Setae: (a) absent (b) isolated (c) in tufts with conidiophores; II. Conidiophores: (a) branched, with sterile extension (b) branched without sterile extension (c) unbranched, with sterile extension (d) unbranched without sterile extension; III. Phialides: (a) terminal, integrated, on main stalk or branches, discrete, lateral, sessile or on stalk (b) only terminal, integrated, on main stalk or branches (c) only discrete, lateral, sessile or on stalk; IV. Conidial features: (a) setulae and septa both present (b) setulae present, septa absent (c) setulae absent, septa present (d) setulae and septa both absent V. Conidial shape (a) falcate, lunate, narrowly fusiform, curved (b) other (ellipsoidal, ellipsoidal-fusiform, oblong, reniform, globose, pyriform, ellipsoidal, papillate, obovoid, ellipsoidal-clavate, cylindrical-clavate).
Bayesian Binary MCMC (Markov chain Monte Carlo) (BBM) method was used for the reconstruction of ancestral areas with the following settings: number of cycles 1,000,000; number of chains 10; frequent of samples 100; discard samples 100; temperature: 0.1; state frequencies: estimated (F81); maximum number of areas: 3. The analysis was split into two parts. In the first part, the distribution of species in climatic zones was tested. The species were split into three groups, the first one occurring only in tropical regions, the other in subtropical and temperate regions and the third group consisted of species occurring in all of these climate zones. In the second part, we classified the species into four geographic areas (Eurasia, Australasia, America, and Africa). The allocation of areas to species was based on published distribution of each species and also on information obtained from GlobalFungi database [60] using Sequence search (Exact hit) function.
2.7. Phylogeny of Environmental Sequences and Biogeography
The biogeographic analysis focused on Codinaea and two main segregate genera Codinaeella (Ca.) and Stilbochaeta, which are species rich with available ITS sequence data. Basically, we followed the workflow of Réblová et al. [86]. We used GlobalFungi database (dataset release 3), which contains 36,684 samples from 367 studies, 582,264,149 unique ITS1 and 526,638,147 unique ITS2 sequences. Because the GlobalFungi database contains separated ITS1 and ITS2 sequences, these two regions were analyzed separately. First, we determined the interspecies genetic distances for each ITS spacer. The detailed comparison of ITS sequences among individual species showed that for some species, only one of the ITS spacers is distinctive and that only the threshold of the full sequence identity should be used to link known species with metabarcoding data unequivocally. In ITS1, two species of Codinaeella, Ca. minuta and Ca. filamentosa, have identical sequences. The variability between Stilbochaeta aquatica and S. submersa and that between Ca. lambertiae and Ca. lutea was in a single position (similarity of 99.4%). For ITS2, all species can be differentiated; only one bp difference (99.4%) was found between Ca. lutea and Ca. yunnanensis, Ca. minuta and Ca. filamentosa differ in two positions (98.7%). Therefore, we subjected all ITS1 and ITS2 haplotypes from our study (Table 1) to BLASTn [112] similarity search in GlobalFungi with the 100% similarity threshold and rule of the full length sequence coverage. Because we found that ITS spacers deposited in GlobalFungi, originally extracted using ITSx extractor [113], do not always represent full-length sequences (usually 1–2 bp at the 5′ end of ITS2 are missing), we used ITS2 sequences trimmed accordingly. Sites were classified into climatic regions according to Köppen-Geiger [114] and plotted on map using Tableau Desktop v.2021.3 (Tableau Software, Seattle, WA, USA). Primary data about occurrence and respective metadata, e.g., location, substrate, biome, pH and climatic data such as the mean annual precipitation (MAP) and mean annual temperature (MAT) were obtained for each taxon from the GlobalFungi database (Supplementary File: Table S3).
3. Results
3.1. Phylogenetic and Barcode Analyses
Phylogenetic relationships were resolved based on the analysis of ITS, 28S, and tef1-α sequences of 179 strains of members of the Chaetosphaeriaceae. The phylogenetic trees generated by BI and ML analyses were largely congruent; the nodes with support values of ≥75% ML BS and ≥0.95 BI PP were considered well-supported. The ML tree is shown in Figure 2. The family Chaetosphaeriaceae included 57 well-supported lineages that represent genera or natural groups of species. Analyzed species of Codinaea, Codinaea-like, and Dictyochaeta-like fungi were resolved in eleven major groups. Codinaea is shown as a strongly supported clade (99 ML BS/1.0 BI PP); it contains 22 strains representing 13 species including the ex-type strains of Bahusutrabeeja dwaya CBS 261.77 and Phialolunulospora vermispora CGMCC 3.19632 and a non-type strain of Codinaeopsis gonytrichodes CBS 593.93; all three species are generic types. Several other species with setulate conidia formed two well-supported undescribed lineages introduced below as the new genera Codinaeella (99/1.0) including 26 strains of eight species and Stilbochaeta (94/1.0) with 15 strains representing eight species. A Codinaea-like species formed a separate lineage basal to Codinaea, although statistically unsupported in the ML analysis, and is proposed as a new species in the new genus Nimesporella. In addition, several other species with Codinaea-like and Dictyochaeta-like morphotypes clustered as distantly related lineages. The genera Dictyochaeta (100/1.0) and also Multiguttulispora (100/1.0), Striatosphaeria (100/1.0), and Tainosphaeria (100/1.0) containing former Codinaea and Dictyochaeta species were resolved as strongly supported clades. The ex-type strains of two Tainosphaeria species, T. aquatica MFLUCC 17-2370 and T. thailandensis MFLUCC 18-1282, formed a strongly supported lineage (99/1.0). Their relationship with the type species of Tainosphaeria, T. crassiparies, was not confirmed. Specifically, they nested as a sister to Phialogeniculata guadalcanalensis in a statistically unsupported clade containing several other genera, such as Anacacumisporium (100/1.0), Flectospora (92/1.0), and Phialoturbella (93/1.0). Therefore, a new genus Tainosphaeriella is proposed for the lineage of the two former Tainosphaeria species. Two non-type strains of Chaetosphaeria longiseta S.M.H. 1725 and S.M.H. 3854 and the ex-type strain of Dictyochaeta brevis GZCC 18-0096 grouped as sister clades in a well-supported lineage (100/1.0) near the base of the tree. Their taxonomic treatment is proposed below.



Figure 2.
(A) Phylogenetic tree based on the combined ITS-28S-tef1-α rDNA sequences constructed by maximum likelihood (RAxML) of members of the Chaetosphaeriaceae. Species names given in bold and placed in green boxes are taxonomic novelties. Each novelty is accompanied by a respective morphotype(s); their distribution within the genus is indicated by circles of different colors. Codinaea: morphotypes C1 (dark violet), C2 (fuchsia), C3 (lila), C4 (pink); Codinaeella: morphotypes CA1 (yellow), CA2 (burgundy). The clade containing Dictyochaeta s. str. is placed in a violet box. Abbreviations T, E, I, N, and P indicate ex-type, ex-epitype, ex-isotype, ex-neotype and ex-paratype strains; letters in the upper case after a species name indicate: (a) holotype of Chaetosphaeria trianguloconidia, (b) ex-type strain of Codinaea acaciae, (c) ex-type strain of Chaetosphaeria ciliata, (d) ex-type strain of Dictyochaeta curvispora (contamination), (e) ex-type strain of Tainosphaeria obclavata. Thickened branches indicate branch support with ML BS = 100% and PP values = 1.0. Branch support of nodes ≥ 75% ML and ≥0.95 PP is indicated above or below branches. (B,C) Phylogenetic trees based on the combined ITS-28S-tef1-α rDNA sequences of the Chaetosphaeriaceae (continued). For legend refer to (A). Abbreviation: p.p. after a genus name (pro parte).
For two markers tested (ITS and tef1-α), the barcoding gap separated intraspecific from interspecific variation in all species (Figure 3). However, the length of the barcoding gap ranged between genera and markers. For the ITS, the barcoding gap was rather narrow, i.e., Codinaea 0.4–0.8%, Codinaeella 0.2–0.4%, and Stilbochaeta 0.6–1.3%. On the other hand, the tef1-α marker showed a large gap between intraspecific and interspecific variability, i.e., Codinaea: 0.7–2.4%, Codinaeella: 1.5–2.1%, and Stilbochaeta: 0.1–1.0%. The lowest interspecific divergence for ITS ranged from 0.4% (Ca. filamentosa vs. Ca. minuta) and 0.8% (C. pandanicola vs. C. siamensis) to 1.3% (S. malaysiana vs. S. ramulosetula), while the highest ranged from 8.2% (Ca. parvilobata vs. Ca. pini) and 12% (C. ellipsoidea vs. C. phasma) to 13% (S. aquatica vs. S. brevisetula). For the tef1-α gene, the lowest interspecific divergence ranged from 1.0% (S. malaysiana vs. S. ramulosetula) and 2.1% (Ca. lutea vs. Ca. yunnanensis) to 2.4% (C. assamica vs. C. siamensis) and the highest from 7% (Ca. mimusopis vs. Ca. pini) to 8.1% (C. amazonensis vs. C. dwaya) and 8.5% (S. brevisetula vs. S. septata). Based on these results, the markers ITS and tef1-α are recommended as barcodes for Codinaea, Codinaeella, and Stilbochaeta.

Figure 3.
The frequency distribution graphs of the Kimura 2-parameter distances of ITS and tef1-α DNA sequences (barcoding gaps). (A) Codinaea; (B) Codinaeella; (C) Stilbochaeta. The intraspecific distances are shown as blue bars and interspecific distances as grey bars. The bin size of 0.001 and 0.0005 (only ITS, Codinaeella) were used.
3.2. Consensus 2D Structure of ITS2
The CBC species concept is based on the co-evolution of nucleotides involved in CBCs and hCBCs in the two most conserved helices H2 and H3 [103] and also the H1 helix [108] of the ITS2 molecule. The 2D consensus structure models for Codinaea (mapped onto C. assamica, Figure 4), Codinaeella (mapped onto Ca. minuta, Figure 5A), and Stilbochaeta (mapped onto S. malaysiana, Figure 5B) were created. Once all existing substitutions were identified, they were mapped onto the predicted 2D structure models of ITS2 of the three genera. In particular, we focused on CBC substitutions in the ITS2 molecule, which are significant for detecting species that are sexually incompatible. The ITS2 has a common core structure in all three genera; the secondary structure folds into a ring structure with three main helices (H1–H3), while helix H4 is missing due to large variability. Base changes were detected only in H2 (except for Codinaea) and H3. The H1 is a short, conserved helix consisting of five base pairs (in all three structures) with a variable 3 nt hairpin loop. The H2 is a nine base pairs long helix with one bulge in the middle of the duplex and a variable 3–5 nt hairpin loop. In Stilbochaeta, we detected five base changes, three of them were different hCBCs and two were CBCs, both between S. brevisetula and other species of the genus. Only one hCBC change was observed in Codinaeella. The H3 is the largest duplex (length 66–68 nt) with a number of base pair changes. All three models consistently contained one CBC substitution but various numbers of hCBC and non-CBC changes. Specifically, we observed one CBC in C. phasma (against other species of the genus), and four hCBCs and two non-CBC changes in Codinaea. More events were detected in Codinaeella, in particular one CBC between Ca. parvilobata and other species, 15 different hCBCs, and three non-CBC changes. Substitutions identified are Stilbochaeta included one CBC in S. aquatica and two in S. brevisetula against other species of the genus, but also 11 different hCBCs among species and two combined base changes (non-CBS and hCBC) in S. cangshanensis and S. septata on both sides of the asymmetric loop of the duplex. Primary sequence variations among other species of Codinaea, Codinaeella, and Stilbochaeta were low and included single mutations in hairpin loops of helices H1, H2, and H3, in the junction areas between helices and also in the helices.

Figure 4.
ITS2 secondary structure of Codinaea assamica CBS 139907 and 5.8S-28S rRNA gene hybridization (proximal stem region) (GenBank accessions ITS: OL654077, 28S: OL654134). ITS2 helices are numbered I–III. All substitutions recorded among members of Codinaea are mapped on the 2D model. Identified substitutions are color-coded: CBC (green), hCBC (blue), and non-CBC (red). Parts of the text in green frames refer to CBCs, parts of the text in blue and red refer to hCBCs and non-CBCs, respectively. Hairpin loops and other parts of the ITS2 molecule highlighted with grey color represent regions with a variable number of nucleotides or sequence variation; positions highlighted with a pink color represent single mutations.

Figure 5.
ITS2 secondary structure of Codinaeella and Stilbochaeta and 5.8S-28S rRNA gene hybridization (proximal stem region). (A) Codinaeella minuta CBS 146620 (GenBank accessions ITS: OL654095, 28S: OL654152) (B) Stilbochaeta malaysiana IMI 312436 (GenBank accessions ITS: OL654121, 28S: OL654178). Details as in Figure 4.
3.3. Ancestral State Reconstruction
Our analysis showed that the ancestral state of setae type (Figure 6A, node I) was the presence of all states (setae absent, present, tufts) and only the genus Menispora still retained this ancestral polymorphism. In other lineages, we can see the evolution to the particular morphological type, where setae occurred solitarily (Codinaeella and Dictyochaeta), in tufts (Codinaea, Stilbochaeta), or were lost (genera evolving from the node IV and Multiguttulispora). In the conidiophore type evolution, we can see the trend from the simple types, such as unbranched conidiophore without (Figure 6B, node I) and with sterile extension (node II) toward the more complex conidiophore types occurring rarely in Codinaea and Codinaeella. Again, Menispora showed the diversity of all conidiophore types. Similar to setae evolution, the analysis showed that the evolution of the phialide position started with all states (Figure 6C, node I). During the evolution, the presence of the terminal phialide became the probable ancestral state (node II) and this character occurs in most of the lineages. Other types occur randomly and rarely in Codinaea, Codinaeella, and Menispora. During conidia evolution, the simplest type (no setulae, no septa) was ancestral (Figure 6D, node I) but more complex conidia types (with setulae and septa) subsequently evolved in several lineages (Stilbochaeta, Multiguttulispora, Tainosphaeriella). Concerning conidia type evolution, the most common type was conidia with setulae but without septa. Menispora showed the diversity of all conidia types (Figure 6D). The evolution of the conidia shape started from elongated types (falcate, lunate, narrowly fusiform, curved) to broader conidial shapes (ellipsoidal, ellipsoidal-fusiform, oblong, reniform, globose, pyriform, papillate, obovoid, ellipsoidal-clavate, cylindrical-clavate) (Supplementary File: Figure S1).

Figure 6.
Reconstruction of ancestral states and areas in Rasp v.4.2 using phylogenetic trees calculated in MrBayes v.3.2.7. (A–D) Reconstruction of morphological characters using Multistate function in Bayestraits (E,F) ancestral areas reconstruction of species distribution using Bayesian Binary MCMC (BBM) method.
Reconstruction of the ancestral climatic zone revealed the temperate zone as the ancestral area (Figure 6E, nodes I and II) with the subsequent transition to the tropical zones. This transition occurred independently in five lineages and seems to be irreversible. Most lineages showed a clear preference to the particular climatic zone. The reconstruction of the ancestral geographical distribution showed Eurasia (Figure 6F, node I) or Eurasia and Americas (nodes II and IV) as ancestral and the presence in African and Australasian areas as derived. Most of the clades showed broader geographical distribution and only a few lineages are more or less restricted to other areas such as Eurasia (lineages of Flectospora, Phialoturbella, Phialogeniculata, and Tainosphaeriella) or Americas (Striatosphaeria).
3.4. Diversity Analysis of Codinaea and Related Fungi in Environmental Samples, Biogeography, and Ecology
The datamining resulted in 185,176 reads that can be assigned to excerpted species of Codinaea, Codinaeella, and Stilbochaeta. Several species were not found in GlobalFungi database, such as C. dwaya, C. ellipsoidea, C. vermispora, Ca. mimusopis, S. brevisetula, and S. submersa, and can be considered rare or highly geographically restricted. In average, each species was found in 57 samples (min. one sample, max. 655). Most of the samples originate from bulk soil (65% of all samples), followed by roots (16%), rhizosphere soil (11%), shoots (3.5%), litter (2.4%), and other substrates. Majority of samples were collected in forests (55%), croplands (19%), and grasslands (17%) followed by other biomes. If we consider the density of sampling across various world regions, we can draw several well supported conclusions (Figure 7, Supplementary Files: Figure S2, Table S2).

Figure 7.
Geographical distribution of (A) Codinaea, (B) Codinaeella, and (C) Stilbochaeta species based on the GlobalFungi database. See Table S2 for primary data. Species are differentiated by colors. (D) The circles represent smaller geographical areas with one or more observations of the particular species. Some of the smaller areas contained observations of multiple species (e.g., Caspian coast, Puerto Rico); circles were manually dispersed over the actual collection site. Scale bar: 2000 km.
Basically, the species distribution followed mainly the climatic zones and can be classified into the three distribution types: (1) tropical climate, i.e., C. amazonensis, C. pandanicola, C. phasma, C. siamensis, C. terminalis, S. novae-guineensis, S. malaysiana, and S. ramulosetula; (2) temperate, and/or in cold humid or continental humid climates, i.e., the whole genus Codinaeella, also C. lignicola, C. paniculata, S. aquatica, and S. cangshanensis; (3) usually distributed across temperate, tropical, or colder and drier climates, i.e., C. assamica and C. fertilis. With a few exceptions (Ca. lutea, Ca. pini), these taxa are almost absent in the well sampled areas of western part of North America. The distribution of members of Codinaea, Codinaeella, and Stilbochaeta never reaches boreal climatic zone and the northern limit of their distribution is southern Sweden, Wales (UK), and US/Canada border. Ninety-six per cent of the samples were collected from sites with MAT bellow 6 °C and MAP lower than 500 mm, and there is also a marked intolerance to colder and drier climates. Species of Holarctic distribution have been found in Nearctic (C. gonytrichodes, Ca. filamentosa, Ca. pini), Palearctic (C. lignicola, Ca. yunnanensis, S. aquatica) or in both regions (Ca. lutea, Ca. minuta, Ca. parvilobata, S. cangshanensis). Species with tropical distribution were found in Neotropics (C. amazonensis, C. phasma, S. novae-guineensis, S. ramulosetula), Paleotropics (C. terminalis) or in both tropical realms (C. assamica, C. pandanicola, S. malaysiana). Some species were present in Australasia and Southeast Asia (C. lambertiae) or South Africa (S. septata). The global distribution was found in C. paniculata (mostly temperate region), C. siamensis (tropical or very humid regions) and C. fertilis (all climatic zones). The most abundant species were C. fertilis (655 samples), Ca. parvilobata (227 samples), and C. paniculata (111 samples).
Using the GlobalFungi database, we identified diversity hotspots in Caspian Hyrcanian mixed forests, where we found five species (C. gonytrichodes, Ca. lutea, Ca. minuta, Ca. yunnanensis, S. cangshanensis) in samples from the study of Bayranvand et al. [115]. The centre of diversity of tropical species was found in Central America in Puerto Rico (C. siamensis, C. phasma, C. fertilis, C. pandanicola, S. novae-guineensis S. malaysiana) in samples studied by Peay et al. [116], Tedersoo et al. [117], Urbina et al. [118], and Zhou et al. [119].
3.5. Taxonomy
Based on the results of multilocus phylogenetic analysis, ancestral inference, barcode gap, morphological data, and assessment of biogeography, the new taxonomic treatment of Codinaea and similar fungi is presented. The current circumscription of Codinaea is revised and several new genera, species, and combinations are proposed below. A key to Codinaea, its segregates, and similar fungi is provided (Table 2).

Table 2.
Key to Codinaea and Similar Genera with Mononematous Conidiophores and Setulate Conidia.
3.5.1. The Genus Codinaea
Codinaea Maire, Publ. Inst. Bot. Barcelona 3: 15. 1937.
= Menisporella Agnihothr., Proc. Natl. Acad. Sci. India B 56: 98. 1962.
= Codinaeopsis Morgan-Jones, Mycotaxon 4: 166. 1976.
= Bahusutrabeeja Subram. & Bhat, Can. J. Bot. 55: 204. 1977.
= Phialolunulospora Z.F. Yu & R.F. Castañeda, MycoKeys 76: 23. 2020.
Type species. Codinaea aristata Maire, Publ. Inst. Bot. Barcelona 3: 15. 1937.
Emended description: Colonies on natural substrate effuse, hairy, brown to black, composed of setae and conidiophores, mycelium semi-immersed or immersed. Anamorph. Setae present or absent, if present single or arise in groups from stromatic cells or knots of hyphal cells, erect, straight or flexuous, septate, pigmented, thick-walled, paler and thinner-walled toward the apex, unbranched, apex sterile, tapering or modified into a phialide with a terminal or several lateral openings. Conidiophores macronematous, mononematous, single or arise in fascicles from stromatic cells or knots of hyphal cells around the base of the setae, erect, straight or flexuous to slightly geniculate or undulate, unbranched or branched, occasionally with nodose or collar-like hyphae formed just below the septa, septate, smooth, pigmented, paler toward the apex, terminating into a phialide or with a sterile setiform extension. Conidiogenous cells integrated, terminal or discrete, lateral, mono- or polyphialidic, extending percurrently and sympodially, paler than the conidiophore; collarettes funnel-shaped. Conidia of two morphologically distinct types; macroconidia predominantly falcate to lunate, sometimes oblong-falcate, ellipsoid to ellipsoid-fusiform or broadly oblong, occasionally vermiform, slightly truncate at the base, with an inconspicuous basal scar, with a straight or gently curved setula at each end, sometimes setulae also inserted ventrally and dorsally, or also globose to pyriform with setulae distributed over the surface of the conidium, aseptate, hyaline, conidia accumulate in slimy fascicles; microconidia (formed occasionally and only in vitro) ellipsoidal to oblong, aseptate, hyaline, with a miniature setula. Teleomorph. Unknown.
Habitat and geographical distribution: Codinaea includes mainly saprobes that have been recorded from soil, decaying fruits, leaves, petioles, palm fronds, bark, wood, and roots, as well as leaf spots of a wide range of plant hosts. Some species have also been isolated as endophytes. In addition, C. fertilis has been recorded as a plant pathogen. The genus Codinaea has a wide geographic distribution with occurrence in the tropical and temperate climatic zones supported by literature, field records, and environmental sequence data from the GlobalFungi database.
Note: In the three-gene phylogeny (Figure 2), Codinaea is shown as a strongly supported monophyletic clade. Based on the results of the phylogenetic analysis, the generic concept of Codinaea was emended and 14 species were accepted in the genus; the inclusion of 13 species was verified with DNA data. The teleomorph of Codinaea is unknown. Although we were not successful in recollecting C. aristata, we analyzed seven other species that match the Codinaea s. str. Morphotype in all details, i.e., dark brown, thick-walled central seta or setae arranged in a fascicle with shorter, paler, and thinner-walled conidiophores bearing terminal phialides and falcate, aseptate, hyaline conidia with setulae at each end. All seven species of the C. aristata morphotype clustered in the Codinaea clade, namely C. assamica, C. fertilis, C. pandanicola, C. paniculata, C. phasma, C. siamensis, and C. terminalis.
Based on the arrangement of setae and conidiophores and their branching pattern, we distinguish four morphotypes C1–C4 (Figure 8) in Codinaea. In addition to species with the Codinaea s. str. morphotype (C1), other lineages of species characterized by three other morphotypes were nested among them. Four species with unbranched, dark brown, thick-walled conidiophores that closely resemble the setae and terminate into a monophialide (C2: e.g., C. ellipsoidea and C. lignicola); one species with conidiophores with a sterile setiform extension and integrated, terminal phialides borne in groups on short unilateral, branched stalks (C3: C. amazonensis), and one species with branched conidiophores and discrete, lateral phialides borne on nodose hyphae or directly on conidiophores (C4: C. gonytrichodes). The conidiophore variability found in Codinaea compares well with that of Chloridium (Chl.) and Menispora (Figure 8 and Figure 9) (see Discussion, Section 4.1).

Figure 8.
Illustrations of morphotypes based on the arrangement of setae, conidiophores and conidiogenous cells. (A) Codinaea morphotypes C1–C4 (B) Codinaeella morphotypes CA1–CA2 (C) Chloridium morphotypes CH1–CH3 (D) Menispora morphotypes M1–M4.

Figure 9.
Selected morphotypes of Menispora and Chloridium. (A) M. ciliata morphotype M2 (CBS 122131); (B) M. tortuosa morphotype M3 (CBS 117552) (C,D) M. uncinata morphotype M4 (ICMP 18253) (E) M. britannica morphotype M1 (PRA-20985) (F) Chl. virescens morphotype CH1 (M.R. 3886) (G) Chl. caesium morphotype CH3 (M.R. 1883). Scale bars: (A,B,D,E) 20 μm; (C) = 100 μm; (F,G) 50 μm.
Conidia also show some variability. Although they are always aseptate and hyaline, they vary in shape. They are mostly falcate to lunate, curved, occasionally vermiform but several species have also ellipsoidal-fusiform to more or less ellipsoidal conidia with setulae inserted at the apical and basal ends. The globose to pyriform conidia of C. dwaya with numerous setulae irregularly distributed over the surface represent a character that is unusual in Codinaea. The falcate conidia of C. phasma form a simple setula at each end under natural conditions, however, in culture, they become irregularly ellipsoidal and have 3(–5) setulae inserted also on the ventral and dorsal sides.
Interestingly, the ex-type strains of Bahusutrabeeja dwaya CBS 261.77 [120] and Phialolunulospora vermispora CGMCC 3.19632 [50], and a non-type strain of Codinaeopsis gonytrichodes CBS 593.93 [42] clustered in this clade. The two former species form simple conidiophores terminating into a monophialide and correspond to the C2 morphotype, while C. gonytrichodes is the only representative of the C4 morphotype. Based on the phylogenetic evidence, Bahusutrabeeja, Codinaeopsis, and Phialolunulospora are proposed as generic synonyms of Codinaea. Although Codinaeopsis and Phialolunulospora are monotypic genera, Bahusutrabeeja accommodates five other species, but only two of them resemble C. dwaya.
Several other morphologically similar species, whose living cultures or DNA sequence data are not available for study, are discussed below. These taxa should be considered candidates for inclusion in Codinaea, however, such relationships need to be supported by molecular data. Species such as Dictyochaeta gyrosetula [24], D. intermedia [121], D. plovercovensis [122], D. tilikfrei [123], and D. vittata [24] correspond to the Codinaea s. str. morphotype (C1). The C2 morphotype also occurs in C. aquatica [124], C. leomaiae [125], C. tropicalis [126], D. fimbriaspora [44], D. multifimbriata [34], D. multisetula, and D. renispora [44], which often have ellipsoidal to reniform or drop-shaped conidia with two or more setulae. Morphotype C4 with discrete phialides borne on nodose hyphae was also recorded in D. pahangensis [21] and Dictyochaetopsis polysetosa [127]. A synopsis table with diagnostic features of accepted species of Codinaea is provided in the Supplementary File: Table S4.
Codinaea amazonensis (Matsushima) Réblová & Hern.-Restr., comb. nov. MycoBank MB 842191 (Figure 10 and Figure 11).

Figure 10.
Codinaea amazonensis (MUCL 41171). (A–C) Conidiophores (D–G) conidiogenous cells (H–J) conidia. Images: (A–J) on MLA after 4 weeks. Scale bars: (A–C) 20 μm; (D–J) 10 μm.

Figure 11.
Colony morphology of Codinaea spp. after 4 weeks. (A) C. amazonensis MUCL 41171 (B) C. gonytrichodes CBS 593.93 (C) C. phasma CBS 147516 ex-type. Scale bar: (A–C) 1 cm.
Basionym. Menispora amazonensis Matsush., Matsush. Mycol. Mem. 7: 57. 1993.
Culture characteristics: On CMD: colonies 33–35 mm diam, circular, flat, margin entire, cobwebby, beige-brown, beige toward the margin, reverse isabelline. On MLA: colonies 65–67 mm diam, circular, raised, margin entire, velvety-lanose, floccose, furrowed, zonate, smoke grey centrally, dark grey toward the margin, white-grey at the margin, with a grey-brown outer zone of submerged growth, reverse dark grey-brown. On OA: colonies 57–58 mm diam after 28 d, circular, raised, margin entire, velvety to cobwebby, mucoid at the margin, furrowed, zonate, with an intermediate zone of sparse growth, beige-brown, olivaceous brown at the margin, reverse dark brown. On PCA: colonies 58–60 mm diam, circular, slightly raised, flat at the margin, margin entire to curled, cobwebby, floccose locally, mucoid toward the periphery, beige-brown, dark brown with an orange tinge at the margin, reverse dark brown. Sporulation was sparse on CMD, OA, and PCA, moderate on MLA.
Colonies on MLA effuse, hairy, mycelium composed of branched, septate, hyaline to subhyaline hyphae 1.5–2 μm diam. Anamorph. Setae absent. Conidiophores 260–320 μm long, 4.5–6.5 μm wide near the base, macronematous, single, erect, septate, smooth, dark brown, slightly paler toward the apex, with a sterile setiform extension, apex acute, pale brown, conidiophores with unilateral phialide-bearing stalks, which arise just below the septa, 19–36 μm long including the phialides, 3.5–5 μm wide at the base, stalks are curved upwards, composed of a cylindrical basal cell and several compact, densely aggregated cells bearing 1–15 phialides, basal cell is medium to dark brown, other cells are pale brown to subhyaline. Conidiogenous cells 8.5–13.5 × 3–4.5(–5) μm tapering to 1–2 μm below the collarette, discrete, lateral, arise on stalks or on conidiophores, sometimes stalked or sessile phialides arise on vegetative mycelium, mostly monophialidic, occasionally with 1–2 lateral openings, extending percurrently and sympodially, lageniform, pale brown, paler than the conidiophore; collarettes 2.5–4 μm wide, funnel-shaped, subhyaline. Conidia 9–11.5 × 1.5–2(–2.5) μm (mean ± SD = 9.9 ± 0.7 × 2.0 ± 0.2 μm), falcate, tapering toward both ends, slightly truncate at the base with an inconspicuous scar, aseptate, hyaline, with straight or gently curved setula at each end 5.5–9 μm long, inserted terminally at the apex, subterminally at the base, conidia accumulate in pale ochre fascicles. Teleomorph. Unknown.
Specimen examined: BRAZIL, Mata Avenca-Santa Rita, on rotten leaf, 10 September 1997, J. Guarro (culture MUCL 41171).
Habitat and geographical distribution: According to literature, it is a rare species isolated from soil and decaying leaves of Quercus dentata and other unidentified hosts in South America and Asia: Brazil and Japan [5,128,129]. Czeczuga and Orłowska [130] reported this species (as Menispora amazonensis) in the water from melting ice collected from branches of coniferous trees in Poland. However, given the similarity of C. amazonensis to Menispora tortuosa [131,132,133], which is common in the temperate zone of Europe and North America, and the known distribution of C. amazonensis in tropical and subtropical areas, it is possible that the fungus from melting snow may have been misidentified.
According to GlobalFungi, the identical sequences were found in one soil sample from the forest in South America (Amazonian river basin, Brazil) [117], which is in agreement with the original data and where the type was collected [128]. The location has a tropical climate (MAT avg. 25 °C, MAP avg. 2803 mm).
Notes: Codinaea amazonensis was originally described from a decaying leaf in the Amazon river basin in Peru [128]. However, no type or authentic material is available. Our strain MUCL 41171, originally published under the name Codinaea gonytrichodes [129], matches the protologue and original illustration of C. amazonensis in all details.
This species differs from other Codinaea species in the branching pattern of the conidiophores, which have a sterile extension. In addition, short stalks arise unilaterally almost the entire length of the conidiophores; they consist of several compact cells that bear a group of phialides. Codinaea amazonensis superficially resembles C. gonytrichodes, which forms collar-like and nodose hyphae at the conidiophore septa, from which arise discrete phialides and occasionally branches and setae. Interestingly, the fungus reported as C. gonytrichodes from Japan and described and illustrated by Matsushima [5], is in fact C. amazonensis [128].
Codinaea aristata Maire, Publ. Inst. Bot. Barcelona 3: 15. 1937. (Figure 1).
≡ Dictyochaeta aristata (Maire) Aramb. & Cabello, Mycotaxon 34: 681. 1989. (Nom. inval., Art. 41.4).
≡ Dictyochaeta aristata (Maire) Whitton, McKenzie & K.D. Hyde, Fungal Divers. 4: 136. 2000.
Typification: SPAIN, Catalonia, Sant Miquel de Cladells, on decaying stem of Rubus sp. lying on the ground, date unknown, R. Maire (holotype not available). Lectotype illustration: Maire, Fungi Catalaunici: Series altera. Contributions a l’étude de la flore mycologique de la Catalogne. Publ. Inst. Bot. Barcelona 3: 15, Figure 1. 1937 (lectotype illustration designated here MBT 10004618, Figure 1).
Habitat and geographical distribution: Saprobe on a stem of Rubus sp. in Europe, Spain.
Notes: Maire [1] described C. aristata on a decaying stem of Rubus sp. lying on the ground close to the torrent near Sant Miquel de Cladells in Catalonia, Spain. The species was characterized with setae 250 μm long and longer, sterile, arising singly or in a group of two, erect, dark brown, thick-walled, several-septate, smooth, unbranched, sterile at the apex; conidiophores up to 100 μm long, in bundles with setae, pale brown, thin-walled, flexuous, 1–2-septate, tapering apically; conidia 12–14 × 2 μm, falcate, aseptate, hyaline, with a setula at each end, 4–6 μm long at the apical end and ca. 1 μm long at the basal end, soon evanescent.
Because the holotype or other authentic material of C. aristata could not be found [2] and other collections or cultures of this species are not available, the illustration accompanying the protologue [1] is designated here as a lectotype (Figure 1). Codinaea aristata resembles C. fertilis [2] and C. siamensis [47], but differs in conidia with shorter setulae of a different length.
Codinaea assamica (Agnihothr.) S. Hughes & W.B. Kendr., N. Z. J. Bot. 6: 334. 1968. (Figure 12 and Figure 13).

Figure 12.
Codinaea assamica (CBS 139907 ex-type of C. acaciae). (A–E) Setae with conidiophores (F–H) conidia (I) apical part of the setae. Images: (A–I) on pine needles on SNA after 4 weeks. Scale bars: (A,D) 25 μm; (B) 50 μm; (C,E) 20 μm; (F–I) 10 μm.

Figure 13.
Colony morphology of Codinaea spp. after 4 weeks. (A) C. assamica CBS 139907 ex-type of C. acaciae (B) C. fertilis IMI 233824 (C) C. fertilis MUCL 15427 (D) C. dwaya CBS 261.77 ex-type (E) C. siamensis CBS 194.96. Scale bar: (A–C) 1 cm.
Basionym. Menisporella assamica Agnihothr., Proc. Indian natn Sci. Acad., Part B. Biol. Sci. 56: 99. 1962.
≡ Dictyochaeta assamica (Agnihothr.) Aramb., Cabello & Mengasc., Darwiniana 28: 297. 1988. (Nom. inval., Art. 41.4).
= Codinaea acaciae Crous & M.J. Wingf., Persoonia 34: 181. 2015.
Culture characteristics: On CMD: colonies 75–78 mm diam, circular, flat, margin fimbriate, sparsely lanose to cobwebby, funiculose at the inoculation block, olivaceous beige, grey-brown centrally, aerial mycelium with numerous colorless exudates, reverse olivaceous beige. On MLA: colonies 48–50 mm diam, circular, raised, margin fimbriate, lanose, grey-brown, olivaceous brown at the margin, reverse dark brown. On OA: colonies 69–70 mm diam, raised, margin fimbriate, lanose, floccose, grey with irregular white patches, dark olivaceous grey at the margin, reverse dark grey. On PCA: colonies 70–72 mm diam, circular, flat, margin fimbriate, cobwebby, lanose at the inoculation block, zonate, pale brown at the centre becoming olivaceous beige toward the periphery, dark olivaceous brown at the margin, reverse of the same colors. Sporulation was abundant on MLA, moderate on PCA and OA, absent on CMD.
Colonies on SNA with pine needles effuse, hairy, brown, mycelium composed of branched, septate, subhyaline to pale brown hyphae 1.5–2.5 μm diam. Anamorph. Setae 273–360 μm long, 5–7 μm wide near the swollen base, arise solitary or in groups of two from conspicuous dark brown stromatic cells, erect, straight or flexuous, septate, smooth, unbranched, dark brown, thick-walled, paler and thinner-walled toward the apex, apex pale brown to subhyaline, sterile when young, broadly rounded, later with a terminal or 1–3 lateral phialidic openings. Conidiophores 42–125 μm long, 3.5–4.5(–5) μm wide near the base, macronematous, arise in fascicles of 3–9 from stromatic cells around the base of the setae, unbranched, erect, straight or flexuous or geniculate to undulate, septate, smooth, pale to medium brown, gradually paler toward the apex. Conidiogenous cells 14.5–27 × 3.5–4.5(–5) μm tapering to 1.5–2 μm below collarette, integrated, terminal, mono- or polyphialidic with 1–3 lateral openings while internally septa can be formed, extending percurrently and sympodially, cylindrical, slightly swollen bellow the collarette, pale brown, subhyaline at the apex; collarettes 3.5–4.5 μm wide, 2–2.5 μm deep, funnel-shaped, subhyaline to pale brown. Conidia 14–18 × 2.5–3.5 μm (mean ± SD = 15.9 ± 0.9 × 2.9 ± 0.3 μm), falcate, tapering toward both ends, narrowly rounded apically, slightly truncate at the base with an inconspicuous scar, aseptate, hyaline, with straight or gently curved setula at each end (5.5–)7–13.5 μm long, inserted terminally at the apex, subterminally at the base, conidia accumulate in slimy whitish fascicles. Teleomorph. Unknown.
Specimen examined: MALAYSIA, Sarawak, from leaf spots of Acacia mangium, May 2014, M.J. Wingfield (ex-type strain of Codinaea acaciae CBS 139907).
Habitat and geographical distribution: Saprobe on woody roots, leaf litter, leaf spots and decaying petioles of Acacia mangium, Camelia sinensis, Cedrela odorata, Cyperus radians, and other unidentified hosts in Central and South America and Asia: Brazil, Cuba, India, and Malaysia [3,25,36,53,134,135]. Rambelli et al. [35] reported C. assamica on fallen leaves of 10 hosts from Africa from Ivory Coast, namely Anthonotha fragrans, Calpocalyx brevibracteatus, Chrysophyllum taiense, Dialium aubrevillei, Hypselodelphys violacea, Lophira alata, Manniophyton fulvum, Memecylon lateriflorum, Pentaclethra macrophylla, and Piptadeniastrum africanum.
According to GlobalFungi, the identical sequences were found in two soil samples from the forest in Asia on Malaysian peninsula and Kalimantan [117], and in two root samples from forest in South America in French Guiana [136]. The sites have a tropical climate (MAT avg. 24 °C, MAP avg. 2612 mm).
Notes: Hughes and Kendrick [2] gave a detailed description of C. assamica by examining the holotype material of Menisporella assamica from India [3]. Unfortunately, no culture derived from the type or other material of C. assamica is available. Our study of the ex-type strain of C. acaciae CBS 139907 revealed it is remarkably similar to C. assamica. Crous et al. [53] isolated C. acaciae from leaf spots of Acacia mangium in Malaysia and based the description on observations in culture. However, the setae were absent and the conidiophores were somewhat smaller, 15–30 × 3–3.5 μm. Based on our experience, some Codinaea species do not form setae readily on agar media and conidiophores may not be fully developed, which can complicate a correct identification. However, on SNA with pine needles, the fungus formed setae arranged in typical bundles with conidiophores growing from stromatic basal cells. Although conidia have one setula at each end, we have rarely observed conidia in culture with two setulae inserted at one end (two conidia in total), a character observed for example in C. phasma (this study). Based on a detailed comparison of our observations of C. acaciae with C. assamica on natural material [2,3] and in culture [25], we concluded that they are conspecific. Therefore, C. acaciae is reduced to synonymy with C. assamica.
Codinaea assamica resembles C. paniculata [46], C. siamensis [47], and C. terminalis [30]. Codinaea paniculata mostly occurs in the Holarctic zone and differs in shorter setae, monophialidic conidiogenous cells and conidia with shorter setulae. Codinaea siamensis possesses broader conidia, and C. terminalis differs in monophialidic conidiogenous cells and larger conidia. Dictyochaeta plovercovensis [122], whose culture and DNA data are not available, also resembles C. assamica but differs in shorter conidiophores and narrower conidia with shorter setulae.
Codinaea dwaya (Subram. & Bhat) Réblová & Hern.-Restr., comb. nov. MycoBank MB 842192. (Figure 13 and Figure 14).

Figure 14.
Codinaea dwaya (CBS 261.77 ex-type). (A–G) Conidiophores (H–J) conidia (K–O) microconidia. Images: (A–O) on stems of U. dioica on CMA after 8 weeks. Scale bars: (A–G) 20 μm; (H–O) 10 μm.
Basionym. Bahusutrabeeja dwaya Subram. & Bhat, Can. J. Bot. 55: 2204. 1977.
Culture characteristics: On CMD: colonies 75–76 mm diam, circular, flat, margin entire, mucoid, smooth, funiculose at the inoculation block, isabelline, reverse of the same color. On MLA: colonies 59–61 mm diam, circular, raised to slightly convex, margin weakly fimbriate, lanose, floccose, mucoid at the margin, white-grey with an olivaceous brown outer zone, reverse dark olivaceous brown. On OA: colonies 75–78 mm diam, circular, flat to slightly raised, margin fimbriate, lanose becoming mucoid, whitish-beige, pale brown becoming cinnamon-brown centrally when mucoid, reverse dark grey. On PCA: colonies 82–83 mm diam, circular, flat, margin fimbriate, mucoid centrally, cobwebby toward the periphery, funiculose at the inoculation block, pale olivaceous-isabelline centrally, white grey at the margin, reverse whitish. Sporulation was absent on all media.
Colonies on CMA with U. dioica stems effuse, hairy, mycelium composed of branched, septate, hyaline to brown hyphae 1–2.5 μm diam. Anamorph. Setae absent. Conidiophores (33–)74–254 μm long, tapering toward the base 3–5.5(–8.6) μm wide, gradually widening upwards, 5–10(–11.5) μm wide at the broadest point, macronematous, solitary, unbranched, straight or flexuous, smooth, medium brown becoming dark brown at maturity, darkest in the middle, paler toward the apex and base. Conidiogenous cells 18–66 × 6.5–11.5 μm, tapering to 3–6.5(–7.5) μm below the collarette, integrated, terminal, monophialidic, extending percurrently, subcylindrical with a swollen venter, fulvous, gradually paler toward the apex; collarette 4.5–10 μm wide, 1.5–3 μm deep, pale brown, flared, shallow, indistinct. Conidia of two morphologically distinct types: macroconidia variable in shape and size, the first conidium is broadly oblong or pyriform 15.5–22 × 10.5–14.5 μm (mean ± SD = 18.7 ± 2.1 × 13 ± 2.8 μm), subsequent conidia globose 15–16 μm diam (mean ± SD = 15.5 ± 0.5 μm), thick-walled, aseptate, hyaline, with 6–10 straight or gently curved setulae distributed over the surface, 6–10.5 μm long; microconidia 4.5–6.5 × 2–2.5 μm (mean ± SD = 5.1 ± 0.8 × 2.4 ± 0.2 μm), formed from the same conidiogenous loci, ellipsoidal to oblong, aseptate, hyaline, with a miniature setula at one end 1–1.5 μm long; macroconidia and microconidia accumulate in slimy whitish fascicles. Teleomorph. Unknown.
Specimen examined: INDIA, Karnataka, Coorg district, near Abby Falls, on dead twigs of Coffea arabica, 10 May 1976, D.J. Bhat (ex-type culture CBS 261.77 = JCM 6357 = IMI 213921).
Habitat and geographical distribution: Saprobe on decaying bark and wood of Coffea arabica and other unknown hosts, known from Asia from China and India [120,135,137,138]. The GlobalFungi database did not contain similar sequences (≥98% sequence identity) of this species.
Notes: In the phylogenetic analysis, the ex-type strain of B. dwaya, the generic type, clustered in the Codinaea clade among species with falcate to ellipsoidal conidia with two or more setulae, setae and variability in conidiophores. Based on this result, Bahusutrabeeja is reduced to synonymy with Codinaea and a new combination is proposed. The unique characters of C. dwaya are globose or pyriform conidia with multiple appendages. Our observations of the ex-type strain of C. dwaya are consistent with those of Subramanian and Bhat [120]. In addition, we observed microconidia with a rudimentary appendage, which formed alongside the macroconidia from the same conidiogenous locus (Figure 14K–O).
Two other Bahusutrabeeja species, B. bunyensis [139] and B. globosa [126], closely resemble C. dwaya in having globose to subglobose, multi-setulate conidia. Bahusutrabeeja bunyensis differs in having smaller conidia with only 2–3 setulae, while B. globosa has larger conidia compared to C. dwaya. The conidia of B. angularis [140] have an angular outline and should be compared with Nawawia [141]. Other species currently referred to Bahusutrabeeja differ in conidial shape and lack setulae, and their taxonomic treatment needs to be resolved using phylogenetic arguments.
Codinaea ellipsoidea (Z.L. Luo, K.D. Hyde & H.Y. Su) Réblová & Hern.-Restr., comb. nov. MycoBank MB 842193.
Basionym. Dictyochaeta ellipsoidea Z.L. Luo, K.D. Hyde & H.Y. Su, Fungal Divers. 99: 593. 2019.
For description, illustration, and comparison with morphologically similar species see Luo et al. [29].
Habitat and geographical distribution: A saprobe on submerged wood of unidentified hosts, known only from Asia, China [29]. The GlobalFungi database did not contain similar sequences (≥98%) of this species.
Notes: The species is known from several collections from China. It is characterized by the absence of setae and having dark pigmented, setiform conidiophores terminating into a monophialide with setulate ellipsoidal conidia.
Codinaea fertilis S. Hughes & W.B. Kendr., N. Z. J. Bot. 6: 347. 1968. (Figure 13, Figure 15 and Figure 16).

Figure 15.
Codinaea fertilis (DAOM 93548c isotype). (A) Substrate with colonies (B) colony on a dead leaf (C,D) conidiophores (E,F) apices of setae with phialidic apertures (G,H) conidia. Images: (A–H) from nature. Scale bars: (B) 500 μm; (C) 25 μm; (D) 20 μm; (E–H) 10 μm.

Figure 16.
Codinaea fertilis (IMI 233824). (A–D) Setae with conidiophores (E) conidia (F,G) conidiogenous cells at the tip of the setae. Images: (A–G) on PCA after 6 weeks. Scale bars: (A,B) = 50 μm; (C,D) 20 μm; (E–G) 10 μm.
≡ Dictyochaeta fertilis (S. Hughes & W.B. Kendr.) Hol.-Jech., Folia geobot. phytotax. 19: 426. 1984.
Culture characteristics: On CMD: colonies 75–77 mm, circular, flat, margin fimbriate, lanose, somewhat funiculose centrally, white-beige, reverse olivaceous beige. On MLA: colonies 66–68 mm diam, circular, convex, margin entire, lanose, floccose, with funiculose projections at the centre, becoming finely furrowed, grey-brown with a dark olivaceous brown outer zone, isabelline at the colony margin, reverse dark grey-brown. On OA: colonies >100 mm diam (colony reached the edge of 10 mm Petri dish), circular, flat, margin entire, lanose, olivaceous brown, camel brown toward the periphery with a dark olivaceous grey outer zone, reverse dark grey. On PCA: >100 mm diam (colony reached the edge of 10 mm Petri dish), flat, lanose, cobwebby toward the margin, beige, olivaceous beige at the margin, reverse dark olivaceous grey. Sporulation was abundant on all media after prolonged incubation (>6 weeks).
Colonies on PCA effuse, hairy, mycelium composed of branched, septate, subhyaline to pale brown hyphae 1.5–3 μm diam. Anamorph. Setae 152–340 μm long, 4.5–6.6 μm wide near the base, arise solitary or in group of 2–4 from dark brown stromatic cells, erect, straight or flexuous, septate, smooth, unbranched, rarely branched, dark brown, paler, and thinner-walled toward the apex, apex pale brown to subhyaline, with a terminal phialidic opening. Conidiophores 66–146 μm long, 4–5(–5.5) μm wide near the base, macronematous, single or arise in fascicles of 3–7 from dark brown hyphal cells around the bases of the setae, erect, straight or flexuous, septate, smooth, unbranched, occasionally branched in the upper part, pale to medium brown, thick-walled, gradually paler and thinner-walled toward the apex. Conidiogenous cells (15–)30–47 × 4.5–5.5(–6) μm tapering to 2–2.5 μm below the collarette, integrated, terminal, monophialidic, rarely polyphialidic with one lateral opening, extending percurrently (with up to five percurrent proliferations) or sympodially, subcylindrical, slightly swollen bellow the collarette, pale brown, subhyaline at the apex; collarettes 5.5–7.5 μm wide, 2.5–3 μm deep, funnel-shaped, subhyaline to pale brown. Conidia (10–)11–14.5 × 3.5–4.5 μm (mean ± SD = 12.8 ± 1.1 × 3.9 ± 0.4 μm), falcate to ellipsoidal-fusiform, slightly truncate at the base, with straight or gently curved setula at each end, 3.5–6.5(–9) μm long, conidia accumulate in slimy whitish fascicles. Teleomorph. Unknown.
Specimens examined: FRANCE, Guadeloupe region, on root of Musa sp., 1966, J. Brun (culture CBS 242.66 = MUCL 15427). NEW ZEALAND, Auckland province, Waitakere Range, Waiatarua, on basis of dead leaves of Rhopalostylidis sapidae, 8 May 1963, S.J. Hughes 706c (isotype of Codinaea fertilis DAOM 93548c). NEW ZEALAND, on root of Betula sp., 1979, L. Mattson LEV 13960 (culture IMI 233824).
Habitat and geographical distribution: Based on literature records, C. fertilis commonly occurs on decaying leaves, petioles, palm fronds, bark, wood, woody fruits and roots of Alchornea cordifolia, Calathea stromata, Carya ovata, Cedrela odorata, Ctenanthe oppenheimiana, Euterpe oleracea, Fraxinus excelsior, Freycinetia sp., Maranta bicolor, Nothofagus menziesii, Pandanus tectorius, Pandanus sp., Quercus ilex, Q. robur, Quercus sp., Rhopalostylis sapida, Stromanthe sanguinea and other unknown hosts in terrestrial and freshwater habitats. The species was reported from Africa, Australasia, Europe, South and North America, and Southeast Asia: Brazil, Brunei, Canada, Czech Republic, China, Ivory Coast, Malaysia, New Zealand, The Netherlands, Philippines, Slovak Republic, and USA [2,25,26,30,35,36,37,44,121,142,143,144,145,146,147,148]. Strains examined in this study were isolated from roots of Betula sp. from New Zealand and Musa sp. from France (Guadeloupe).
According to GlobalFungi, of all the fungi studied, this species is the most abundant worldwide in different climatic regions. The identical sequences were found in 655 samples, originating from 46 studies, collected on all continents including Antarctica. It was found in Africa (Ethiopia, Madagascar, South Africa, St. Helena island, Zambia, Zimbabwe), Asia (China, Malaysia, Papua New Guinea), East and South Australia, Europe (Northern Spain, Estonia, Germany, Austria, the Netherland, Slovenia), Hawaii, Central America and Central America (Mexico, Costa Rica, Puerto Rico, Trinidad and Tobago, Panama), North America (Oregon, Kansan, South Carolina, Minnesota, Tennessee, Luisiana, Georgia, Michigan), South America (Argentina). The sample types were soil (58%), rhizosphere (20%), root (15%) and shoot (6%) collected in cropland (37%), forest (30%), grassland (23%), woodland (7%), shrubland (2%) and desert (0.2%) habitats. The locations, with very few exceptions, have a tropical or temperate climate (MAT avg. 15 °C, MAP avg. 1066 mm).
Codinaeella fertilis has also been recorded as a plant pathogen causing root rot of Lolium perenne, Medicago sativa, Trifolium repens, T. praetense, T. subterraneum and other important perennial pasture legumes in Australasia and North America: New Zealand and USA e.g., [54,56,149,150,151].
Notes: Hughes and Kendrick [2] described C. fertilis from leaf bases of Rhopalostylidis sapidae in New Zealand with conidia 9–15.4 × 2–3 μm and setulae 5–10 μm long. The revision of the isotype (Figure 15) revealed certain variability in the shape and width of conidia. Although conidia were mostly falcate, 13–15 × 2.5(–3) μm, some conidia were also ellipsoidal-falcate and somewhat wider, 10–13 × (2.5–)3(–3.5) μm. Our observations of C. fertilis in culture are consistent with those of the isotype; conidia of the strain IMI 233824 were predominantly ellipsoidal-falcate, however wider (3.5–4.5 μm) when grown in culture (Figure 16). Although C. fertilis sporulated abundantly on all four media, conidiophores associated with setae were formed only on MLA and PCA.
In characters of conidia, C. fertilis is comparable to other species such as C. aristata [1], C. paniculata [46], and Dictyochaeta plovercovensis [122]. Codinaea aristata differs by narrower conidia with two asymmetrical setulae at each end, C. paniculata possesses conidia longer in their upper range with longer setulae and D. plovercovensis has narrower conidia with longer setulae.
According to literature, C. fertilis is a common species with a worldwide distribution. It is possible, however, that the arrangement of setae and conidiophores in the bundles may have been misinterpreted or overlooked. In such cases, C. fertilis could be confused with Ca. lutea or Ca. parvilobata (this study). They differ in setae, which grow independently and conidiophores are interspersed among them. The suspicion that some strains might be misidentified as C. fertilis was confirmed by molecular data. Three of the analysed strains, initially identified as C. fertilis (CBS 624.77, ICMP 14613, and ICMP 15540), were confirmed as members of the genus Codinaeella and represent Ca. lutea.

Figure 17.
Codinaea gonytrichodes (CBS 593.93). (A–D) Conidiophores (E) conidia (F–H) conidiogenous cells arising from collar hyphae (I,J) conidiogenous cells at the tip of the conidiophore. Images: (A–J) on OA after 8 weeks. Scale bars: (A,B) 20 μm; (C,D) 50 μm; (E–J) 10 μm.
≡ Codinaeopsis gonytrichodes (Shearer & J.L. Crane) Morgan-Jones [as “gonytrichoides”], Mycotaxon 4: 167. 1976.
≡ Dictyochaeta gonytrichodes (Shearer & J.L. Crane) Kuthub. & Nawawi [as “gonytrichoides”], Mycol. Res. 95: 845. 1991.
≡ Dictyochaetopsis gonytrichodes (Shearer & J.L. Crane) Whitton, McKenzie & K.D. Hyde [as “gonytrichoides”], Fungal Divers. 4: 156. 2000.
Culture characteristics: On CMD: colonies 45–50 mm diam, circular, raised, margin entire to fimbriate, lanose, floccose, sparsely funiculose, cobwebby at the margin, whitish-brown, reverse dark brown. On MLA: colonies 75–78 mm diam, circular, raised, margin lobate, lanose, floccose, funiculose at the inoculation block, zonate, mouse grey centrally, paler toward the periphery dark olivaceous grey at the margin, aerial mycelium with numerous miniature colorless exudates, reverse dark grey to black. On OA: colonies 72–75 mm diam, circular, flat, margin lobate, cobwebby centrally, lanose toward the periphery, brown at the colony centre, beige-grey toward the periphery, reverse dark beige centrally, dark grey to black toward the margin. On PCA: colonies 75–76 mm diam, circular, flat, raised centrally, margin fimbriate, lanose, floccose, cobwebby at the margin, becoming mucoid locally, whitish-beige, olivaceous brown at the margin, reverse dark olivaceous brown. Sporulation was abundant on MLA, OA, and PCA, sparse on CMD.
Colonies on OA effuse, hairy, mycelium composed of branched, septate, subhyaline to brown hyphae that become encrusted upon aging, 2.5–4 μm diam. Anamorph. Setae absent. Conidiophores 160–355 μm long, 4–7 μm wide above the swollen base, gradually tapering toward the apex, macronematous, arise singly or in groups of 2–3 from knots of hyphal cells, erect, straight or slightly flexuous, septate, smooth, brown, nodose hyphae are formed laterally below the septa, pale to medium brown. Conidiophores unbranched, sometimes branched in the upper part; branches 28–45(–61) × 3–5 μm arise from the nodose and collar-like hyphae, apex pale brown to subhyaline, sterile or terminating into a mono- or polyphialide. Conidiogenous cells 11.5–17 × 4–6 μm tapering to 1.5–2 μm below the collarette, mono- occasionally polyphialidic with 1–3 lateral openings, extending sympodially, discrete, lateral, arise as stalked or sessile phialides on collar-like and nodose hyphae or directly on conidiophores, mostly in groups of (2–)3–6(–7), or integrated, terminal at the apex of the conidiophore or phialide-bearing branches, subcylindrical to lageniform, pale brown, subhyaline at the apex; collarette 3–4 μm wide, 1.5–2(–2.5) μm deep, funnel-shaped, subhyaline to pale brown. Conidia 12–14.5 × 2–2.5(–3) μm (mean ± SD = 13.4 ± 0.6 × 2.4 ± 0.3 μm), falcate, tapering toward both ends, slightly truncate at the base with an inconspicuous scar, aseptate, hyaline, with straight or gently curved setula at each end 7.5–11.5 μm long, inserted terminally at the apex, subterminally at the base, conidia accumulate in slimy whitish fascicles. Teleomorph. Unknown.
Specimen examined: JAPAN, Saitama Prefecture, Ogawa-machi, Seikoji Temple, decaying plant material, 4 September 1993, W. Gams & G. Okada (culture CBS 593.93).
Habitat and geographical distribution: Saprobe on decaying leaves, seeds, herbaceous stems and fruits of Acer sp., Carya sp., Castanopsis cuspidata, Liriodendron tulipifera, Ochroma pyramidale, Rubus sp. and other unknown hosts in freshwater and terrestrial habitats. The species is found in Asia and South and North America: Brazil, Japan, Malaysia and USA [6,21,35,37,42,127,152,153]. Occasionally it occurs on submerged wood of Ochroma pyramidale (balsa wood) in USA [6]. Rambelli et al. [35] recorded C. gonytrichodes on leaf litter of Combretum dolichopetalum, Manniophyton fulvum, Newtonia duparquetiana, and Xylopia acutiflora from Africa, Ivory Coast.
According to GlobalFungi, the identical sequences were found in 10 soil samples from forests in Asia in Iran and East China [115,117], and North America in Ohio and Georgia [119,154]. The sites have a temperate or humid continental climate (MAT avg. 15 °C, MAP avg. 1096 mm).
Notes: For descriptions and illustrations on natural substrate, see Shearer and Crane [6], Morgan-Jones [42] and Kuthubutheen and Nawawi [21]. The morphological characteristics of conidiophores, conidiogenous cells and conidia of the strain CBS 593.93 match the protologue in all details and are well-comparable with other known specimens of this species. Only conidia of CBS 593.93 were slightly broader in vitro, 2–2.5(–3) μm wide, compared to those in nature, 1.2–2.3 μm [6], 1.5–2.5 μm [42], and 1.5–2.5 μm [21].
Codinaea gonytrichodes is unique among other Codinaea in having nodose hyphae at the septa, from which lateral phialides and branches grow. In older cultures, the apex is modified into a polyphialide and discrete, lateral polyphialides frequently occur in the upper part of the conidiophore. Dictyochaetopsis polysetosa [127] closely resembles C. gonytrichodes in conidial morphology and branched conidiophores, but branches of the former species are setose, acicular, dark brown to black, arise in verticilli from nodose hyphae in the upper part of the conidiophore and remain sterile. Dictyochaeta pahangensis [21] is similar to C. gonytrichodes in having knots of hyphae at the septa along the conidiophore axis, but differs in the absence of branches, longer conidia and nodose hyphae that are bulbose and dark brown with 1–2 discrete phialides.
Codinaea lignicola (Z.L. Luo, H.Y. Su & K.D. Hyde) Réblová & Hern.-Restr., comb. nov. MycoBank MB 842194.
Basionym. Dictyochaeta lignicola Z.L. Luo, H.Y. Su & K.D. Hyde, Fungal Divers. 99: 595. 2019.
For description, illustration and comparison of C. lignicola with similar species, see Luo et al. [29].
Habitat and geographical distribution: Saprobe on submerged wood, known only from Asia, China [29]. According to GlobalFungi, the identical sequences were found in 12 samples of rhizosphere soil (92%) or soil (8%) collected in forest (92%) or grassland (8%) habitats in Asia in North East China and South Korea [155,156]. The locations have a cold and humid climate (MAT avg. 8 °C, MAP avg. 1285 mm).
Notes: Among Codinaea species, C. lignicola resembles C. ellipsoidea with simple, dark pigmented conidiophores terminated by monophialidic conidiogenous cells and absence of setae, but differs in having falcate vs. ellipsoidal conidia.
Codinaea pandanicola (Tibpromma & K.D. Hyde) Réblová & Hern.-Restr., comb. nov. MycoBank MB 842195.
Basionym. Dictyochaeta pandanicola Tibpromma & K.D. Hyde, Fungal Divers. 93: 127. 2018.
For description, illustration of C. pandanicola and its comparison with similar species, see Tibpromma et al. [48].
Habitat and geographical distribution: Saprobe on decaying leaves of Pandanus sp., known only from Southeast Asia, Thailand [48]. According to GlobalFungi, the identical sequences were found in 12 soil and one root samples from forests of Central America and the Caribbean (10 samples, Puerto Rico, Panama, Trinidat and Tobago, French Guiana) [119], North America (1 sample, Georgia) [157] and Asia (1 sample, Malaysia) [158]. The locations have tropical climate (MAT avg. 21 °C, MAP avg. 2955 mm).
Notes: Although the description of C. pandanicola did not include setae, on the photograph accompanying the protologue ([48], Figure 95b), a dark brown, thick-walled seta (broken) terminating into a phialide is accompanied by shorter, paler, and thinner-walled conidiophores terminating into mono- or polyphialides.
Codinaea paniculata Réblová & J. Fourn., MycoKeys 74: 14. 2020. (Figure 18).

Figure 18.
Colony morphology of Codinaea paniculata after 4 weeks. (A) CBS 145098 ex-type (B) CBS 127692 (C) MUCL 34876. Scale bar: (A–C) 1 cm.
For description, characteristics in culture, illustrations, and comparison with similar species, see Réblová et al. [46].
Habitat and geographical distribution: Saprobe on decaying wood and submerged leaves of Alnus glutinosa, Fraxinus excelsior and other unidentified hosts in Europe in France and United Kingdom [46]. Based on comparison of the ITS sequences of the ex-type strain with environmental sequences deposited in GenBank, C. paniculata was also isolated as a root endophyte from a beach grass Elymus mollis in North America in the USA, Oregon (ITS: KU838460, KU839605) [159] and from soil samples from an ancient woodland in the United Kingdom (ITS: KM374380) [160].
According to GlobalFungi, the identical sequences were found in 111 samples from soil (64%) or roots (36%) in grassland (43%), forest (38%), cropland (10%), or woodland (8%) habitats. Ninety-two samples originate from Europe (Belgium, Estonia, Germany, Monte Negro, Northern Spain, South Slovenia, Sweden, Wales), five samples from Africa (St. Helena island), one from Asia (Malaysia), five samples from South America (North Argentina), and eight samples were from Southeast Australia and Tasmania. The samples originate from 13 studies and the sites have temperate climate (MAT avg. 10 °C, MAP avg. 881 mm).
Specimens examined: FRANCE, Ariège, Pyrénées Mts., Rimont, La Maille brook, alt. 550 m, 28 May 2018 (incubated in moist chamber for 1 week), on submerged decaying wood, J. Fournier M.R. 3950 (holotype PRA-16319, ex-type culture CBS 145098). FRANCE, Ariège, Pyrénées Mts., Rimont, Le Baup stream, ca. 1.5 km from the village along D18 road, alt. 550 m, 12 June 2009, on submerged wood of Fraxinus excelsior, J. Fournier J.F. 09153 (PRA-16320, culture CBS 127692), Ibid., 23 May 2008, on submerged wood of Alnus glutinosa, J. Fournier & M. Delpont J.F. 08124 (PRA-16321, culture CBS 126573). UNITED KINGDOM, Liverpool, University Campus Liverpool, 1992, on submerged dead leaf in a pool, G.L. Hennebert (culture MUCL 34876).
Notes: Codinaea paniculata represents the C1 morphotype. We observed variability among strains of C. paniculata from France (CBS 127692, CBS 145098) and the United Kingdom (MUCL 34876), which is shown in Figure 18. None of the three isolates produced pigments diffusing into the agar. The most prominent growth and abundant aerial mycelium, sometimes with submerged growth, was observed on MLA and OA. The growth on CMD and PCA was rather sparse.

Figure 19.
Codinaea phasma (CBS 147516 ex-type). (A,B,I) Colonies (C,D) setae (E,F) setae with conidiophores (G) conidiogenous cell (H,M,N) conidia (J,K) apices of the conidiogenous cells, conidiogenous locus slightly protruding above the collarette (L) conidium, from the top view (O–Q) conidiophores. Images: (A–H) from nature (I–Q) on stems of U. dioica on CMA after 4 weeks. Scale bars: (C–F) 25 μm; (G,H,J–Q) 5 μm.
Etymology: Phasma (L) ghost, phantom, referring to the mysterious appearance of the multisetulate conidia in culture.
Typification: PUERTO RICO, on decaying twig of an unidentified plant, 19 July 2018, M. Hernández-Restrepo M.H.R. 18014 (holotype CBS H-24747, culture ex-type CBS 147516).
Description on the natural substrate: Colonies effuse, hairy, black. Anamorph. Setae 160–380 μm long, 5–10 μm wide near the base, gradually tapering upwards, arise solitary or in groups of two from dark brown stromatic cells, erect, straight or flexuous, septate, smooth, dark brown, thick-walled, paler, and thinner-walled toward the apex, unbranched, apex pale brown with a terminal or one to several lateral phialidic openings. Conidiophores 35–97 μm long, 2.5–4.5 μm wide near the base, macronematous, single or arise in fascicles of 2–5 from stromatic cells around the base of the setae, erect, straight or slightly bent, septate, smooth, medium to pale brown, paler toward the apex.
Conidiogenous cells 16–43 × 2.5–4 μm, 5–7 μm wide at the broadest point, tapering to 1.5–2.5 μm below the collarette, integrated, terminal, mono- or polyphialidic, occasionally extending percurrently, subcylindrical, swollen bellow the collarette, pale brown; collarettes 2–3.5 μm wide, 2–3 μm deep, funnel-shaped to slightly tubular, pale brown. Conidia 13.5–18 × 3–4 μm (mean ± SD = 15.1 ± 3.8 × 1.2 ± 0.4 μm), oblong to falcate, slightly truncate at the base with an inconspicuous basal scar, aseptate, hyaline, with a straight or gently curved setula at each end 5–13 μm long, inserted terminally at the apex, subterminally at the base, conidia accumulate in whitish slimy fascicles. Teleomorph. Unknown.
Culture characteristics: On CMD: colonies 27–30 mm diam, circular, flat to slightly convex, margin fimbriate, lanose, floccose, whitish-beige with a darker olivaceous beige zone at the margin, pale ochre pigment diffusing into the agar, reverse of the same colors. On MLA: colonies 14–17 mm diam, circular, raised, margin lobate, lanose becoming mucoid, aerial mycelium restricted to the centre of the colony, deeply furrowed with nearly cerebral-like folds, whitish centrally, pink-beige toward the margin, pale apricot pigment diffusing into the agar, reverse apricot. On OA: colonies 20–22 mm diam, circular, raised, margin undulate, weakly furrowed, lanose, aerial mycelium with colorless exudates, whitish-grey, olivaceous to mouse grey toward the margin with a whitish outer zone, pale ochre pigment diffusing into the agar, reverse apricot-grey. On PCA: colonies 42–55 mm diam, circular, slightly convex centrally with flat margin, margin entire to weakly fimbriate, lanose, whitish centrally, brown to olivaceous-brown toward the periphery, darker at the margin, reverse dark brown. Sporulation was abundant on MLA, OA, and PCA, sparse on CMD.
Colonies on CMA with U. dioica stems effuse, hairy, mycelium composed of branched, septate, hyaline to pale brown hyphae 2–4.5 μm diam. Setae, conidiophores and conidiogenous cells similar to those from nature. Setae 97–236 μm long, 3.5–6 μm above the swollen base, dark olivaceous brown, paler toward the apex, apex pale brown to subhyaline, with a terminal phialidic opening. Conidiophores 44–104 μm long, 3.5–7 μm wide above the base, arise singly or in groups, interspersed among the setae, medium brown to olivaceous brown, paler toward the apex. Conidiogenous cells 24–34 × 3.5–5 μm, 4.5–7.5 μm wide at the broadest part, tapering to 1.5–4 μm below the collarette; collarette 2–6 μm wide, 1.5–8 μm deep, funnel-shaped to tubular, subhyaline. Conidia 12–18.5 × 4.5–8 μm (mean ± SD = 14.3 ± 5.6 × 1.5 ± 1.0 μm), irregularly ellipsoidal, tapering toward both ends, sometimes slightly contracted near the base, basal end truncate to obtuse with an inconspicuous basal scar, aseptate, hyaline, with 3(–5), straight or gently curved setulae 3.5–11 μm long, inserted terminally at the apex, subterminally at the base and also dorsally and ventrally, accumulate in slimy whitish fascicles.
Habitat and geographical distribution: Saprobe on decaying wood, known only from the Caribbean from Puerto Rico. According to GlobalFungi, the identical sequences were found in two soil samples from forest in Puerto Rico [118]. The sites have tropical climate (MAT avg. 22.45 °C, MAP avg. 3013).
Notes: On natural substrate, C. phasma forms typical bundles of setae and conidiophores and oblong to falcate conidia with a single, simple setula at each end. When grown in culture, the conidia become irregularly ellipsoidal, slightly inflated in the middle and possess up to five setulae inserted also dorsally and ventrally and occasionally they can branch. It resembles C. terminalis, but the later species differs from C. phasma in longer, falcate conidia. In the present phylogeny, the two species are shown as unrelated lineages.
Codinaea siamensis (J. Yang, K.D. Hyde & J.K. Liu) Réblová & Hern.-Restr., comb. nov. MycoBank MB 842199. (Figure 13 and Figure 20).

Figure 20.
Codinaea siamensis (CBS 194.96). (A,B) Setae with conidiophores (C) conidiophores (D–F) conidiogenous cells with collarettes (G,H) conidia. Images: (A–H) on MLA after 6 weeks. Scale bars: (A) 50 μm; (B,C) 20 μm; (D–H) 10 μm.
Basionym. Dictyochaeta siamensis J. Yang, K.D. Hyde & J.K. Liu, Mycol. Prog. 15: 1159. 2016.
Culture characteristics: On CMD: colonies 35–42 mm diam, circular, flat, margin fimbriate, lanose becoming cobwebby, mucoid at the margin, beige-brown, reverse of the same color. On MLA: colonies 63–66 mm diam, circular, raised, margin entire, furrowed, lanose, funiculose, pale olivaceous grey, grey-brown at the margin, reverse dark brown. On OA: colonies 77–80 mm diam, circular, slightly raised, margin lobate, lanose, grey, olivaceous grey-brown at the margin, reverse dark grey to nearly black. On PCA: colonies 76–80 mm diam, circular, flat, margin entire, lanose to cobwebby, floccose, grey-brown, olivaceous brown at the margin, reverse dark olivaceous brown. The strain sporulated only on MLA after prolonged incubation (>6 weeks).
Colonies on MLA effuse, hairy, mycelium composed of branched, septate, hyaline to pale brown hyphae 1.5–3 μm diam. Anamorph. Setae 240–330 μm long, 6.5–9 μm wide near the base, arise singly or in groups of 2(–3), erect, straight or flexuous, septate, smooth, dark brown, thick-walled, paler and thinner-walled toward the apex, unbranched, apex pale brown to subhyaline, with a terminal or 1–2 lateral phialidic openings. Conidiophores 67–125(–153) μm long, 3.5–5 μm wide near the base, macronematous, single or arise in fascicles of 3–6 around the base of the setae, unbranched, erect, straight or flexuous, septate, smooth, medium brown, paler toward the apex. Conidiogenous cells 12.5–30 × 3.5–4.5(–5) μm tapering to 1.5–2.5 μm below the collarette, integrated, terminal, mono- or polyphialidic with 1–3 lateral apertures while internally septa can be formed, extending percurrently and sympodially, cylindrical, pale brown, subhyaline at the apex; collarettes 3.5–5 μm wide, 2–2.5(–3) μm deep, funnel-shaped, subhyaline, apical part evanescent with age. Conidia 11.5–14.5 × 2.5–4 μm (mean ± SD = 12.8 ± 0.8 × 3.1 ± 0.3 μm), suballantoid to oblong, slightly curved, asymmetrical, slightly obtuse at the base with an inconspicuous basal scar, aseptate, hyaline, with straight or gently curved setula at each end (4.5–)5–8.5(–10) μm long, inserted terminally at the apex, subterminally at the base, conidia accumulate in slimy whitish fascicles. Teleomorph. Unknown.
Specimen examined: PAPUA NEW GUINEA, Madang Province, Finisterre Range, soil in the tropical rain forest, November 1995, A. Aptroot, (culture CBS 194.96).
Habitat and geographical distribution: This species occurs in soil, on submerged leaves of Pandanus sp. and decaying wood of an unidentified host, and is known from Australasia and Southeast Asia: Papua New Guinea and Thailand ([47,48], this study).
According to GlobalFungi, the identical sequences were found in 55 samples of soil (89%) or root (11%) collected in forest (98%) and freshwater aquatic (2%) habitat in Central America and the Caribbean (30 samples, Puerto Rico, Panama), South America (eight samples, Brazil, French Guyana, Trinidad and Tobago), Asia (12 samples, South China, Papua New Guinea, Thailand, Malaysia), Australia (four samples, Tasmania), Africa (one sample, Madagascar) and North America (one sample, Minnesota), originating from 13 studies. The localities mostly have tropical or temperate climate (MAT avg. 23 °C and MAP avg. 2319 mm).
Notes: Codinaea siamensis has been reported from two collections, which differ in shape and length of conidia and setulae. In the ex-type strain MFLUCC 15-0614, conidia were described as falcate, 15.5–21 × 2.5–4 μm with setulae 7–12 μm long [47], while in the other isolate MFLUCC 16-0371, conidia were allantoid, cylindrical or long fusiform and shorter, 8–17 × 2–5 μm with setulae 1–10 μm long [48]. Conidia observed in the strain CBS 194.96 on MLA correspond to the shape and size of conidia given for the non-type collection of C. siamensis by Tibpromma et al. [48]. The conidiophores formed in culture were longer than those from nature due to the phialides, which frequently elongated percurrently. The ITS sequences of all three strains of C. siamensis are nearly identical and correlate with 99.57% sequence identity, which is equal to a difference of two base pairs between two sequences. The tef1-α sequence identity between MFLUCC 16-0371 and CBS 194.96 was 99.78%; the tef1-α sequence of the ex-type strain was not available.
Codinaea paniculata [46] is similar to C. siamensis, but differs in shorter setae and narrower conidia. Codinaea siamensis is also comparable to C. terminalis, which differs in shorter setae, monophialidic conidiogenous cells and longer conidia in their upper range.
Codinaea terminalis (C.G. Lin & K.D. Hyde) Réblová & Hern.-Restr., comb. nov. MycoBank MB 842200.
Basionym. Dictyochaeta terminalis C.G. Lin & K.D. Hyde, Mycosphere 10: 672. 2019.
For description and illustration, see Lin et al. [30].
Habitat and geographical distribution: Saprobe on decaying leaves, known so far from Asia, China [30]. According to GlobalFungi, the identical sequences were found in two soil samples from the cropland and forest habitats in South China [161,162]. The localities have a temperate climate (MAT avg. 20 °C, MAP avg. 1719 mm).
Notes: Codinaea terminalis is characterized by setae and conidiophores growing together in bundles (C1 morphotype) and is similar to C. assamica and C. siamensis. However, the two latter species differ in having longer setulae and wider conidia. For detailed comparison with other species, see Table S4.
Codinaea vermispora (Z.F. Yu & R.F. Castañeda) Réblová & Hern.-Restr., comb. nov. MycoBank MB 842201.
Basionym. Phialolunulospora vermispora Z.F. Yu & R.F. Castañeda, MycoKeys 76: 23. 2020.
For description and illustration, see Zheng et al. [50].
Habitat and geographical distribution: The species was isolated from submerged leaves of a dicotyledonous plant and is known only from Asia, China [50]. The GlobalFungi database does not contain similar (≥98%) sequences of this species.
Notes: Codinaea vermispora was initially accommodated in the monotypic genus Phialolunulospora [50] and distinguished from Codinaea by vermiform to sigmoid conidia bearing an eccentric basal appendage. Although the authors emphasized the single basal appendage of the conidium, the photograph ([50], Figure 2) shows that the tip of the conidium is strongly attenuated and the transparency and demarcation of this region from the rest of the conidium is identical to the basal appendage. Phylogenetic analysis suggests placement of this species in the strongly supported Codinaea clade. Characteristics of conidia (shape, size and the basal appendage) cause C. vermispora to be well distinguished among other members of the genus.
3.5.2. The Genus Codinaeella
Codinaeella Réblová & Hern.-Restr., gen. nov. MycoBank MB 842000.
Type species. Codinaeella minuta (Tubaki) Réblová & Hern.-Restr.
Etymology: Codinae- and -ella (L) diminutive but here used as a name-forming suffix, referring to fungi morphologically similar to Codinaea.
Description: Colonies on natural substrate effuse, lanose, brown to reddish-brown, composed of conidiophores and setae, mycelium semi-immersed or immersed. Anamorph. Setae present or occasionally absent, grow singly or in small groups from repent hyphae or knots of hyphal cells, erect, straight or flexuous, septate, brown, unbranched, always fertile with a terminal or several lateral phialidic openings, setae rarely absent. Conidiophores macronematous, mononematous, crowded, arise singly or in groups from repent hyphae or knots of hyphal cells, scattered among the setae if present, unbranched, occasionally branched, erect, straight or flexuous, sometimes geniculate, brown, septate, smooth. Conidiogenous cells integrated, terminal on conidiophores or short phialide-bearing branches, or discrete, lateral on conidiophores or 1–2-celled stalks, mono- and polyphialidic, extending percurrently and sympodially, pigmented, often with persistent remnants of the collarettes; collarettes flared, funnel-shaped, the apical part may become soon evanescent. Conidia falcate, cylindrical-fusiform, curved, slightly asymmetrical, tapering toward both ends, slightly truncate at the base with an inconspicuous scar, aseptate, hyaline, with straight or gently curved setula at each end inserted terminally at the apex and subterminally at the base, accumulate in slimy fascicles. Teleomorph. Unknown.
Habitat and geographical distribution: Members of Codinaeella are saprobes, found on decaying bark, wood, woody fruits, leaves, petioles or palm fronds of various plants, but also in soil and living roots, and have a worldwide distribution in Holarctic realm, but also occur in the subtropical and tropical geographic zones of Africa, Asia, Australasia, and South America.
Notes: Two morphotypes were found among Codinaeella species (Figure 8). Species with the predominant morphotype CA1 (e.g., Ca. minuta, Ca. lutea, Ca. parvilobata) form unbranched conidiophores that grow singly or in small groups from repent hyphae or knots of hyphal cells and are usually scattered among longer, darker and thicker-walled unbranched setae. The setae resemble conidiophores; they are always fertile and terminate into a mono- or polyphialide. Although conidiophores are simple on material from nature, in Ca. minuta and Ca. lambertiae conidiophores often branch in culture. The other morphotype CA2 is less widespread and it is represented by Ca. filamentosa only. It is characterized by single, branched conidiophores with a sterile setiform extension and lower fertile part, and they are accompanied by shorter, unbranched conidiophores. Conidiogenous cells are monophialidic, discrete, lateral and also integrated, terminal on stalks or short phialide-bearing branches and shorter conidiophores. The teleomorph of Codinaeella is unknown.
Eight species were accepted in Codinaeella and all were verified with DNA sequences. Several other species closely resemble Codinaeella and although their systematic placement is unknown and molecular data are unavailable, their inclusion in Codinaeella should be considered based on future phylogenetic arguments. Species such as Dictyochaeta gamundiae [163], D. pakhalensis [164], and D. taiwanensis [165] match the CA1 morphotype. Codinaea sinensis [166], Dictyochaetopsis (Di.) elegantissima, Di. intermedia [32] and Di. menisporoides [26] correspond to the CA2 morphotype with branched conidiophores and discrete phialides.
Codinaeella is separated from Codinaea by molecular and morphological characters. The two genera differ in the arrangement of setae (if present) and conidiophores on the natural substrate and partly also in the production of pigments in vitro. The morphology of Codinaea is more complex and consists of four morphotypes, but none of them is comparable with those of Codinaeella. Codinaeella often forms bright yellow, ochre, orange to dark burgundy pigments dispersed in agar, whereas in Codinaea the pigments are rarely formed. A synopsis table with diagnostic features of accepted species of Codinaeella is provided in the Supplementary File: Table S5.
Codinaeella filamentosa (Onofri) Réblová & Hern.-Restr., comb. nov. MycoBank MB 842202. (Figure 21 and Figure 22).

Figure 21.
Codinaeella filamentosa (CBS 147265). (A–E,I–N) Conidiophores (F) conidiogenous cell (G,H,O,P) conidia. Images: (A–H) from nature (I–P) on MLA after 4–8 weeks. Scale bars: (A) 20 μm; (B,I,J) 50 μm; (C–E,K–N) 20 μm; (F–H,O,P) 10 μm.

Figure 22.
Colony morphology of Codinaeella spp. after 4 weeks. (A) Ca. filamentosa CBS 147265 (B) Ca. lambertiae CBS 143419 ex-type (C) Ca. mimusopis CBS 143435 ex-type (D) Ca. pini CBS 138866 ex-type. Scale bar: (A–D) 1 cm.
Basionym. Codinaea filamentosa Onofri, Mycotaxon 14: 120. 1982.
≡ Dictyochaetopsis filamentosa (Onofri) Aramb. & Cabello, Mycotaxon 38: 12. 1990.
Description on the natural substrate: Colonies effuse, grey-brown, composed of conidiophores, mycelium immersed. Anamorph. Setae comparable to the upper layer of branched setiform conidiophores. Conidiophores macronematous, grow singly or in groups of 2–3, erect, straight or flexuous, septate, brown, smooth, form two distinct layers. Conidiophores of the upper layer 252–275 μm long, 3.5–4 μm wide near the base, branched, the upper part of the conidiophore is sterile with a setiform extension, apex obtuse and subhyaline, lower part of the conidiophore is fertile, lateral branches and grow just below the septa, they are either sterile and similar to the main stalk, tapering, up to 166 μm long, or shorter phialide-bearing branches 29.5–51 × 3.5–4 μm. Conidiophores of the lower layer 28–85 μm long, 3–4 μm wide, pale brown, paler toward the apex, unbranched with a terminal phialidic opening, occasionally with discrete phialides. Conidiogenous cells 13–35 × 2.5–3.5 μm tapering to 1.5–2 μm below the collarette, integrated, terminal or discrete, lateral, monophialidic, rarely polyphialidic with one lateral opening, elongating percurrently and sympodially, cylindrical, pale brown, subhyaline toward the apex; collarettes ca. 3 μm wide, 1.5–2 μm deep, funnel-shaped, hyaline. Conidia (13.5–)14.5–17.5(–18) × 2–2.5 (mean ± SD = 16 ± 1.6 × 2.5 ± 0.2 μm), falcate, tapering toward both ends, aseptate, hyaline, with a straight or gently curved setula at each end, 5–8 μm long, inserted terminally at the apex, subterminally at the base, conidia accumulate in slimy whitish fascicles.
Culture characteristics: On CMD: colonies 35–38 mm diam, circular, flat, margin entire, velvety, later mucoid and smooth, whitish-brown, beige toward the margin, reverse beige with a dark brown zone. On MLA: colonies 25–27 mm diam, circular, flat, raised margin, margin entire to weakly undulate, mucoid-waxy to cobwebby, lanose at the margin, colony centre dark burgundy-brown, whitish-grey to grey at the margin with a dark ochre outer zone, dark burgundy (centre) and pale ochre pigment (margin) diffusing into agar, reverse dark burgundy to black. On OA: colonies 50–53 mm diam, circular, flat, slightly raised, margin entire, mucoid, velvety to cobwebby centrally and at the margin, zonate, irregularly dark brown at the centre with beige zones of sparse growth, reverse brown. On PCA: colonies 40–42 mm diam, circular, flat, margin entire, cobwebby, slightly funiculose becoming mucoid, zonate, beige-brown, isabelline at the margin, reverse of the same colors. Sporulation was sparse on MLA, OA, PCA, absent on CMD.
Colonies on MLA effuse, mycelium composed of branched, septate, pale brown hyphae 2–2.5 μm diam. Conidiophores 160–493 μm long, 2.5–3.5 μm wide near the base, tapering upwards, sometimes with a sterile, dark brown, setiform extension up to 377 μm long, apex narrowly rounded, erect, straight or flexuous, septate, smooth, medium brown, simple or branched; phialide-bearing branches arise in the lower part of the conidiophore, secondary and tertiary branches formed frequently, parallel, extending upwards percurrently, slightly curved downwards at the apical part. Conidiogenous cells 18–42 × 3–3.5 μm tapering to 1.5–2 μm below the collarette, monophialidic, pale brown to subhyaline; collarettes 3–4 μm wide, 1.5–2.5 μm deep, subhyaline, funnel-shaped, apical part often evanescent. Conidia similar to those from nature, 13.5–17 × 2–3 μm (mean ± SD = 15 ± 0.9 × 2.4 ± 0.3 μm), falcate, setulae 5.5–8.5 μm long, accumulate in slimy whitish fascicles.
Specimen examined: USA, Louisiana, Baton Rouge, Burden Plantation, on buried leaves of Quercus sp., 11 February 2002, K.A. Seifert K.A.S. 1504 (culture CBS 147265).
Habitat and geographical distribution: A saprobe on leaf litter of Anthonotha fragrans, Calpocalyx brevibracteatus, Chrysophyllum taiense, Quercus sp. and other unknown hosts, known from Africa and North America: Ivory Coast and the USA, Louisiana ([32,35], this study).
According to GlobalFungi, this species was found in six soil samples from forest habitat in Eastern North America in New York, Massachusetts [119,167]. The sites have temperate or humid continental climate (MAT avg. 10 °C, MAP avg. 1238 mm). In addition, Ca. filamentosa is identical with Ca. minuta in the ITS1 barcode. Thus, only the ITS2 region was used to study its biogeography.
Notes: On the natural substrate, Ca. filamentosa forms two kinds of conidiophores, of which the longer are branched and have a sterile setiform extension; the branches are also sterile and similar to the main stalk. These longer conidiophores can be considered equivalent to the setae (although, apically always fertile) observed in other species of Codinaeella, such as Ca. lutea, Ca. mimusopis, Ca. minuta and Ca. parvilobata. Codinaeella filamentosa has a distinctive characteristic of colony on MLA. The flat, central part of the colony is dark burgundy-brown, mucoid becoming cobwebby in older cultures. Aerial mycelium is usually confined to the periphery where it is abundant, lanose and forms a raised, grey margin. During the analysis of the secondary metabolites, we identified naphthoquinones bioactive compounds produced from the central pigmented part of the colony (A. Čmoková et al., in preparation).
Four other species, such as C. sinensis, Dictyochaetopsis elegantissima, Di. Intermedia, and Di. menisporoides, resemble Ca. filamentosa in having discrete, lateral phialides, falcate, aseptate, hyaline conidia with setulae and sometimes branched conidiophores. Sometimes longer conidiophores are accompanied by shorter simple conidiophores or stalked phialides. Dictyochaetopsis elegantissima differs from Ca. filamentosa in conidia with bifid setulae at each end [32]. Dictyochaetopsis intermedia differs from Ca. filamentosa in having conidiophores with a terminal phialidic opening and wider conidia. Codinaea sinensis has unbranched conidiophores and shorter conidia [166] compared to Ca. filamentosa. Dictyochaetopsis menisporoides differs from Ca. filamentosa in polyphialidic conidiogenous cells, unbranched conidiophores with mostly sessile phialides, sometimes formed on branches [26]. The systematic placement of these species is unknown; the living cultures or molecular data are not available.
Codinaeella lambertiae (Crous) Réblová & Hern.-Restr., comb. nov. MycoBank MB 842203. (Figure 22 and Figure 23).

Figure 23.
Codinaeella lamberiae (CBS 143419 ex-type). (A–D) Conidiophores (E,F) conidia. Images: (A–D) on OA after 4 weeks. Scale bars: (A) 50 μm; (B–F) 10 μm.
Basionym. Codinaea lambertiae Crous, Persoonia 39: 399. 2017.
Culture characteristics: On CMD: colonies 62–64 mm diam, circular, flat, margin entire, mucoid to cobwebby, brown centrally, beige with irregular brown spots, reverse of the same color. On MLA: colonies 57–58 mm diam, circular, convex, margin entire, sparsely lanose, mucoid at the margin, zonate, furrowed, white-ochre with irregular dark brown to orange-brown intermediate zones, with an isabelline outer zone of submerge growth, reverse amber with dark brown rings. On OA: colonies 60–62 mm diam, circular, raised, margin entire, velvety to cobwebby, floccose, locally mucoid with a sparse growth, pink-brown, whitish-brown toward the margin sometimes with orange-brown outer zone, light ochre-pink pigment diffusing into the agar, reverse ochre-yellow to yellow-orange. On PCA: colonies 59–60 mm diam, circular, flat, margin entire, cobwebby to mucoid, zonate, beige, locally olivaceous beige at the margin, reverse beige. Sporulation was moderate on MLA, OA, and PCA, absent on CMD.
Colonies on OA effuse, mycelium composed of branched, septate, hyaline to pale brown hyphae 1.5–2.5 μm diam. Anamorph. Setae absent. Conidiophores 128–362 μm long, 2.5–3 μm wide near the base, usually tapering toward the base, macronematous, single, simple or branched, erect, septate, straight or flexuous, geniculate toward the apex due to numerous lateral phialidic openings, smooth, pale brown. Conidiogenous cells 19–34 × 3–3.5 μm tapering to 1.5–2(–2.5) μm below the collarette, integrated, terminal, mono- and polyphialidic with 1–6 lateral openings while internally septa can be formed, extending percurrently and sympodially, cylindrical, pale brown; collarettes 4–5.5 × 2–3(–4) μm, funnel-shaped, pale brown to subhyaline. Conidia 11.5–14.5 × 2.5–3 μm, falcate, tapering toward both ends, slightly truncate at the basal end with an inconspicuous scar, aseptate, hyaline, with a straight or gently curved setula at each end, 4–6.5 μm long, inserted terminally at the apex, subterminally at the base, accumulate in slimy whitish fascicles. Teleomorph. Unknown.
Specimen examined: AUSTRALIA, New South Wales, Fitzroy Falls, Morton National Park, on leaves of Lambertia formosa, 26 November 2016, P.W. Crous (culture ex-type CBS 143419).
Habitat and geographical distribution: Saprobe on fallen leaves of Lambertia formosa, known from Australia only [10]. According to GlobalFungi, this species was found mostly in Southeast Australia and Tasmania in 14 samples, mostly in soil in forest or woodland environments [117,168,169]. A single soil sample originates from Asia (East China) from a cropland biome. The sites have temperate or humid continental climate (MAT avg. °C, MAP avg. 1091 mm).
Notes: When grown on OA, the conidiophores of Ca. lambertiae (CBS 143419) branch; the branches are fertile and curved upwards. Similar branching pattern was observed in Ca. filamentosa and Ca. minuta (this study). Phialides extend percurrently and later also sympodially and the upper part of the conidiophore acquires a slightly geniculate appearance. In the protologue of Ca. lambertiae [10], the conidiophores were described simple, conidiogenous cells monophialidic, rarely with a lateral phialidic aperture and the conidia were given longer ((13–)14–15(–18) × (2.5)–3 μm. Because of these differences we present a description of Ca. lambertiae on OA.
Codinaeella lambertiae is similar to Ca. parvilobata but differs in having slightly longer and wider conidia with shorter setulae. While Ca. lambertiae mainly occurs in Australasia, Ca. parvilobata has a wide range of distribution.

Figure 24.
Codinaeella lutea. (A–F,N,O) Conidiophores (G–J,P,Q) conidia (K–M) colonies. Images: (A–J) from nature (K,M–Q) on stems of U. dioica on CMA after 8 weeks (L) on OA after 4 weeks (A–L) from CBS 146618 ex-type (M–Q) from CBS 624.77. Scale bars: (A–F,O) 20 μm; (K,L) 1 cm; (N,P,Q) 10 μm.

Figure 25.
Colony morphology of Codinaeella lutea after 4 weeks. (A) CBS 146618 ex-type (B) CBS 624.77 (C) ICMP 14613 (D) ICMP 15544. Scale bar: (A–D) 1 cm.
Typification: CZECH REPUBLIC, South Bohemian region, Novohradské hory Mts., Horní Stropnice, Bedřichovský potok Natural Monument, on decaying cupule of Quercus sp., 5 October 2018, M. Réblová M.R. 3982 (holotype PRA-20986, culture ex-type CBS 146618).
Etymology: Luteus (L) yellow, referring to the yellow pigment diffusing into agar, and staining conidial masses and aerial mycelium in vitro.
Description on the natural substrate: Colonies effuse, grey-brown, composed of setae and conidiophores, mycelium semi-immersed. Anamorph. Setae 125–250 μm long, (3.5–)4.5–5.5 μm wide near the swollen base, grow singly or in groups, erect, straight or flexuous, septate, smooth, dark brown and thick-walled, paler and thinner-walled toward the apex, unbranched, always fertile, apex pale brown to subhyaline with a single terminal or 1–5 lateral phialidic openings. Conidiophores 39–102 μm long, 3.5–4.5 μm wide near the base, macronematous, crowded, arise singly or in groups of 2–3, scattered among the setae, unbranched, erect, straight or flexuous, slightly geniculate in the apical part, septate, smooth, pale to medium brown, paler toward the apex. Conidiogenous cells 19.5–29(–32) × 3.5–4.5 μm tapering to 1.5–2 μm below the collarette, integrated, terminal, mono- or polyphialidic with 2–8 lateral openings while internally septa can be formed, extending sympodially, cylindrical, slightly swollen below the collarette, pale brown, subhyaline at the apex, usually bearing persistent remnants of the collarettes; collarettes 3–3.5 μm wide, 2–2.5 μm deep, funnel-shaped, subhyaline to pale brown, the apical part soon evanescent. Conidia 12.5–17.5 × 2–2.5(–3) μm (mean ± SD = 15.6 ± 1.4 × 2.6 ± 0.2 μm), falcate, asymmetrical, tapering toward both ends, slightly truncate at the base with an inconspicuous basal scar, aseptate, hyaline, with straight or gently curved setula at each end (4.5–)5–8.5(–10) μm long, inserted terminally at the apex, subterminally at the base, conidia accumulate in slimy whitish fascicles. Teleomorph. Unknown.
Culture characteristics: On CMD: colonies 35–40 mm diam, circular, flat, margin entire to fimbriate, sparsely lanose, somewhat funiculose, mucoid toward the periphery, whitish-beige centrally, pale cinnamon when mucoid, beige to isabelline toward the margin, pale yellow-gold pigment diffusing into agar, reverse cinnamon. On MLA: colonies 15–18 mm diam, circular, raised, margin entire to lobate, velvety-lanose becoming mucoid-waxy, glossy, furrowed, pink-beige, apricot to cinnamon with remnants of yellow to white-yellow aerial mycelium at the inoculation block, sometimes with a dark grey to dark burgundy outer zone when mucoid and beige-brown lanose margin, diffusing apricot pigment into the agar, more intense color at the margin, reverse ochre, apricot to cinnamon. On OA: colonies 60–65 mm, circular, raised, margin entire, velvety-lanose, floccose, occasionally partially mucoid, furrowed, sometimes ridges with small cracks, white to beige-brown centrally, dark brown in the mucoid part, with a yellow ring or irregular yellow patches of aerial hyphae with numerous yellow exudates, sometimes yellow to pale ochre pigment diffusing locally into agar, reverse orange-brown. On PCA: colonies 69–73 mm diam, circular, raised, margin entire to fimbriate, lanose, floccose, white-beige, sometimes mucoid and cinnamon centrally, with irregular yellow tufts of aerial mycelium, beige toward the margin, pale ochre pigment diffusing into agar, reverse olivaceous grey-brown to cinnamon. Sporulation was sparse on PCA, absent on CMD, MLA, and OA.
Colonies on CMA with U. dioica stems effuse, mycelium composed of branched, septate, hyaline to pale brown hyphae 1–2 μm diam. Anamorph. Setae absent, conidiophores, conidiogenous cells, and conidia similar to those from nature. Conidiophores 36–83 μm long, 2–4 μm wide above the base, usually tapering toward the swollen base, unbranched, erect, septate, smooth, pale brown to subhyaline, sometimes reduced to single conidiogenous cells. Conidiogenous cells 16–32 × 3.5–4.5 μm tapering to 1.5–2.5 μm below the collarette, integrated, terminal, mono-, occasionally polyphialidic with 1–2 lateral openings, subcylindrical, extending percurrently and sympodially, pale brown to subhyaline; collarettes 3.5–5 μm wide, 1.5–2.5 μm deep, funnel-shaped. Conidia 14.5–17 × 2–3 μm (mean ± SD = 15.8 ± 0.8 × 2.6 ± 0.3 μm), falcate, hyaline, aseptate, setulae 4–7.5 μm long, accumulate in slimy whitish or yellow fascicles. Teleomorph. Unknown.
Other specimens examined: NEW ZEALAND, Canterbury region, Christchurch, Christchurch Botanical Gardens, on a dead leaf of Quercus ilex, 2 September 2002, J.A. Cooper JAC8343 (PDD 80130, culture ICMP 14613). NEW ZEALAND, Tasman region, Murchison, Dough Boy Track, on dead cupule of Quercus sp., 15 May 2004, J.A. Cooper JAC9057 (PDD 80612, culture ICMP 15540). THE NETHERLANDS, Utrecht, Fort Rijnauwen, ingang (1b), on cupule of Quercus robur, 22 October 1977, W. Gams (CBS H-746, culture CBS 624.77).
Habitat and geographical distribution: Codinaeella lutea is a saprobe on decaying leaves and woody fruits of Quercus ilex, Q. robur, Quercus sp. And other unknown host. It is known from Australasia, Europe, and Southeast Asia: China, Czech Republic, New Zealand and The Netherlands.
According to GlobalFungi, the identical sequences were found in 53 samples of roots (72%), soils (26%), or water (2%) originating mostly from forest (81%) and grassland (13%) habitats in Europe (49 samples, Belgium Denmark, Wales) [170,171,172], Asia (3 samples, Iran) [115]. It was also found in the single water sample from North America (North Carolina) [173]. The sites have the temperate climate (MAT avg. 11 °C, MAP avg. 85 mm).
Notes: The four strains of Ca. lutea examined in this study produce yellow pigment, which diffuses into the agar and also stains aerial mycelium in vitro. This character is conspicuous in the ex-type strain on OA (Figure 24K,L). In other isolates the yellow-colored hyphae formed sparsely, either on MLA or PCA (Figure 25). In addition, yellow conidial masses formed when grown on Urtica stems on CMA (Figure 24M). The four isolates of Ca. lutea from Asia, Europe and New Zealand have identical ITS sequences, although their tef1-α sequences show certain variability corresponding to 99.35–99.78% sequence identity; the tef1-α sequence of the Asian isolate is unavailable.
Codinaeella lutea resembles Ca. minuta, but differs in longer setae, narrower conidia, bright yellow color of the conidial masses in vitro and especially colony characteristics in vitro including the color of the pigment released into the agar. The color ranges from yellow to pale ochre, yellow-gold to apricot in Ca. lutea, but it is usually ochre, deep orange to bright carrot orange in Ca. minuta. On MLA, the growth of Ca. lutea is considerably slower (15–18 mm) than that of Ca. minuta (42–45 mm). Codinaeella parvilobata also bears a close resemblance to Ca. lutea, but differs in shorter setae, shorter conidia and colony characteristics. For a detailed comparison of these two species, see notes to Ca. parvilobata. Dictyochaeta pakhalensis [164] resembles Ca. lutea, but differs in shorter and narrower conidia. In the present phylogeny, Ca. lutea, Ca. minuta and Ca. parvilobata form distinct lineages. Molecular data and culture of D. pakhalensis are unavailable.
Codinaeella mimusopis (Crous & M.J. Wingf.) Réblová & Hern.-Restr., comb. nov. MycoBank MB 842205. (Figure 22 and Figure 26).

Figure 26.
Codinaeella mimusopis (CBS 143435 ex-type). (A,B) Colonies (C,F–J) conidiophores (D,E) conidia. Images: (A) on a pine needle on SNA after 8 weeks (B) on a stem of U. dioica on CMA after 8 weeks. Scale bars: (C,F–I) 20 μm; (D,E) 5 μm; (J) 10 μm.
Basionym. Dictyochaeta mimusopis Crous & M.J. Wingf., Fungal Syst. Evol. 1: 185. 2018.
For description and additional illustrations, see Crous et al. [82].
Culture characteristics: On CMD: colonies 25–28 mm diam, circular, flat, margin entire, lanose on the inoculation block, mucoid, zonate, whitish becoming pale olivaceous brown, isabelline toward the periphery, reverse of similar colors. On MLA: colonies 38–39 mm diam, circular, flat, raised margin, margin entire, velvety-lanose, partly mucoid, whitish, pale olivaceous brown at the margin, reverse zonate, pale brown, cinnamon at the margin. On OA: colonies 61–63 mm diam, circular, flat, margin entire, lanose becoming mucoid, aerial mycelium restricted to the centre and margin of the colony, brown, olivaceous grey to white-grey centrally and at the margin, reverse olivaceous brown. PCA: colonies 57–58 mm diam, circular, flat, margin entire, lanose at the inoculation block, mucoid and smooth toward the periphery, zonate, whitish centrally, cinnamon, beige toward the margin, reverse brown. Sporulation was moderate on MLA and OA, absent on CMD and PCA.
Specimen examined: SOUTH AFRICA, Eastern Cape Province, Haga Haga, on leaves of Mimusopis caffra, December 2010, M.J. Wingfield (culture ex-type CBS 143435).
Habitat and geographical distribution: On leaves of Mimusopis caffra known so far from Africa, South Africa [82]. The GlobalFungi database does not contain similar (≥97%) sequences of this species.
Notes: Our observations based on the ex-type strain match the protologue in all details, except for the conidiophores. Two kinds of conidiophores were observed on sterile stems of Urtica on CMA. Longer, setiform conidiophores up to 245 μm long were accompanied by shorter conidiophores 38–130 μm vs. conidiophores 40–150 μm [82]. However, the longer conidiophores were not different from the shorter ones. They have almost the same color, width near the base and wall thickness. They could be considered equivalent to the setae that form regularly in other species of Codinaeella in nature. The phialides are terminal, elongating percurrently and sympodially to form 1–3 lateral openings. Pigments diffusing from the colony into agar were not produced on any of the used media. Conidia formed on Urtica stems on CMA accumulated in yellow slimy fascicles (Figure 26A,B), while those formed on pine needles on SNA and other media were white (not shown). Codinaeella mimusopis resembles Ca. lambertiae [10], but differs in shorter conidiophores and longer conidia [82].
Codinaeella minuta (Tubaki) Réblová & Hern.-Restr., comb. nov. MycoBank MB 842207 (Figure 27 and Figure 28).

Figure 27.
Codinaeella minuta. (A–D,I–M) Conidiophores (E,N) conidia (F–H) colonies. Images: (A–E) from nature (F–H) on MLA after 4 weeks (I–N) on a stem of U. dioica on CMA after 4–8 week (A–E) from CBS 145099 (F) from CBS 146619 (G,H,L,M) from DAOM 148141 (I–K,N) from CBS 146619. Scale bars: (A–E,J–N) 10 μm; (F–H) 1 cm; (I) 20 μm.

Figure 28.
Colony morphology of Codinaeella minuta after 4 weeks. (A) CBS 966.69 (B) CBS 146621 (C) CBS 115959 (D) DAOM 148141 (E) ATCC 20960. Scale bar: (A–E) 1 cm.
Basionym. Menispora minuta Tubaki, J. Hattori bot. Lab. 20: 166. 1958.
Description on the natural substrate: Colonies effuse, grey-brown to olivaceous grey, composed of setae and conidiophores, mycelium semi-immersed or immersed. Anamorph. Setae 123–184 μm long, 3–4.5 μm wide near the base, crowded, grow singly or in groups of two, erect, straight or flexuous, septate, smooth, dark brown, paler and thinner-walled toward the apex, unbranched, apex pale brown to subhyaline with a terminal or 1–3 lateral phialidic openings. Conidiophores 32–108 μm long, 3–4 μm wide near the base, macronematous, crowded, arise singly or in groups of 2–3, scattered among the setae, sometimes aggregate in loose columns, unbranched, erect, straight or flexuous, septate, smooth, pale brown, subhyaline toward the apex, sometimes reduced to single conidiogenous cells. Conidiogenous cells 20.5–35 × 2.5–3.5 μm tapering to 1.5–2 μm below the collarette, integrated, terminal, mono- and polyphialidic with 1–5 lateral openings while internally septa can be formed, extending percurrently and sympodially, cylindrical, pale brown, subhyaline toward the apex, usually bearing persistent remnants of the collarettes; collarettes 3–4 μm wide, ca. 2 μm deep, funnel-shaped, subhyaline, the apical part soon evanescent. Conidia 13–18 × 2.5–3.5 μm (mean ± SD = 16.2 ± 1.1 × 2.8 ± 0.3 μm), falcate, tapering toward both ends, slightly truncate at the base with an inconspicuous scar, aseptate, hyaline, with a straight or gently curved setula at each end, 5.5–8.5(–10) μm long, inserted terminally at the apex, subterminally at the base, conidia accumulate in slimy whitish fascicles. Teleomorph. Unknown.
Culture characteristics: On CMD: colonies 61–65 mm diam, circular, flat, margin entire, lanose, floccose, cobwebby toward the margin, becoming mucoid, varying in color due to the absence of aerial mycelium, beige brown to pale banana yellow, occasionally orange with a yellow-gold margin, pale ochre to orange pigment diffusing into agar, reverse beige, ochre-beige to orange. On MLA: colonies 42–45 mm diam, circular, flat, margin entire to fimbriate, lanose, floccose becoming mucoid, grey-brown to dark brown when aerial mycelium is present, deep carrot orange to dull orange brown with orange-gold margin when mucoid, pale orange pigment diffusing into agar, reverse orange to dark amber. On OA: colonies 58–63 mm diam, circular, raised, margin entire, sparsely lanose becoming mucoid, beige-grey to dark grey toward the margin when aerial mycelium is present, orange with tawny margin when mucoid, sometimes orange to ochre pigment diffusing into agar, reverse dark grey-brown or amber. On PCA: colonies 70–73 mm diam, circular, flat, margin entire to fimbriate, sparsely lanose becoming mucoid, grey-brown, tawny or orange with olivaceous brown margin on mucoid spots, pale orange pigment diffusing into agar, reverse dark olivaceous brown to amber. Sporulation was abundant on all media.
Description on CMA with U. dioica stems. Colonies effuse, mycelium composed of branched, septate, hyaline to subhyaline hyphae 1.5–3 μm diam. Anamorph. Setae absent, conidiophores, conidiogenous cells, and conidia similar to those from nature. Conidiophores 46–297(–450) μm long, 3–3.5 μm wide near the base, branched or unbranched, erect, septate, smooth, pale to medium brown. Conidiogenous cells 13.5–32.5 × 3.5–4.5 μm tapering to 1.5–2 μm below the collarette, integrated, terminal, extending percurrently with 1–10 proliferations, and sympodially with 1–4 lateral openings, cylindrical, pale brown to subhyaline, with persistent remnants of the collarettes; collarettes 3.5–5 μm wide, 1.5–2.5 μm deep, funnel-shaped, dark brown becoming hyaline upon aging. Conidia 11.5–17.5(–18) × 2–3 μm (mean ± SD = 14.9 ± 1.1 × 2.5 ± 0.4 μm), falcate, setulae 4.5–7 μm long, accumulate in slimy whitish fascicles. Teleomorph. Unknown.
Specimens examined: CZECH REPUBLIC, Central Bohemian region, Úvaly, Škvorecká obora-Králičina Nature park, on decaying acorn of Quercus sp., 21 April 2018, M. Réblová M.R. 3944 (PRA-20991, culture CBS 146619); Ibid., M.R. 3946 (PRA-20992, culture CBS 146620); Ibid., M.R. 3948 (PRA-20993, culture CBS 146621); Ibid., South Bohemian region, Novohradské hory Mts., Horní Stropnice, Bedřichovský potok Natural Monument, on decaying acorn of Quercus sp., 5 October 2018, M. Réblová M.R. 3983 (PRA-20990). FRANCE, Ariège, Pyrenées Mts., Rimont, La Maille brook, alt. 550 m, on decaying acorn of Quercus sp., 28 May 2018 (incubated for 2 weeks in a damp chamber), J. Fournier M.R. 3951 (PRA-20994, culture CBS 145099); Ibid., M.R. 3952 (PRA-20995, culture CBS 145100). ITALY, on branch of Quercus suber, F. Marras (culture CBS 115959). JAPAN, Chiba Prefecture, Kiyozumi, on dead leaves of Lithocarpus edulis, Aug. 1954, K. Tubaki (authentic strain of Menispora minuta MUCL 9903 = MUCL 15759 = CBS 280.59). THE NETHERLANDS, Gelderland province, Rheden, National Park Veluwezoom, on decaying acorn of Quercus sp., 6 September 1969, V. Holubová-Jechová (CBS 966.69); Ibid., Utrecht province, Utrecht, Utrecht Science park near Westerdijk Fungal Biodiversity Institute, on a fallen leaf of Quercus sp., August 2018, M. Hernández-Restrepo M.H.R. 18063 (culture CBS 147518). USA, Louisiana, New Orleans, Audobon Park, on leaf litter of Quercus virginiana, 19 April 1974, R. Bandoni & K.A. Pirozynski 6120 B/K.A.S. 7210 (culture DAOM 148141). USA, Texas, Houston, E. & A. Taylor Park, on a dead leaf of Quercus virginiana, date unknown, G. Bills (culture TTI-0830). USA, West Virginia, Fayette Co., Fayette Station, hardwood leaf litter, date unknown, collector unknown (culture ATCC 20960 = MF5247 = Mycosearch 1673).
Habitat and geographical distribution: Codinaeella minuta is a saprobe on fallen leaves and woody fruits of Fagus sylvatica, Lithocarpus edulis, Quercus petraea, Q. robur, Q. virginiana, Quercus sp., and other unknown hosts. It occasionally occurs on bark and wood of Q. suber. It is known from Asia, Europe, and North America: the Czech Republic, France, Japan, Italy, The Netherlands, Slovak Republic and USA ([26,174], this study).
According to GlobalFungi, the identical sequences were found in 20 samples of soil (80%), litter (15%) and root (5%) from forest (95%) or grassland (5%) habitats in Europe (60% of all samples, Denmark, France, Hungary, Poland, Sweden), Asia (15%, Iran), and in western part of North America (25%, Florida, Michigan). The samples originate from eight studies and the locations have temperate or humid continental climate (MAT avg. 13 °C, MAP avg. 864 mm). Codinaeella minuta is identical with Ca. filamentosa in ITS1 barcode. Thus, only ITS2 region was used to study C. minuta biogeography.
Notes: This species was described as Menispora minuta from dead leaves of Lithocarpus edulis, an evergreen tree native to Japan [174]. Although Tubaki [174] characterized this species in culture only, we update its description based on observations from nature based on the newly acquired material. Among members of Codinaeella, Ca. minuta is well distinguished by the production of deep orange pigment on nutrient media, especially on MLA and OA (Figure 28, Supplementary Files: Figures S3 and S4). Codinaeella minuta is similar to Ca. lutea, but it differs in shorter setae, slightly wider conidia and colony characteristics in vitro. For a detailed comparison, see notes to Ca. lutea.
Interestingly, majority of the strains of Ca. minuta included in this study were originally identified as Codinaea simplex [2]. It is possible that the concept of the latter species has been misinterpreted in the literature. Our suspicions were confirmed by the revision of the isotype of C. simplex (DAOM 96020g), which revealed that Ca. minuta and C. simplex are two different species. Codinaea simplex forms a single layer of conidiophores up to 115 μm long (usually 35–68 µm); conidiophores are several-septate but often they are reduced to conidiogenous cells with only 1–2 supporting cells. On the other hand, the conidiophores of Ca. minuta vary in height and form two layers, setiform conidiophores 123–184 μm long referred to as setae and shorter ones up to 108 μm long. At maturity, setae and conidiophores of Ca. minuta may cluster in loose columns, which are partly shown on Figure 27B; they adhere to each other and are difficult to separate. Holubová-Jechová [26] reported a collection of C. simplex from the Czech Republic with longer conidiophores 30–155(–230) μm adhering in loose columns similar to synnemata. It is likely that this collection represents in fact Ca. minuta, which is fairly common in the Czech Republic. Conidiophores of different heights were also observed in culture, in strains growing on stems of U. dioica on CMA. Solitary, dichotomously branched conidiophores occur frequently in vitro when growing on agar medium. Our observations agree with those of Tubaki [174]. Using morphological and geographical data from GlobalFungi, the systematic placement of C. simplex was revaluated and the species was transferred to Tainosphaeria in this study.
We observed undescribed variability in colony characteristics in strains of Ca. minuta originating from different geographic regions (Figures S3 and S4). The presence of orange pigment diffusing into the agar is widespread among strains, and it is most pronounced on MLA and OA. The color of the pigment differs in intensity and ranges from bright carrot orange or deep orange to yellow-orange, pale orange-brown to dark ochre. We observed that colony color is correlated with the development of aerial mycelium. Both isolates from The Netherlands, CBS 966.69 and CBS 147518, abundantly produced deep orange pigment on all media. In these isolates, aerial mycelium was scarce, restricted to the periphery or central zone of the colonies, soon became mucoid and the surface of the colonies turned deep orange (Figure S3). In other strains the aerial mycelium was more or less abundant, lanose, locally mucoid, and only then the mucoid, bright orange-colored part of the colony with the diffusing pigment was visible. The development of orange pigment and lack of aerial mycelium differed even within a single strain and were found to be correlated with the volume of the nutrient medium and number of colonies on one plate; the pigment production was pronounced when the colonies grew singly on 10 cm Petri dish (Figure 27F) vs. in a triple on the 6 cm Petri dish (Figure 28). Although pigment was sparse or absent on all media in the North American strain DAOM 148141 from the frontal view (Figure 28D), it formed just below the colony, causing the orange coloration of the reverse side (Figure 27G,H).
In the phylogeny based on ITS-28S-tef1-α sequences, Ca. minuta is represented by 12 strains from Asia, Europe, and North America. While 11 of these strains were grouped with the ex-type strain CBS 298.61 in a monophyletic, well-supported clade, the strain ATCC 20960 clustered at the base of Ca. minuta clade and the relationship was not statistically supported. All 12 strains of Ca. minuta have identical ITS1 and ITS2 sequences, except for the isolate ATCC 20960, which differs in one base pair in the ITS1. More significant sequence divergence was observed in the tef1-α gene. However, the strain ATCC 20960 is well comparable with other strains of Ca. minuta in morphology of conidiophores, conidiogenous cells and conidia in culture, colony characteristics and production of orange pigment. In material collected in different countries the size of conidia of Ca. minuta in vitro was comparable: 13–15.5(–16) × 2–3 μm (Czech Republic), 13–16 × 2–3 μm (France), 10–16 × 2–3 μm (Japan, Tubaki 1958), 11.5–14 × 2–3 μm (USA, DAOM 148141) and 13–16.5(–17) × 2–3 μm (USA, TTI-0830). However, their conidia from nature are slightly larger, 13–18 × 2.5–3.5 μm (Czech Republic, France). In culture, conidia of the strain ATCC 20960 were slightly longer at their upper limit, 13.5–17.5(–18) × 2–3 μm (mean ± SD = 15.4 ± 1.1 × 2.4 ± 0.3 μm) with setulae 4.5–7.5 μm long. Wild type of ATCC 20960 is unknown; the herbarium specimen from which the strain was isolated is not available for study.
Despite the variability of ATCC 20960 in the tef1-α gene, its morphology and geographic distribution based on ITS analysis of environmental sequences compares well with Ca. minuta. Therefore, we prefer to keep this strain as a representative of this species. The strain ATCC 20960 is of a particular interest, because it has been studied in detail in terms of bioactive compounds and their potential in disease treatment. It produces β-1,3-d-glucan synthesis inhibitor with antifungal and anti-Pneumocystis activity [175,176].
Codinaeella parvilobata Réblová & Hern.-Restr., sp. nov. MycoBank MB 842208. (Figure 29 and Figure 30).

Figure 29.
Codinaeella parvilobata (CBS 144536 ex-type). (A–G) Conidiophores (H,I) conidia (J–N) conidiophores (O,P) conidia. Images: (A–I) from natural substrate (J–P) on MLA after 4 weeks. Scale bars: (A–D) 20 μm; (E–P) 10 μm.

Figure 30.
Colony morphology of Codinaeella parvilobata after 4 weeks. (A) CBS 144536 ex-type (B) CBS 144792 (C) CBS 144658 (D) MUCL 28054. Scale bar: (A–D) 1 cm.
Etymology: Parvus (L) small, lobus (L) lobe, referring to small lobes at the base of conidiophores in vitro.
Typification: CZECH REPUBLIC, South Bohemian region, Novohradské hory Mts., Dobrá voda, Hojná voda National nature monument, on decaying cupule of Fagus sylvatica, 29 September 2017, M. Réblová M.R. 3900 (PRA-20987 holotype, culture ex-type CBS 144536).
Description on the natural substrate: Colonies effuse, brown-grey, composed of setae and conidiophores, mycelium semi-immersed. Anamorph. Setae 140–205 μm long, 4.5–5.5 μm wide near the swollen base, crowded, arise singly or in groups, erect, straight, flexuous or bent, septate, smooth, dark brown and thick-walled, paler and thinner-walled toward the apex, simple, apex pale brown with a terminal or 1–6 lateral phialidic openings, sometimes apex remains sterile, obtuse and hyaline. Conidiophores 40–117 μm long, 3–4.5(–5) μm wide near the base, macronematous, crowded, arise singly or in groups, scattered among the setae, unbranched, erect, straight, usually flexuous or bent, geniculate to undulate toward the apex, septate, smooth, mid to pale brown, paler toward the tip. Conidiogenous cells 9–34.5 μm × 3.5–4.5 μm tapering to 1–2 μm below the collarette, integrated, terminal, monophialidic, or polyphialidic with 1–7 lateral openings while internally septa can be formed, extending percurrently and sympodially, cylindrical, pale brown, subhyaline at the apex, usually with persistent remnants of the collarettes; collarette 2–2.5 μm wide, 1.5(–2) μm deep, funnel-shaped, hyaline, the apical part soon evanescent. Conidia 10.5–13.5 μm × 2–2.5(–3) μm (mean ± SD = 12.4 ± 0.8 μm × 2.0 ± 0.2 μm), falcate, tapering toward both ends, slightly truncate at the base with an inconspicuous scar, aseptate, hyaline, with a straight or gently curved setula at each end, 6.5–9 μm long, inserted terminally at the apex, subterminally at the base, conidia accumulate in slimy whitish fascicles. Teleomorph. Unknown.
Culture characteristics: On CMD: colonies 40–43 mm diam, circular, flat, convex centrally, margin fimbriate, velvety-lanose, mucoid toward the periphery, whitish, beige to beige-grey, ochre-beige to brown when mucoid, isabelline toward the margin, reverse isabelline. On MLA: colonies 32–36 mm diam, circular, flat, convex centrally, margin fimbriate, lanose becoming mucoid, wrinkled, whitish grey, buff yellow, cinnamon to olivaceous brown when mucoid, pale yellow to pale ochre pigment diffusing into agar, sometimes the pigment is missing, reverse dark ivory to ochre, dark brown margin. On OA: colonies 78–80 mm diam, circular, flat, convex centrally, margin entire, velvety-lanose becoming mucoid, zonate, smoke grey, cinnamon to dark olivaceous brown when mucoid, aerial hyphae with colorless exudates, reverse amber to dark brown. On PCA: colonies 46–50 mm diam, circular, flat, convex centrally, margin entire to fimbriate, velvety-lanose, somewhat funiculose at the centre, mucoid to cobwebby toward the periphery, pale olivaceous beige, reverse beige to dark grey. Sporulation was moderate on MLA and PCA, absent on CMD and OA.
Colonies on MLA effuse, mycelium composed of branched, septate, subhyaline to pale brown hyphae 1.5–3.5 μm diam, or monilioid hyphae 4–5.5 μm diam. Anamorph. Setae absent, conidiophores, conidiogenous cells and conidia similar to those from nature. Conidiophores 38–84 μm long, 1.5–3 μm wide near the base, sometimes tapering toward the base, arise singly from vegetative or monilioid hyphae, usually attached by small lobes at the base, unbranched, erect, septate, smooth, pale brown. Conidiogenous cells 20–31 × 2.5–3.5 μm tapering to 1.5–2 μm, monophialidic, pale brown; collarette 2–2.5 μm wide, 1.5–2 μm deep, funnel-shaped, pale brown. Conidia 10.5–14 × 2–2.5 μm (mean ± SD = 12.6 ± 0.8 × 2.3 ± 0.2 μm), falcate, hyaline, aseptate, setulae 4–8 μm long, accumulate in slimy whitish fascicles. Teleomorph. Unknown.
Other specimens examined: CZECH REPUBLIC, South Bohemian region, Novohradské hory Mts., Dobrá voda, Hojná voda National nature monument, on decaying seed of Fagus sylvatica, 4 October 2012, M. Réblová M.R. 3757 (PRA-20988, culture CBS 144658 = MUCL 56490). CZECH REPUBLIC, Central Bohemian region, Úvaly, Škvorecká obora-Králičina Nature park, on decaying acorn of Quercus sp., 21 April 2018, M. Réblová M.R. 3947 (PRA-20989, culture CBS 144792). BELGIUM, Wallonie, Brabant wallon, Louvain-la-Neuve, Bois de Lauzelle, on decaying leaf in forest stream, date unknown, date unknown, G.L. Hennebert (culture MUCL 28054).
Habitat and geographical distribution: A saprobe on decaying seeds and wooden fruits often buried in soil and on leaves of Fagus sylvatica, Quercus sp. and an unknown host in terrestrial and freshwater biotopes, known from Europe from Belgium and the Czech Republic.
According to GlobalFungi, the identical sequence was found in 227 samples of soil (65%), litter (13%), root (11%), and deadwood (9%) collected mostly in forest (90%), grassland (4%) or anthropogenic (4%) habitats. Most of the samples were from Europe (177 samples, Czech Republic, Belgium, Denmark, France, Germany, Wales), 25 samples were from North America (Massachusetts, New Jersey) and 25 samples were from Asia (Eastern China, Japan and South Korea). The samples originated from 25 studies. The sites have temperate climate (MAT avg. 8.4 °C, MAP avg. 851 mm).
Notes: In culture, some conidiophores of Ca. parvilobata are attached to the pigmented, monilioid hyphae with a lobate, swollen base, a character that was not observed in other species of the genus. The pale yellow to pale ochre pigment diffusing in the agar on MLA was produced only in two strains, including the ex-type strain. The pigment production and visibility is correlated with the absence of aerial mycelium; the colonies become mucoid and their surface changes from whitish-grey to buff yellow, cinnamon to olivaceous brown.
It is challenging to distinguish Ca. parvilobata and Ca. lutea based on morphological characters, because the size of their conidiophores, conidiogenous cells, and also conidia partially overlap under natural conditions. Codinaeella lutea differs in having longer setae and longer conidia in their upper range. However, both species differ especially in colony characteristics and pigment production on MLA and OA. Codinaeella parvilobata can also be compared with Ca. minuta, but the latter species differs in longer conidia and production of ochre to deep orange pigment.
Codinaeella pini (Crous & M.J. Wingf.) Réblová & Hern.-Restr., comb. nov. MycoBank MB 842210 (Figure 22 and Figure 31).

Figure 31.
Codinaeella pini (CBS 138866 ex-type). (A) Colony (B,C) conidia (D) conidiogenous cells (E–G) conidiophores. Images: (A–I) on a stem of U. dioica on CMA after 8 weeks. Scale bars: (B–D) 10 μm; (E–G) 20 μm.
Basionym. Codinaea pini Crous & M.J. Wingf., Persoonia 33: 251. 2014.
For description and additional illustrations, see Crous et al. [8].
Culture characteristics: On CMD: colonies 60–61 mm diam, circular, raised, margin entire, sparsely lanose, floccose becoming mucoid, beige to olivaceous grey centrally, isabelline-beige toward the periphery, reverse brown. On MLA: colonies 76–77 mm diam, circular, raised, margin entire, lanose, floccose, mucoid at the margin, finely furrowed, whitish, ochre-beige at the margin, pale yellow-ochre pigment diffusing into the agar, reverse brown. On OA: colonies 76–78 mm diam, circular, flat, margin entire, cobwebby to powdery centrally becoming mucoid, beige, whitish toward the margin, reverse pale brown. On PCA: colonies 78–79 mm diam, circular, flat, margin entire, sparsely lanose becoming mucoid, pale brown centrally, isabelline toward the periphery, reverse whitish. Sporulation was abundant on PCA, moderate on CMD, MLA, and OA.
Specimen examined: UGANDA, on dead needles of Pinus patula, January 2014, M.J. Wingfield (culture ex-type CBS 138866).
Habitat and geographical distribution: Saprobe on dead needles of Pinus patula, known so far from Africa, Uganda [8]. According to GlobalFungi, the identical sequences were found in 58 soil and five shoot samples (Pinus taeda needles) in the forests of North America (North Carolina, Louisiana, Ontario, British Columbia) originating from studies of Wilhelm et al. [177] and Oono et al. [178]. The sites have temperate, hemiboreal, or humid continental climate (MAT avg. 17 °C, MAP avg. 1144 mm).
Notes: Our observations of the ex-type strain match the protologue. However, conidiophores on MLA formed two distinct layers compared to a single layer of conidiophores 30–100 μm long reported by Crous et al. [8]. On MLA, the upper layer consisted of unbranched, flexuous or bent, setiform conidiophores 130–232 × 2.5–3.5 μm terminating into a mono- or polyphialide with 1–2 lateral apertures, while the lower layer comprised of shorter conidiophores 56–98 × 2.5–3.5 μm with a terminal phialidic aperture. The strain sporulated on all nutrient media included in this study and also on stems of Urtica on CMA and pine needles on SNA. Conidia accumulated in slimy whitish fascicles.
Codinaeella yunnanensis (Z.L. Luo, K.D. Hyde & H.Y. Su) Réblová & Hern.-Restr., comb. nov. MycoBank MB 842211.
Basionym. Codinaea yunnanensis Z.L. Luo, K.D. Hyde & H.Y. Su, Fungal Divers. 99: 590. 2019.
For description and illustrations, see Luo et al. [29].
Habitat and geographical distribution: Saprobe on submerged decaying wood, known only from Asia, China [29]. According to GlobalFungi, the identical sequences were found in three soil samples from forests in Asia (Central China Hubei province and Iran) [115,179]. The localities have temperate climate (MAT avg. 16 °C, MAP avg. 1094 mm).
Notes: Codinaeella yunnanensis resembles Ca. lutea and Ca. mimusopis in conidial characters, however, the size of their conidia significantly overlaps. For morphological comparison, see Table S5. In the phylogenetic analysis, all three species formed separate lineages; Ca. yunnanensis nested in a clade with Ca. lutea and Ca. pini.
3.5.3. The Genus Nimesporella
Nimesporella Réblová & Hern.-Restr., gen. nov. MycoBank MB 842002.
Type species. Nimesporella capillacea Réblová & Hern.-Restr.
Etymology: An anagram of Menisporella, a synonym of Codinaea.
Description: Colonies effuse, brown, composed of conidiophores, mycelium immersed. Anamorph. Setae absent. Conidiophores macronematous, mononematous, single or in groups, erect, straight or flexuous to geniculate in the upper part, unbranched, septate, smooth, brown, paler toward the apex. Conidiogenous cells integrated, terminal, polyphialidic, extending sympodially, paler than the conidiophore, often with persistent remnants of the collarettes; collarettes flared, soon evanescent. Conidia ellipsoidal, rounded at the apical end, papillate at the basal end, aseptate, hyaline, with a straight or gently curved setula at each end, basal setulae positioned ventrally, conidia accumulate in slimy whitish fascicles. Teleomorph. Unknown.
Habitat and geographical distribution: Nimesporella occurs on decaying plant material in freshwater and terrestrial habitats, and it is known from Africa.
Notes: Nimesporella capillacea is the only species of the genus available to represent this uncommon morphotype in the present phylogeny. It forms a basal lineage to the Codinaea clade but their relationship is not statistically well supported. Nimesporella differs from Codinaea mainly by the characters of conidiogenous cells with multiple phialidic apertures, early evanescent collarettes and papillate, broadly ellipsoidal conidia with a simple setula at each end, inserted terminally at the apex and somewhat ventrally at the base. When grown in culture, the phialides extend sympodially for a short distance, producing densely aggregated phialidic openings encircled by tubular, apically flared collarettes. Similar polyphialides were also recorded in Multiguttulispora [49].
Species such as Dictyochaeta aliformis, D. daphnioides and D. tumidospora known only from Southeast Asia from Malaysia [22] bear a striking resemblance to N. capillacea in all characteristics. On material from nature [22], conidiogenous cells frequently elongate sympodially, while internally septa may be formed. As a result, 1–2 intercalary phialidic openings are formed per each cell in the upper part of the conidiophore. After careful comparison of their original descriptions and illustrations with N. capillacea we suggest that they are likely congeneric. Their transfer to Nimesporella should be supported by DNA data, which are unavailable for study at the moment. The strain of N. capillacea was originally deposited under the name D. daphnioides.

Figure 32.
Nimesporella capillacea (IMI 358908 ex-type). (A–G) Conidiophores (H) conidia (I) colonies on CMD, MLA, OA and PCA after 4 week (from left to right). Images: (A–H) on PCA after 4–6 weeks. Scale bars: (A–H) 10 μm; (I) 1 cm.
Etymology: Capillus (L) hair or thread, -acea (L) indicating resemblance, meaning hair-like or thread-like, referring to conidial setulae.
Typification: IVORY COAST, Tai National Park, leaf litter, 11 March 1992, S. Pagano (holotype IMI 358908 microscopic slides, ex-type culture IMI 358908).
Culture characteristics: On CMD: colonies 41–42 mm diam, circular, flat, margin fimbriate, sparsely lanose becoming cobwebby, white, beige toward the periphery, reverse grey-beige, isabelline at the margin. On MLA: colonies 38–39 mm diam, circular, convex, margin entire, lanose, floccose, furrowed, cobwebby at the margin, whitish centrally, beige-grey to ochre-beige with an olivaceous beige outer zone, reverse dark amber. On OA: colonies 65–68 mm diam, circular, flat, margin entire to weakly fimbriate, velvety-lanose, floccose to funiculose centrally, mucoid at the margin, beige with an olivaceous outer zone, reverse olivaceous beige. On PCA: colonies 51–52 mm diam, flat, circular, flat, similar to colonies on OA, sparsely lanose, floccose to funiculose centrally, whitish-beige becoming olivaceous beige, with an isabelline outer zone of submerged growth, reverse zonate, olivaceous beige. Sporulation was abundant on MLA, OA, PCA, sparse on CMD.
Colonies on MLA effuse, mycelium composed of branched, septate, hyaline hyphae 1.5–2.5 μm diam. Anamorph. Setae absent. Conidiophores 28–130 μm long, 3–4.5 μm wide near the base, macronematous, occasionally reduced to conidiogenous cells, grow solitarily from vegetative hyphae or arise in groups of 2–3 from dark knots of hyphal cells, erect, straight or slightly bent, septate, smooth, brown, paler toward the tip. Conidiogenous cells 22–35(–45) × 3–3.5 μm, slightly tapering upwards, 2–3.5 μm wide below the fertile apical part, integrated, terminal, extending sympodially over a short distance, polyphialidic with 5–22 lateral openings, fertile part 5.5–17(–23.5) × 2–3.5 μm, occasionally dichotomously branched, with persistent remnants of the collarettes; collarettes 1.5–2 μm wide, 1.5–2 μm deep, hyaline, minute, tubular, apically flared, evanescent, the apical part sometimes attached to the bottom of the conidium. Conidia 8–11.5 μm × 4.5–5 μm (mean ± SD = 9.5 ± 0.9 × 4.5 ± 0.2 μm), ellipsoidal, broadly rounded at the apical end, papillate or beak-like at the basal end, aseptate, hyaline, with a straight or gently curved setula at each end, 2–3.5 μm long, positioned terminally at the apex and subterminally at the base, conidia accumulate in slimy whitish fascicles. Teleomorph. Unknown.
Habitat and geographical distribution: Saprobe on leaf litter in freshwater habitat, known in Ivory Coast.
Notes: Nimesporella capillacea closely resembles N. aliformis, N. daphnioides and N. tumidospora, all known only from Malaysia [22], but which differ in having longer conidiophores and larger conidia.
3.5.4. The Genus Stilbochaeta
Stilbochaeta Réblová & Hern.-Restr., gen. nov. MycoBank MB 842001.
Etymology: Stilbos (Greek) glistening, referring to slimy droplets of conidia that are glistening when fresh; chaeta (Greek) hair, bristle.
Type species. Stilbochaeta malaysiana (Kuthub.) Réblová & Hern.-Restr.
Description on the natural substrate: Colonies effuse, hairy, brown, composed of setae and conidiophores, occasionally ascomata, mycelium immersed or semi-immersed. Anamorph. Setae grow singly or in groups from stromatic cells or knots of hyphal cells, erect, straight or flexuous, septate, brown, paler toward the apex, unbranched, apex sterile, bluntly rounded, sometimes with a terminal or several lateral phialidic openings. Conidiophores macronematous, mononematous, single or grow in fascicles from stromatic cells or knots of hyphal cells around the base of the setae, erect, straight or flexuous to slightly undulating, unbranched, septate, smooth, brown, paler toward the apex. Conidiogenous cells integrated, terminal, mono- or polyphialidic, extending percurrently and sympodially, paler than the conidiophores; collarettes flared, funnel-shaped, often slightly stipitate or tubular near the base. Conidia falcate, oblong-falcate, ellipsoidal-fusiform, curved, tapering toward both ends, slightly truncate at the base, with an inconspicuous basal scar, 0–1(–3)-septate, hyaline, with a straight or gently curved setula at each end, setulae simple, bifid or trifid, inserted terminally at the apex and subterminally at the base, conidia accumulate in slimy fascicles. Teleomorph. Ascomata perithecial, non-stromatic, superficial, globose to subglobose, papillate, dark brown, setose; setae sterile, rounded at the apex. Ostiole periphysate. Ascomatal wall fragile, carbonaceous, two-layered. Paraphyses disappearing with age, septate, tapering, longer than the asci. Asci unitunicate, cylindrical-clavate, shortly-stipitate, apically rounded, ascal apex with a non-amyloid apical annulus. Ascospores fusiform, hyaline, transversely septate, without gelatinous sheath or appendages.
Habitat and geographical distribution: Members of Stilbochaeta occur in freshwater and terrestrial habitats, they are saprobes on leaf litter, bamboo and decaying bark and wood. They are widespread throughout the world, especially in tropical and temperate regions of Africa, Asia, Australasia, the Caribbean and South America ([2,17,19,28,29,31,81,180], this study).
Notes: Stilbochaeta is introduced for a group of former Codinaea and Dictyochaeta species. It is morphologically and phylogenetically well-delimited and characterized by arrangement of setae and conidiophores in bundles growing from dark stromatic cells or knots of hyphal cells. Setae have sterile, bluntly rounded apices that are sometimes modified into mono- or polyphialides, while in Codinaea the setae are tapering toward the apices, which may be also fertile. The conidia are always septate, although aseptate and septate conidia can sometimes occur together in one strain, in contrast to morphologically similar Codinaea with exclusively aseptate conidia and setae. In culture, representatives of Stilbochaeta often form yellow, gold, cinnamon, or amber pigments that diffuse into the agar. The aerial mycelium that forms in vitro is often pigmented and the surface of the colonies is usually olivaceous cinnamon, olivaceous gold or beige-orange.
Eight species are assigned to the genus, all of which were verified using molecular data. Three other species closely resemble Stilbochaeta but have setae with acute, rarely obtuse apices and include Dictyochaeta tortuosa [7] with 1–2-septate conidia, and D. caatingae [121] and D. matsushimae [27] with 2–3-septate conidia. These species have not yet been evaluated based on molecular data. A synopsis table with diagnostic features of accepted species of Stilbochaeta is provided as a Supplementary File: Table S6.
Stilbochaeta aquatica (W. Dong & H. Zhang) Réblová & Hern.-Restr., comb. nov. MycoBank MB 842213. (Figure 33 and Figure 34).

Figure 33.
Stilbochaeta aquatica (CBS 114070, ex-type strain of Dictyochaeta curvispora). (A,B) Setae with conidiophores (C–E) conidiophores (F–H) conidia. Images: (A–H) on a stem of U. dioica on CMA after 6–8 weeks. Scale bars: (A,B) 25 μm (C–H) 10 μm.

Figure 34.
Colony morphology of Stilbochaeta spp. after 4 weeks. (A) S. aquatica CBS 114070 (B) S. malaysiana IMI 312436 ex-type (C) S. ramulosetula IMI 313452 ex-epitype (D) S. septata CBS 143386 ex-epitype (E) S. septata CBS 146716. Scale bar: (A–E) 1 cm.
Basionym. Dictyochaeta aquatica W. Dong & H. Zhang, Phytotaxa 362: 193. 2018.
Culture characteristics: On CMD: colonies 28–32 mm diam, circular, flat, margin entire, velvety, somewhat floccose, mucoid at the margin, whitish with a pale apricot tinge, yellow toward the margin, with an outer zone of submerged growth, pale yellow pigment diffusing into the agar, reverse pale apricot. On MLA: colonies 49–50 mm diam, circular, flat, slightly raised centrally, velvety becoming cobwebby, mucoid at the margin, whitish with an apricot-gold tinge centrally, whitish-yellow toward the periphery, pale gold pigment diffusing into the agar, reverse gold to honey. On OA: colonies 45–48 mm diam, circular, convex centrally, flat margin, margin entire, velvety, cobwebby to mucoid at the centre, zonate, yellow centrally, white toward the margin with yellow-white outer zone, pale yellow pigment diffusing into the agar, reverse bright yellow. On PCA: colonies 52–56 mm diam, circular, flat, margin entire, mucoid, yellow-gold centrally, isabelline toward the margin, yellow pigment diffusing into the agar at the centre of the colony, reverse of the same colors. Sporulation was absent on all media.
Colonies on CMA with U. dioica stems effuse, hairy, mycelium composed of branched, septate, hyaline to subhyaline hyphae 1.5–2 μm diam. Anamorph. Setae 122–182 μm, 3.5–4.5 μm wide above the base, arise singly or in groups of two from knots of dark brown hyphal cells, erect, straight or flexuous, septate, smooth, dark brown and thick-walled, paler and thinner-walled toward the apex, unbranched, apex pale brown, with a terminal or 1–3 lateral phialidic openings. Conidiophores 45–102 μm long, 3–4 μm wide near the base, macronematous, single or arise in fascicles of 2–4 from knots of dark hyphal cells around the base of the setae, erect, straight or flexuous, septate, smooth, medium to pale brown, paler toward the tip. Conidiogenous cells 10–29 × 3–3.5 μm tapering to 1.5–2 μm below the collarette, integrated, terminal, mono-, or polyphialidic with 1–4 lateral openings, extending sympodially, occasionally percurrently, subcylindrical, pale brown, subhyaline at the apex, sometimes with persistent remnants of the collarettes; collarettes 2.5–4.5 μm wide, 2–3.5 μm deep, funnel-shaped to slightly tubular, subhyaline. Conidia 13.5–17.5 × 2.5–3 μm (mean ± SD = 16.0 ± 1.1 × 2.7 ± 0.6 μm), falcate to oblong-falcate, with an inconspicuous basal scar, 0–1-septate, hyaline, with a straight or gently curved setula at each end, 5–8.5 μm long, positioned terminally at the apex and slightly subterminally at the base, conidia accumulate in slimy whitish fascicles. Teleomorph. Unknown.
Specimen examined: PHILIPPINES, Negros Occidental, Bario Alegria, Lupit River, submerged bamboo stems, 18 August 2001, L. Cai (CBS 114070 ex-type strain of Dictyochaeta curvispora, contamination).
Habitat and geographical distribution: Saprobe on submerged wood and bamboo culm, known from Southeast Asia from the Philippines and Thailand ([28], this study). According to GlobalFungi, the identical sequences were found in one soil sample in forest in Asia (South China) [162]. The location has a temperate climate (MAT avg. 22 °C, MAP avg. 1627 mm).
Notes: Cai et al. [181] described D. curvispora for a hyphomycete with pigmented, unbranched conidiophores terminating into a monophialide and producing aseptate, hyaline, cylindrical, crescent-shaped to falcate conidia without setulae. According to the authors, the ex-type strain CBS 114070 did not sporulate in culture. It formed greyish-yellow colonies on potato-dextrose agar, a yellow pigment staining agar around the colony and pale orange-brown reverse. These culture characteristics, in particular the presence of the yellow pigment diffusing into the agar, correspond with our observations. However, the morphology of D. curvispora is not congruent with the placement of its ex-type strain among Stilbochaeta species. We therefore suspected that the ex-type strain might have been contaminated during isolation. Cultivation of the strain CBS 114070 on Urtica stems on CMA yielded sporulating colonies of a fungus with the Stilbochaeta morphology and provided the evidence that the ex-type strain of D. curvispora was indeed contaminated. Based on comparison with morphologically similar species and their DNA data, this isolate was identified as S. aquatica. Based on their protologues and original illustrations, D. curvispora and S. aquatica are two different species. For reasons explained above, the strain CBS 114070 cannot be used to represent D. curvispora; the systematic placement of this species remains unknown.
Stilbochaeta brevisetula (S. Hughes & W.B. Kendr.) Réblová & Hern.-Restr., comb. nov. MycoBank MB 842214. (Figure 35, Figure 36 and Figure 37).

Figure 35.
Stilbochaeta brevisetula (DAOM 96420a isotype). (A) Substrate with colonies (B) colony on wood (C–F) setae and conidiophores (G) conidia. Images: (A–G) from nature. Scale bars: (B) 500 μm; (C,D) 25 μm; (E–G) 10 μm.

Figure 36.
Stilbochaeta brevisetula. (A–D) Ascomata (E) setae on the ascomal wall (F) vertical section of the ascomal wall (G,H,O–R) setae and conidiophores (I) asci with ascospores (J–N) conidia. Images: (A–K) from nature (L–R) on MLA after 6–8 weeks (A,L) from ICMP 22548 (B–E,G,H,J,K) from ICMP 22549 ex-epitype (F,I,M,N,R) from ICMP 22551 (O–Q) from ICMP 22552. Scale bars: (A–D) 250 μm; (E–H,O–R) 20 μm; (I–N) 10 μm.

Figure 37.
Colony morphology of Stilbochaeta brevisetula after 4 weeks. (A) ICMP 22548 (B) ICMP 22549 ex-epitype (C) ICMP 22551 (D) ICMP 22552. Scale bar: (A–D) 1 cm.
Basionym. Codinaea brevisetula S. Hughes & W.B. Kendr., N. Z. J. Bot. 6: 338. 1968.
≡ Dictyochaeta brevisetula (S. Hughes & W.B. Kendr.) Aramb. & Cabello, Mycotaxon 34: 681. 1989. (Nom. inval., Art. 41.4).
≡ Dictyochaeta brevisetula (S. Hughes & W.B. Kendr.) Whitton, McKenzie & K.D. Hyde, Fungal Divers. 4: 137. 2000.
Typification: NEW ZEALAND, Wellington region, Tongariro National Park, Ohakune Mountain Road (alt. 762 m), on bark of Nothofagus fusca, 7 March 1963, S.J. Hughes 439a (holotype of Codinaea brevisetula PDD 20652, isotype DAOM 96420a). NEW ZEALAND, Otago region, Queenstown-Lakes district, Mount Aspiring National Park, Makarora, Mt. Shrimpton track, on decaying wood of a trunk of Nothofagus sp., 24 March 2005, M. Réblová M.R. 3347/NZ 620 (epitype designated here MBT 10004617, PDD 119677, culture ex-epitype ICMP 22549).
Description on the natural substrate: Colonies effuse, grey-brown to olivaceous grey, composed of setae, conidiophores and ascomata. Anamorph. Setae 94–150 μm long, 3.5– μm wide above the base, single or arise in groups of 2–3 from knots of dark brown hyphal cells, erect, straight or slightly flexuous, septate, smooth, medium brown, thick-walled, darker at the base, paler and thinner walled toward the apex, unbranched, occasionally extending percurrently, apex subhyaline, bluntly rounded and slightly inflated, sterile. Conidiophores 43–100 μm long, 3.5–4.5 μm wide above the base, macronematous, arise single or in fascicles of 4–9 from knots of dark brown hyphal cells around the base of the setae, erect, straight to slightly undulating, septate, smooth, pale brown, paler toward the tip. Conidiogenous cells 16.5–32 × 3.5–4.5 μm tapering to (1.5–)2 μm below the collarette, integrated, terminal, mono- or polyphialidic with 1–3 lateral openings, extending percurrently and sympodially, cylindrical, pale brown, subhyaline at the apex; collarettes 3.5–4 μm wide, 2–2.5(–3) μm deep, funnel-shaped, subhyaline. Conidia 17–22 × 3–4 μm (mean ± SD = 19.2 ± 1.6 × 3.3 ± 0.3 μm), oblong-falcate, slightly tapering toward both ends, with an inconspicuous basal scar, 1-septate, hyaline, with a straight or gently curved setula at each end, 1–1.5 μm long, inserted terminally at the apex and subterminally at the base, conidia accumulate in slimy whitish fascicles. Teleomorph. Ascomata 250–330 μm diam, non-stromatic, superficial, globose to subglobose, papillate, dark brown, clothed with setae that are similar to those accompanying the conidiophores of the anamorph, becoming glabrous with age; setae yellow-brown, pale brown to subhyaline toward the apex, apex bluntly rounded, slightly inflated, sterile. Ostiole periphysate. Ascomatal wall fragile, carbonaceous, 24–30 μm thick, two-layered. Outer layer consisting of brown, polyhedral cells with opaque walls. Inner layer consisting of several rows of thin-walled, elongated, hyaline cells. Paraphyses 3.5–5 μm wide tapering to 1.5–3 μm, septate, longer than the asci. Asci 100–114 × 7.5–8.5 μm (mean ± SD = 108.0 ± 4.9 × 8.0 ± 0.5 µm), 83–98 μm (mean ± SD = 92.0 ± 4.4 µm) long in the sporiferous part, cylindrical-clavate, stipitate, apically rounded, ascal apex with a shallow, non-amyloid apical annulus 2.5–3 μm wide, 1–1.5 μm high. Ascospores (15–)16–24 × 3–4(–4.5) μm (mean ± SD = 18.7 ± 2.1 × 3.4 ± 0.3 µm), fusiform, hyaline, 3-septate, 2-seriate or obliquely uniseriate in the ascus.
Culture characteristics: On CMD: colonies 32–35 mm diam, circular, flat, raised centrally, margin entire, velvety-lanose, mucoid locally, cobwebby at the margin, with a prominent outer zone of submerged growth, finely furrowed, white to pale ochre-beige, isabelline at the margin, reverse pale olivaceous beige. On MLA: colonies 33–36 mm diam, circular, flat, convex centrally, margin fimbriate, lanose, olivaceous ochre to olivaceous cinnamon, with an olivaceous brown to apricot outer zone of submerged growth, pale ochre-brown pigment diffusing into agar, reverse dark olivaceous orange. On OA: colonies 32–34 mm diam, circular, convex, margin entire to undulate, lanose, somewhat floccose, aerial mycelium occasionally reduced, colonies cobwebby to mucoid, pale olivaceous apricot to olivaceous grey-brown with an orange tinge, pale ochre/apricot pigment diffusing into agar, reverse olivaceous-ochre to cinnamon, isabelline at the margin. On PCA: colonies 30–32 mm diam, circular, flat, raised centrally, margin undulate, lanose, cobwebby toward the periphery, white-beige at the centre, pale beige-apricot to pale sepia toward the periphery with an outer zone of submerged growth, pale apricot pigment diffusing into agar, reverse olivaceous apricot. Sporulation was abundant on MLA, OA, moderate on PCA, absent on CMD.
Colonies on OA effuse, hairy, mycelium composed of branched, septate, subhyaline to hyaline hyphae 2–3 μm diam. Anamorph. Setae, conidiophores, conidiogenous cells and conidia similar to those from nature. Setae 116–132 μm long, 4–5 μm wide above the base, extending percurrently, sterile. Conidiophores 49–87(–105) μm long, 3.5–4.5 μm wide above the base, arise singly or in small groups, interspersed among the setae. Conidiogenous cells 14–34 × 3.5–5 μm tapering to 2–2.5 μm below the collarette, integrated, terminal, mono- or polyphialidic with 1–2 lateral openings, extending percurrently and sympodially, cylindrical, pale brown, subhyaline at the apex; collarettes 4–4.5 μm wide, 2–2.5 μm deep, funnel-shaped, subhyaline. Conidia (15.5–)17–22 × 3–4 μm (mean ± SD = 19.2 ± 1.6 × 3.4 ± 0.3 μm), 1-septate, setulae 1–1.5 μm long, accumulate in slimy whitish fascicles. Teleomorph. Not observed.
Specimens examined: NEW ZEALAND, Otago region, Queenstown-Lakes district, Mount Aspiring National Park, Makarora, Mt. Shrimpton track, on decaying wood of Nothofagus sp., 24 March 2005, M. Réblová M.R. 3339/NZ 611 (PDD 119678, ICMP 22548); Ibid., M.R. 3338/NZ 610, M.R. 3344/NZ 616, M.R. 3349/NZ 622. NEW ZEALAND, Otago region, Queenstown-Lakes District, Makarora, Makarora Bush Walk, on decaying wood of a trunk, 30 March 2005, M. Réblová M.R. 3410/NZ 691 (PDD 119679, ICMP 22551). NEW ZEALAND, West Coast region, Buller district, Victoria Forest Park, Lyell, Lyell Historical Walk, on decaying wood of a branch, 6 April 2005, M. Réblová M.R. 3455/NZ 742 (PDD 119680, ICMP 22552). NEW ZEALAND, West Coast region, Buller district, Victoria Forest Park, Murray Creek Track, on decaying wood of Nothofagus sp., 21 February 2003, M. Réblová & K.A. Seifert M.R. 2587/NZ 49 (PDD 81887). NEW ZEALAND, West Coast region, Buller district, Victoria Forest Park, Palmer’s Hut ca. 18 km SW of Springs Junction on unpaved road, Lake Christabel track, on decaying wood of Nothofagus sp., 28 February 2003, M. Réblová M.R. 3423/NZ 162 (PDD 119681, ICMP 15125). NEW ZEALAND, West Coast region, Westland district, Otira, Kelly Shelter, Cockayane Nature Walk MR, on decaying wood, 11 April 2005, M. Réblová M.R. 3466/NZ 754.
Habitat and geographical distribution: Saprobe on decaying bark and wood of Nothofagus fusca, Nothofagus sp. and other unidentified hosts, known only from Australasia from New Zealand ([2], this study). The database GlobalFungi does not contain similar sequences (≥98%) of this species.
Notes: Stilbochaeta brevisetula is the only species of the genus known to have a teleomorph, which is reported for the first time in this study. Ascomata are often covered by setae that resemble those associated with the conidiophores of the anamorph, although with age the setae disappear and ascomata become glabrous. The anamorph-teleomorph relationship was experimentally verified. Stilbochaeta brevisetula is well distinguishable from other members of the genus by the shortest conidial setulae (1–2.7 μm) and setae that are sterile, apically bluntly rounded and slightly inflated.
The teleomorph of S. brevisetula is remarkably similar to Chaetosphaeria (Ch.) hebetiseta [182], a saprobic lignicolous species with a Chloridium-like anamorph. Their ascomata are covered with always sterile, brown, septate setae that terminate into rounded subhyaline cells and they also share 3-septate, hyaline, fusiform ascospores of comparable size. However, the ascospores of S. brevisetula are smooth-walled, while those of Ch. hebetiseta are verrucose, also their anamorphs clearly differ in characters of conidia. The two species are shown distantly related in the phylogenetic tree (Figure 2).
Stilbochaeta cangshanensis (Z.L. Luo, K.D. Hyde & H.Y. Su) Réblová & Hern.-Restr., comb. nov. MycoBank MB 842215.
Basionym. Dictyochaeta cangshanensis Z.L. Luo, K.D. Hyde & H.Y. Su, Fungal Divers. 99: 592. 2019.
For description and illustrations, see Luo et al. [29].
Habitat and geographical distribution: Saprobe on submerged decaying wood, known only from Asia, China [29]. According to GlobalFungi, the identical sequences were found in 13 soil and one shoot samples collected in forests of Europe (five samples, South Italy), Asia (seven samples, Iran, South China), and Eastern North America (one sample, Tennessee) [115,117,162,183,184]. The sites have temperate or Mediterranean climate (MAT avg. 17 °C, MAP avg. 842 mm).
Notes: This species closely resembles S. aquatica and it is difficult to distinguish them based solely on morphological characters, especially when the size of their conidia significantly overlap, i.e., 14–18 × 2–3 μm with setulae 8–13 μm long in S. aquatica [28] vs. 15–18 × 2.5–3.5 μm in S. cangshanensis [29]; the length of the setulae of the latter species were not given in the protologue. In the phylogenetic analysis, the two species form distinct lineages.
Stilbochaeta malaysiana (Kuthub.) Réblová & Hern.-Restr., comb. nov. MycoBank MB 842216. (Figure 34 and Figure 38).

Figure 38.
Stilbochaeta malaysiana (IMI 312436 ex-type). (A,B) Setae and conidiophores (C,D) conidiophores with conidiogenous cells, in detail (E,F) colonies (G–J) tip of the conidiogenous cells with collarettes (K,L) conidia. Images: (A–D,G–L) on CMD after 4–6 weeks (E) on MLA after 4 weeks (F) on OA after 4 weeks. Scale bars: (A,B) 25 μm; (C,D) 20 μm; (E,F) 1 cm; (G–L) 10 μm.
Basionym. Dictyochaeta malaysiana Kuthub., Trans. Br. mycol. Soc. 89: 356. 1987.
Culture characteristics: On CMD: colonies 24–25 mm diam, circular, raised, margin undulate, lanose, cobwebby at the margin, grey-beige centrally, beige toward the margin, ochre pigment diffusing into agar, reverse dark cinnamon. On MLA: colonies 62–63 mm diam, circular, raised, flat margin, margin fimbriate, lanose, zonate, finely furrowed, whitish-beige becoming olivaceous ochre-beige toward the periphery, dark cinnamon at the margin, caramel pigment diffusing into the agar, reverse dark cinnamon. On OA: colonies 61–62 mm diam, circular, raised, margin lobate, lanose, floccose, furrowed, zonate with a central cobwebby ring surrounded by small lanose areas of radially spreading mycelium, ochre-grey centrally, pale ochre-beige to olivaceous cinnamon toward the periphery, aerial hyphae with numerous pale ochre exudates, dark cinnamon pigment diffusing into the agar, reverse dark amber to brown. On PCA: colonies 32–38 mm diam, flat, circular, margin undulate, sparsely lanose to cobwebby, ochre-beige, pale cinnamon pigment diffusing into the agar, reverse cinnamon. Sporulation was moderate on CMD and PCA, absent on MLA and OA.
Colonies on CMA with U. dioica stems effuse, hairy, mycelium composed of branched, septate, hyaline to subhyaline hyphae 1.5–3 μm diam. Anamorph. Setae 230–281 μm long, 4–5.5 μm wide near the swollen base, single or arise in groups of two from knots of dark brown hyphal cells, erect, straight or flexuous, septate, smooth, dark brown and thick-walled, paler and thinner-walled toward the apex, unbranched, apex pale brown, sterile. Conidiophores 78–113 μm long, 4–5.5 μm wide near the base, macronematous, single or arise in fascicles of 2–5 from knots of dark brown hyphal cells around the base of the setae, erect, straight or bent, septate, smooth, medium to pale brown, paler toward the tip. Conidiogenous cells 17–21(–37) × 3.5–4.5(–5) μm tapering to 1.5–2 μm below the collarette, integrated, terminal, mono- or polyphialidic with 1–3 lateral openings while internally septa can be formed, extending percurrently and sympodially, subcylindrical, pale brown; collarettes 4.5–7 μm wide, 3.5–4.5 μm deep, funnel-shaped to slightly campanulate, tubular at the base, pale brown. Conidia 21–26 × 2.5–3.5 μm (mean ± SD = 23.6 ± 1.3 × 3.0 ± 0.2 μm), falcate, with an inconspicuous basal scar, 1-septate, hyaline, with a straight or gently curved setula at each end, 12–18 μm long, positioned terminally at the apex and slightly subterminally at the base, conidia accumulate in slimy whitish fascicles. Teleomorph. Unknown.
Specimen examined: MALAYSIA, Selangor, Kepong Forest Reserve, on decaying leaves, October 1986, A.J. Kuthubutheen KUM 534 (holotype IMI 312436, ex-type strain IMI 312436).
Habitat and geographical distribution: Saprobe on decaying leaves known from Southeast Asia, Malaysia [19]. According to GlobalFungi, the identical sequences were found in 13 soil samples collected in forests of the Caribbean (12 samples, Puerto Rico, Trinidad and Tobago [119,185] and South Asia (one sample, India) [117]. The locations have tropical climate (MAT avg. 22 °C, MAP 3124 mm).
Notes: Kuthubutheen [19] listed two specimens with different localities in the protologue, however, only one number to indicate the holotype IMI 312436. By comparing the protologue with the type material deposited in the Kew herbarium, it was found that the locality of a specimen listed second in order is the place of collection of the holotype. Kuthubutheen [19] did not indicate an ex-type strain of his new species. Strain of S. malaysiana, with identical designation IMI 312436 as the holotype and accompanying metadata, deposited by A.J. Kuthubutheen, was obtained from the CABI culture collection. We confirm its identity and connect the holotype with the ex-type strain in this study.
Stilbochaeta novae-guineensis closely resembles S. malaysiana, but differs from it by shorter conidia. Stilbochaeta aquatica is also comparable with S. malaysiana, but differs in smaller 0–1-septate conidia.
Stilbochaeta novae-guineensis (Matsush.) Réblová & Hern.-Restr., comb. nov. MycoBank MB 842217 (Figure 39 and Figure 40).

Figure 39.
Stilbochaeta novae-guineensis. (A,G) Colonies (B,I) conidiophores (C,D,L–N) conidia (E,F,J,K) setae with conidiophores (H) setae and conidiophores arranged in a sporodochium-like. Images: (A–F) from nature (G,J,L–N) on a stem of U. dioica on CMA after 4 weeks (H,I,K) on OA after 8 weeks (A,G,J,L–N) from CBS 147515 (H,I,K) from CBS 147517. Scale bars: (B,I) 10 μm; (C,D,L–N) 5 μm; (E,F) 25 μm; (H) 500 μm; (J,K) 20 μm.

Figure 40.
Colony morphology of Stilbochaeta novae-guineensis after 4 weeks. (A) CBS 147515 (B) CBS 147517. Scale bar: (A,B) 1 cm.
Basionym. Codinaea novae-guineensis Matsush., Microfungi of the Solomon Islands and Papua-New Guinea: 14. 1971.
≡ Dictyochaeta novae-guineensis (Matsush.) A.I. Romero, Boln Soc. argent. Bot. 22: 76. 1983.
Description on the natural substrate: Colonies effuse, brown, composed of setae and conidiophores, mycelium semi-immersed. Anamorph. Setae 95–162 μm long, 3–5 μm wide near the swollen base, arise singly or in groups of two from dark brown stromatic cells, erect, straight or flexuous, septate, smooth, dark brown and thick-walled, paler and thinner-walled toward the apex, unbranched, apex pale brown, sterile or with a terminal phialidic opening. Conidiophores 27.5–58 μm long, 3–5 μm wide near the base, macronematous, arise singly or in groups of 5–7 from stromatic cells around the base of the setae, erect, straight or slightly bent, septate, smooth, medium to pale brown, paler toward the tip. Conidiogenous cells 17–30 × 2.5–5 μm tapering to 1–2 μm below the collarette, integrated, terminal, mono- or polyphialidic with 1–2(–3) lateral opening, extending sympodially, cylindrical, medium to pale brown; collarettes 2.5–5 μm wide, 1.5–3.5 μm deep, funnel-shaped, pale brown, the apical part often evanescent or broken off and attached to the conidial mass. Conidia 14–19 × 2–4 μm (mean ± SD = 17.1 ± 3.1 × 1.6 ± 0.3 μm), falcate to oblong-falcate, with an inconspicuous basal scar, 0–1-septate, hyaline, with a straight or gently curved setula at each end, 6–12 μm long, conidia accumulate in slimy whitish fascicles. Teleomorph. Unknown.
Culture characteristics: On CMD: colonies 25–25 mm diam, circular, flat, margin fimbriate, lanose to cobwebby, zonate, beige-brown to isabelline with darker concentric rings, reverse dark ivory. On MLA: colonies 32–35 mm diam, circular, convex, margin entire, lanose, floccose, finely furrowed centrally, whitish-grey to grey-brown, with a prominent outer zone of submerged growth, reverse olivaceous brown. On OA: colonies 49–68 mm diam, circular, raised, margin entire, velvety-lanose, floccose, with a central zone of sparse growth, whitish to dark grey-brown, sometimes the dark pigment in subsurface mycelium is absent, colonies becoming partially mucoid, whitish-beige, reverse pale brown to dark olivaceous grey. On PCA: colonies 49–52 mm diam, circular, flat, margin fimbriate to lobate, mucoid centrally, cobwebby toward the margin, isabelline to whitish-beige, pale ochre-brown at the margin, reverse of the same colors. Sporulation was moderate on MLA, OA and PCA, absent on CMD.
Colonies on CMA with U. dioica stems effuse, hairy, mycelium composed of branched, septate, hyaline to subhyaline hyphae 2–3 μm diam. Anamorph. Setae, conidiophores, conidiogenous cells and conidia similar to those from nature. Setae 100–202 μm long, 3–5 μm wide near the base, sterile or with a terminal or several lateral phialidic openings. Conidiophores 24–92 μm long, 3–5 μm wide near the base, arise in fascicles of 2–5 from knots of dark hyphal cells around the base of the setae, unbranched. Conidiogenous cells 10–30 × 2.5–5 μm tapering to 1.5–2 μm below the collarette, mono- or polyphialidic with 1–5 lateral openings while internally septa can be formed, pale brown to subhyaline; collarettes 2–4 μm wide, 1.5–3.5 μm deep, funnel-shaped, subhyaline. Conidia 14.5–33 × 2–3.5 μm (mean ± SD = 19.86 ± 2.97 × 3.42 ± 0.34 μm), falcate to oblong-falcate, 0–1-septate, setulae 3–14 μm long, accumulate in slimy whitish fascicles. Teleomorph. Unknown.
Specimens examined: PUERTO RICO, on decaying wood, 19 July 2018, M. Hernández-Restrepo M.H.R. 18004 (CBS H-24746, culture CBS 147515); Ibid., on decaying twig, 19 July 2018, M. Hernández-Restrepo M.H.R. 18018 (CBS H-24748, culture CBS 147517).
Habitat and geographical distribution: Saprobe on decaying leaves, wood and bark of Castanopsis sp. and other unidentified hosts, found in the tropical geographical areas of Africa, Australasia, the Caribbean and South America: Brazil, Cuba, Ivory Coast, Puerto Rico and Solomon Islands ([17,121,134,146,147,180,186], this study).
According to GlobalFungi, the identical sequences were found in six soil samples in forests of South America (Peru) [116] and the Caribbean (Puerto Rico) [119]. The sites have tropical climate (MAT avg. 22 °C, MAP avg. 3059 mm).
Notes: Onofri and Zucconi [180] emended the species diagnosis with polyphialidic conidiogenous cells, which were described as exclusively monophialidic in the protologue [17]. In our material of S. novae-guineensis, the conidiogenous cells were predominantly monophialidic, occasionally with 1–2(–3) lateral phialidic apertures. When grown in culture, the polyphialides with up to five lateral openings formed frequently. Stilbochaeta malaysiana resembles S. novae-guineensis but differs in longer conidia. It is challenging to distinguish S. novae-guineensis from S. septata as the size of their conidia considerably overlaps; for their comparison see notes to the latter species.
Stilbochaeta ramulosetula (Kuthub.) Réblová & Hern.-Restr., comb. nov. MycoBank MB 842218. (Figure 34 and Figure 41).

Figure 41.
Stilbochaeta ramulosetula (IMI 313452 ex-epitype). (A) Seta with conidiophores (B,C) conidiophores (D) conidia. Images: (A–C) on CMD after 5 months. Scale bars: (A) 25 μm; (B,C) 20 μm; (D) 10 μm.
Basionym. Dictyochaeta ramulosetula Kuthub., Trans. Br. mycol. Soc. 89: 353. 1987.
Typification: MALAYSIA, Pahang, Lepar Forest Reserve, on decaying submerged leaf, July 1986, A. J. Kuthubutheen KUM 515 (holotype IMI 312058). MALAYSIA, Pahang, Lepar Forest Reserve, on decaying submerged leaf, July 1986, A. J. Kuthubutheen (epitype designated here MBT 10004619, IMI 313452 dried culture and microscopic slide, ex-epitype culture IMI 313452).
Culture characteristics: On CMD: colonies 29–31 mm diam, circular, flat, margin fimbriate, cobwebby, mucoid toward the periphery, whitish, reverse isabelline. On MLA: colonies 26–30 mm diam, circular, raised, fimbriate to weakly undulate, velvety-lanose, floccose, finely furrowed, whitish or with irregular salmon patches at the centre, ochre-beige at the margin, pale ochre pigment diffusing into agar, reverse pale ochre-beige. On OA: colonies 17–20 mm diam, circular, flat, margin entire, velvety to cobwebby, aerial mycelium on the inoculation block with numerous cinnamon exudates, whitish, pale ochre pigment diffusing into agar, reverse pale cinnamon. On PCA: colonies 27–33 mm diam, circular, flat, margin rhizoidal, cobwebby becoming mucoid, ochre-beige, reverse of similar color. Sporulation was moderate on CMD, absent on MLA, OA, and PCA.
Colonies on CMD effuse, hairy, mycelium composed of branched, septate, hyaline hyphae 1.5–3 μm diam. Anamorph. Setae 170–225 μm long, 4.5–5 μm wide near the base, single or arise in groups of two from dark hyphal stromata, erect, straight or flexuous, septate, smooth, brown and thick-walled, paler and thinner-walled toward the apex, unbranched, apex subhyaline, bluntly rounded, sterile, occasionally terminating into a monophialide. Conidiophores 46–97 μm long, 4–5 μm wide near the base, macronematous, arise in fascicles of 3–10 from dark hyphal cells, usually aggregated around the base of the setae, erect, straight or flexuous, septate, smooth, pale brown, paler toward the tip. Conidiogenous cells 12.5–19(–33) × 3.5–4.5 μm tapering to 1.5–2 μm below the collarette, integrated, terminal, mono- rarely polyphialidic with one lateral opening while internally septa can be formed, extending sympodially, rarely percurrently, cylindrical, pale brown, subhyaline at the apex; collarettes 4.5–6.5 μm wide, 1.5–3.5 μm deep, widely funnel-shaped, slightly stipitate, pale brown to subhyaline. Conidia 16–19.5 × 2.5–3.5 μm (mean ± SD = 17.9 ± 1.1 × 3.0 ± 0.4 μm), oblong-falcate, 1-septate, slightly constricted at the septum, hyaline, rounded at each end, with a bifid setula at each end, occasionally with a bifid setula at one end and a trifid setula at the other, setulae straight or gently curved, 8–15 μm long, positioned terminally, conidia accumulate in slimy whitish fascicles. Teleomorph. Unknown.
Habitat and geographical distribution: Saprobe on submerged leaves, known from Malaysia only [19]. According to GlobalFungi, the identical sequences were found in two soil samples from the forest biome in the Caribbean (Trinidad and Tobago) [185]. The site has a tropical climate (MAT avg. 26 °C, MAP avg. 2511 mm).
Notes: Kuthubutheen [19] listed two specimens in the protologue of S. ramulosetula but only one number to indicate the holotype IMI 312058. Based on comparison with the holotype material in the Kew herbarium, the locality of the first specimen is the place of collection of the holotype. An unpublished strain of S. ramulosetula IMI 313452, collected in the same locality as the holotype and deposited by A.J. Kuthubutheen, was obtained from the CABI culture collection. A specimen in the Kew herbarium with the identical accession number, deposited as the microscopic slide and dried culture, is selected as the epitype in this study.
Stilbochaeta ramulosetula is well distinguished from other members of the genus by bifid and trifid setulae inserted at each end of conidia. It is closely related to S. malaysiana and S. novae-guineensis; these species share 1-septate conidia and setae that are predominantly sterile but occasionally terminate into a monophialide.
Stilbochaeta septata (B. Sutton & Hodges) Réblová & Hern.-Restr., comb. nov. MycoBank MB 842219. (Figure 34 and Figure 42).

Figure 42.
Stilbochaeta septata (CBS 146716). (A–E) Setae with conidiophores (F–I) conidia. Images: (A,B,F,G) from nature (C,H,I) on PCA after 4 weeks (D,E) on OA after 4 weeks. Scale bars: (A–C) 20 μm; (D–I) 10 μm.
Basionym. Codinaea septata B. Sutton & Hodges, Nova Hedw. 26: 520. 1975.
≡ Dictyochaeta septata (B. Sutton & Hodges) Aramb. & Cabello, Mycotaxon 34: 682. 1989. (Nom. inval., Art. 41.4).
≡ Dictyochaeta septata (B. Sutton & Hodges) Whitton, McKenzie & K.D. Hyde, Fungal Divers. 4: 148. 2000.
Description on the natural substrate: Colonies effuse, hairy, brown composed of setae and conidiophores, mycelium immersed. Anamorph. Setae 245–260 μm long, 3–5 μm wide near the base, arise singly or in groups of 2–3 from knots of dark brown hyphal cells, erect, straight or flexuous, septate, smooth, dark brown and thick-walled, paler and thinner-walled toward the apex, unbranched, apex subhyaline to hyaline, sterile, bluntly rounded. Conidiophores macronematous, unbranched, usually reduced to sessile or stalked conidiogenous cells, 34–37 × 3–4 μm tapering to ca. 1.5 μm below the collarette, arise singly or in groups of 2–6 from knots of hyphal cells around the base of the setae, smooth, integrated, terminal, mono- occasionally polyphialidic with one lateral aperture, extending sympodially, cylindrical, pale brown to subhyaline, paler toward the tip; collarettes 2.5–3 μm wide, ca. 2 μm deep, funnel-shaped, subhyaline. Conidia 14–15.5 × 2–2.5(–3) μm (mean ± SD = 14.9 ± 0.6 × 2.3 ± 0.2 μm), falcate, tapering toward both ends, with an inconspicuous basal scar, 1-septate, hyaline, with a straight or gently curved setula at each end 5.5–9 μm long, inserted terminally at the apex, subterminally at the base, conidia accumulate in slimy whitish fascicles. Teleomorph. Unknown.
Culture characteristics: On CMD: colonies 28–30 mm diam, circular, flat, margin entire to weakly fimbriate, velvety-lanose, mucoid at the margin, white becoming irregularly beige to brown toward the periphery due to densely aggregated sporulating conidiophores, isabelline at the margin, with a prominent outer zone of submerged growth, reverse pale ochre, isabelline toward the periphery. On MLA: colonies 33–34 mm diam, circular, raised or crateriform, margin entire, velvety-lanose, furrowed, later developing cracks in folds, white, sepia at the margin, pale ochre pigment diffusing into the agar, reverse dark cinnamon. On OA: colonies 49–50 mm diam circular, raised, margin entire, velvety-lanose, locally mucoid, smooth, white becoming ash grey due to densely aggregated sporulating conidiophores, cinnamon at the margin, sometimes pale cinnamon pigment diffusing into agar, reverse ochre-brown. On PCA: colonies 48–49 mm diam, circular, flat, margin entire, velvety becoming cobwebby, mucoid toward the periphery, white-ochre, pale olivaceous isabelline at the margin, with a zone of submerged growth, reverse ochre. Sporulation was abundant on OA and PCA, moderate on MLA, absent on CMD.
Colonies on CMD effuse, hairy, mycelium composed of branched, septate, hyaline to subhyaline hyphae 1.5–3 μm diam. Anamorph. Setae similar to those from nature, 138–192 μm long, 3.5–4.5 μm wide near the base, arise in groups from knots of dark brown cells, unbranched, apex pale brown to subhyaline, sterile, bluntly rounded or terminating into a mono- or polyphialide. Conidiophores 34–76(–92) μm long, 3–4.5 μm wide near the base, macronematous, single or arise in fascicles of 2–4 from knots of dark hyphal cells around the base of the setae, erect, straight or flexuous, septate, smooth, unbranched, brown, paler toward the tip. Conidiogenous cells 20–26.5 × 3.5–4 μm tapering to 1.5–2 μm below the collarette, integrated, terminal, monophialidic, occasionally polyphialidic with 1–2 lateral openings, extending percurrently and sympodially, subcylindrical, pale brown, subhyaline toward the tip; collarettes 3.5–4 μm wide, 1.5–2.5 μm deep, funnel-shaped, subhyaline. Conidia similar to those from nature, 13.5–16 × 2–3 μm (mean ± SD = 14.7 ± 0.8 × 2.3 ± 0.3 μm), falcate, 1-septate, setulae 6.5–10 μm long, accumulate in slimy whitish fascicles. Teleomorph. Unknown.
Specimens examined: AUSTRALIA, New South Wales, Yarramulong, Nunkeri Native Flowers, on a fallen leaf of Melaleuca viminalis, 23 August 1999, K.A. Seifert K.A.S. 1112 (culture CBS 146716). CHILE, on leaves of Eucalyptus grandis × urophylla, June 2010, M.J. Wingfield (culture ex-epitype CBS 143386).
Habitat and geographical distribution: Saprobe on leaves of Eucalyptus grandis, E. grandis × urophylla, Eucalyptus sp. and Melaleuca viminalis, known from Africa, Australasia and South America: Australia, Brazil, Chile, and South Africa ([31,81,187], this study).
According to GlobalFungi, the identical sequences were found in 33 samples, in forest soil in Australia (29 samples) [169,188,189] and rhizosphere soil from grasslands in Africa (four samples, South Africa) [190]. The sites have temperate climate (MAT avg. 16.4 °C, MAP avg. 884 mm).
Notes: Our specimen CBS 146716 from Australia differs from the holotype described from fallen Eucalyptus sp. leaves in Brazil [31] in slightly longer setae and shorter conidia. The setae have sterile, subhyaline, obtusely rounded apex on material from nature, in culture the apex is modified into a mono- or polyphialide. The conidial length corresponds to the lower range given in the protologue, (14.5–)17.5–23 μm [31]. In the present phylogeny, our strain grouped with the ex-epitype strain of S. septata [82]; they share nearly identical ITS and tef1-α sequences, which differ in one base pair in each gene.
Stilbochaeta septata resembles S. novae-guineensis in septate conidia with a simple setula at each end and sterile or fertile setae, but conidia of the latter species are 0–1-septate vs. 1–2-septate and slightly wider with longer setulae. It is difficult to distinguish S. septata from S. cangshanensis [29] because the size of their setae, conidiophores and conidia overlap. The two species are shown to be closely related in the present phylogeny but are well distinguished using ITS and tef1-α sequences. The genetic distances between the ex-type strain of S. cangshanensis and ex-epitype strain of S. septata are 4.0% in the ITS and 3.6% in tef1-α genes corresponding to the sequence identities of 96.6% and 96.5%, respectively.
Stilbochaeta submersa (Z.L. Luo, K.D. Hyde & H.Y. Su) Réblová & Hern.-Restr., comb. nov. MycoBank MB 842220.
Basionym. Dictyochaeta submersa Z.L. Luo, K.D. Hyde & H.Y. Su, Fungal Divers. 99: 597. 2019.
For description and illustration, see Luo et al. [29].
Habitat and geographical distribution: Saprobe on decaying wood, known only from Asia, China [29]. The database GlobalFungi did not contain similar sequences (≥98%) of this species.
Notes: Although the conidia were described as aseptate, the photographs accompanying the protologue [29] show 0–1-septate conidia, which is in accordance with the generic concept of Stilbochaeta. Stilbochaeta submersa resembles S. aquatica [28] in the conidial size and monophialidic conidiogenous cells, but the latter species differs in shorter conidiophores.
3.5.5. The Genus Tainosphaeria
Tainosphaeria F.A. Fernández & Huhndorf, Fungal Divers. 18: 44. 2005.
Notes: Tainosphaeria is a holomorphic genus characterized by perithecial ascomata, unitunicate asci, hyaline, transversely septate ascospores, and Codinaea-like anamorphs [57]. Members of the genus form effuse colonies of pigmented conidiophores terminating into a mono- or polyphialides and have hyaline, aseptate conidia with setulae. Tainosphaeria became heterogeneous after the acceptance of several anamorphic species with different morphology [29,30]. Réblová et al. [49] re-evaluated the generic concept of Tainosphaeria and showed correlation between molecular and morphological data, followed by the segregation of its species into three genera, namely Tainosphaeria s. str., Phialoturbella [49] and Phialogeniculata [191]. Li et al. [192] described another two Tainosphaeria species that do not match the concept of the genus. They are treated in this study, see Tainosphaeriella.
Revision of three former Codinaea species, namely C. parva, C. simplex, and C. vulgaris, described by Hughes and Kendrick [2] from decaying plant material from New Zealand revealed that they are remarkably similar to members of Tainosphaeria. Although their cultures or DNA data are not available, based on a detailed morphological comparison of their type material, original descriptions, illustrations and data on geographical distribution, they were transferred to Tainosphaeria and new combinations are proposed below. For additional information, see Section 4.5.
Several other species, such as Dictyochaeta brachysetula and D. chinensis [193], D. coffeae [8], D. longispora [2], and D. unisetula [194] resemble Tainosphaeria in characters of conidiophores, conidiogenous cells and conidia to some extent. However, their cultures or molecular data to verify such relationships are not available.
Tainosphaeria parva (S. Hughes & W.B. Kendr.) Réblová & Hern.-Restr., comb. nov. MycoBank MB 842221. (Figure 43).

Figure 43.
Tainosphaeria parva (DAOM 93565d isotype). (A) Substrate with colonies (B–E) conidiophores (F,G) tips of the conidiogenous cells (H) conidia. Images: (A–H) from nature. Scale bars: (B) 500 μm; (C–H) 10 μm.
Basionym. Codinaea parva S. Hughes & W.B. Kendr., N. Z. J. Bot. 6: 354. 1968.
≡ Dictyochaeta parva (S. Hughes & W.B. Kendr.) Hol.-Jech., Česká Mykol. 42: 204. 1988.
For description and illustrations, see Hughes and Kendrick [2].
Specimen examined: NEW ZEALAND, West Coast region, Westland district, Pukekura, Lake Ianthe, on decaying bark of Weinmannia racemosa, 8 April 1963, S.J. Hughes 569d (isotype of Codinaea parva DAOM 93565d).
Habitat and geographical distribution: Tainosphaeria parva is a saprobic species found mainly in the Southern Hemisphere. Originally, it was described from the bark of Weinmannia racemosa in New Zealand [2]. Additional specimens have been recorded on fallen leaves of Nothofagus solandri also from New Zealand [145] and Pandanus hornei and P. tectorius from Seychelles [44]. Holubová-Jechová [195] recorded this species on a dead petiole of Calyptrogyne dulcis in Cuba.
Notes: Our observations of the isotype match the protologue of this species. Tainosphaeria parva is characterized by mono- and polyphialidic conidiogenous cells and conidia with short appendages, which are the shortest (2–4 μm long) among other species of the genus.
Tainosphaeria simplex (S. Hughes & W.B. Kendr.) Réblová & Hern.-Restr., comb. nov. MycoBank MB 842222. (Figure 44).

Figure 44.
Tainosphaeria simplex (DAOM 96020g isotype). (A) Substrate with colonies (B–G) conidiophores (H) colony on wood (I) conidia. Images: (A–H) from nature. Scale bars: (B–G,I) 10 μm; (H) 500 μm.
Basionym. Codinaea simplex S. Hughes & W.B. Kendr., N. Z. J. Bot. 6: 362. 1968.
≡ Dictyochaeta simplex (S. Hughes & W.B. Kendr.) Hol.-Jech., Folia geobot. phytotax. 19: 434. 1984.
For description and illustrations, see Hughes and Kendrick [2].
Specimen examined: NEW ZEALAND, West Coast region, Westland district, Pukekura, Lake Ianthe, on bark of Weinmannia racemosa, 8 April 1963, S.J. Hughes 560g (isotype of Codinaea simplex DAOM 96020g).
Habitat and geographical distribution: Tainosphaeria simplex is a saprobe, originally described from bark and wood of an evergreen shrub Weinmannia racemosa [2]. In addition, it occurs on fallen leaves, herbaceous stems and decaying woody fruits of Castanopsis sp., Cedrela odorata, Didelotia idea, Diospyros sanza-minika, Dichapetalum toxicarium, Eucalyptus sp., Fagus sylvatica, Freycinetia banksia, Memecylon donianum, Nothofagus fusca, Pandanus furcatus, P. seychellarum, P. tectorius, Podocarpus macrophyllus, Q. virginiana, Quercus sp., Rubus sp., and Socratea sp.
According to literature, it is one of the most common Tainosphaeria species and has been recorded from many localities in the temperate, subtropical and tropical geographical zones. According to Kirk [196], T. simplex is the most common species of the genus in British Isles based on herbarium records in the Kew Herbarium. The species is known from Australia, Brazil, China, Cuba, Germany, Japan, Ivory Coast, Malaysia, New Zealand, Papua New Guinea, Seychelles, Solomon Islands, Taiwan, and United Kingdom [2,5,17,25,31,35,36,37,44,121,134,145,146,147,148,196,197,198].
A possible misinterpretation of the species concept of T. simplex ([2], as Codinaea simplex) with Codinaeella minuta is discussed in notes to the latter species. Codinaeella minuta resembles T. simplex, but differs in having an upper layer of setiform conidiophores. Analysis of environmental ITS sequences from GlobalFungi supports the theory that Tainosphaeria and Ca. minuta have distinct regions of distribution; Tainosphaeria is primarily distributed in Australasia and Southeast Asia and in Central America, while Ca. minuta has a much wider range of distribution in the temperate Northern Hemisphere. Given the similarity of the two species, published records on distribution of T. simplex should be verified using DNA data.
Notes: Our observations of the isotype are in agreement with the protologue. The conidiophores were densely aggregated on the substrate surface, but slightly shorter ca. 38–68 μm long, mostly monophialidic or with 1(–2) phialidic apertures and conidia 15–20.5 × 2.5–3 μm with setulae 6–8(–9) μm long compared to the protologue.
Tainosphaeria vulgaris (S. Hughes & W.B. Kendr.) Réblová & Hern.-Restr., comb. nov. MycoBank MB 842223. (Figure 45).

Figure 45.
Tainosphaeria vulgaris. (A–E,O,P) Conidiophores (O) associated with conidiophores of Helicoma sp. (F,G) tips of the phialides (H–J,M,N) conidia (K) substrate with colonies (L) colony on wood, in detail. Images: (A–D,H,I,K–P) from nature (E–G,J) on PCA after 4 weeks; (A–J) from PDD 119682 (K–P) from DAOM 97315b isotype. Scale bars: (A–E,O,P) 20 μm; (F,G) 5 μm; (H–J,M,N) 10 μm.
Basionym. Codinaea vulgaris S. Hughes & W.B. Kendr., N.Z. J. Bot. 6: 367. 1968.
≡ Dictyochaeta vulgaris (S. Hughes & W.B. Kendr.) Aramb. & Cabello, Mycotaxon 34: 682. 1989. (Nom. inval., Art. 41.4).
≡ Dictyochaeta vulgaris (S. Hughes & W.B. Kendr.) Whitton, McKenzie & K.D. Hyde, Fungal Divers. 4: 151. 2000.
Description on the natural substrate: Colonies effuse, olivaceous-brown to amber, composed of conidiophores, mycelium immersed. Anamorph. Setae absent. Conidiophores 62–120 μm long, 4–5 μm wide near the base, macronematous, crowded, arise singly or in groups, sometimes aggregate in loose columns, unbranched, erect, straight or flexuous, slightly geniculate, septate, smooth, brown, paler toward the apex. Conidiogenous cells 14.5–30 × 3–3.5 μm tapering to 1.5–2 μm below the collarette, integrated, terminal, mono- and polyphialidic with 2–15 lateral openings while internally septa can be formed, extending percurrently and sympodially, cylindrical, pale brown, subhyaline at the apex, usually bearing persistent remnants of the collarettes; collarettes 3–4 μm wide, 1.5–2 μm deep, funnel-shaped, subhyaline to pale brown, the apical part soon evanescent. Conidia (16–)18–20 × 2–2.5 μm (mean ± SD = 18.4 ± 1.0 × 2.3 ± 0.2 μm), falcate, tapering toward both ends, narrowly rounded apically, slightly truncate at the base with an inconspicuous basal scar, aseptate, hyaline, with straight or gently curved setula at each end 2.5–4.5 μm long, inserted terminally at the apex, subterminally at the base, conidia accumulate in slimy yellow-ochre fascicles. Teleomorph. Unknown.
Culture characteristics: Colonies on PCA effuse, mycelium composed of branched, septate, subhyaline to pale brown hyphae 1.5–2.5 μm diam. Setae absent, conidiophores, conidiogenous cells and conidia similar to those from nature. Conidiophores 90–120(–150) μm long, 3.5–4 μm wide above the base, unbranched, erect, straight, flexuous or undulating, mid brown, paler toward the apex. Conidiogenous cells 15–33 × 3–4 μm tapering to 1.5–2 μm below the collarette, integrated, terminal, monophialidic, cylindrical, pale brown, subhyaline at the apex; collarettes 3–4.5 μm wide, 2–2.5 μm deep, funnel-shaped, subhyaline. Conidia (16.5–)18–21 × 2.5(–3) μm (mean ± SD = 19.1 ± 1.5 × 2.6 ± 0.2 μm), falcate, hyaline, aseptate, setulae 2–3.5 μm long, aggregated in slimy ochre fascicles.
Specimens examined: NEW ZEALAND, Wellington province, Tongariro National Park, Silica Springs Track, Whakapapanui stream, on bark of Fuscospora cliffortioides, 5 March 1963, S.J. Hughes 432b (isotype of Codinaea vulgaris DAOM 97315b). NEW ZEALAND, West Coast region, Buller district, Victoria Forest Park, Lyell, Lyell Historical Walk, on decaying wood of a branch, 6 April 2005, M. Réblová M.R. 3447/NZ 731 (PDD 119682).
Habitat and geographical distribution: Saprobe on decaying bark and wood of a wide range of hosts in New Zealand, i.e., Fuscospora cliffortioides, Nothofagus truncata, Quintinia serrata, Rubus sp., Weinmannia racemosa and other unknown hosts ([2], this study), and leaves of Pandanus seychellarum in Seychelles [44].
Notes: The species was recollected in New Zealand and isolated into axenic culture, where it yielded sporulating conidiophores similar to those from nature. Although conidiogenous cells were polyphialidic with numerous successive lateral apertures on the nature substrate, conidiogenous cells remained monophialidic when grown in culture. Unfortunately, the strain is no longer viable. A description and illustration based on the recent material is given above; our observations agree with the protologue of T. vulgaris.
Tainosphaeria vulgaris is similar to T. parva in the geniculate appearance of conidiophores and relatively short conidial setulae up to 5 μm long. Tainosphaeria parva differs from T. vulgaris in shorter conidia. The conidia of T. vulgaris are arranged in ochre fascicles, while the conidial heads of other Tainosphaeria species were reported white.
3.5.6. The Genus Tainosphaeriella
Tainosphaeriella Réblová & Hern.-Restr., gen. nov. MycoBank MB 842003.
Type species. Tainosphaeriella aquatica (X.D. Yu, C.X. Li & H. Zhang) Réblová & Hern.-Restr.
Etymology: Tainosphaeria and -ella (L) diminutive but here used as a name-forming suffix, referring to fungi morphologically similar to Tainosphaeria.
Colonies on natural substrate effuse, pale to dark brown, mycelium partly superficial, partly immersed. Anamorph. Setae absent. Conidiophores macronematous, mononematous, single, erect, straight or slightly flexuous, unbranched, septate, smooth, brown, paler toward the apex. Conidiogenous cells integrated, terminal, phialidic; collarettes flared, campanulate. Conidia falcate, cylindrical to fusiform or ellipsoidal-fusiform, slightly curved, transversely septate, hyaline, occasionally laurel green at maturity, with a straight or gently curved setula at each end, conidia accumulate in slimy whitish or ochre fascicles. (Adapted after Li et al. [192]). Teleomorph. Unknown.
Habitat and geographical distribution: Members of Tainosphaeriella occur on submerged decaying wood and are only known from Southeast Asia, Thailand [192].
Notes: The genus Tainosphaeriella (Ta.) is described for two species with 1–3-septate, setulate conidia borne on monophialidic conidiogenous cells with campanulate to almost disk-like collarettes and unbranched conidiophores. Originally, they were placed in Tainosphaeria by Li et al. [192], but molecular data do not support such relationship. In the present phylogenetic analysis, the two species are unrelated to Tainosphaeria crassiparies, the type species, and other species of Tainosphaeria. Instead, they grouped as a sister clade to Phialogeniculata guadalcanalensis and Phialoturbella spp.
Two Dictyochaeta species, D. macrospora and D. variabilis [23,24] resemble Tainosphaeriella. Both species are native to Malaysia and are found on submerged leaves or decaying palm fronds in terrestrial environments. Unfortunately, their living cultures or DNA sequences are not available for study.
Tainosphaeriella aquatica (X.D. Yu, C.X. Li & H. Zhang) Réblová & Hern.-Restr., comb. nov. MycoBank MB 842224.
Basionym. Tainosphaeria aquatica X.D. Yu, C.X. Li & H. Zhang, Phytotaxa 509: 60. 2021.
For description and illustration, see Li et al. [192].
Habitat and geographical distribution: Saprobe on decaying submerged wood, known only from Southeast Asia, Thailand [192].
Notes: Tainosphaeria aquatica closely resembles D. variabilis [24], which differs in having longer conidia.
Tainosphaeriella thailandensis (W. Dong, C.X. Li & H. Zhang) Réblová & Hern.-Restr., comb. nov. MycoBank MB 842225.
Basionym. Tainosphaeria thailandensis [as thailandense] W. Dong, C.X. Li & H. Zhang, Phytotaxa 509: 61. 2021.
For description and illustration, see Li et al. [192].
Habitat and geographical distribution: Saprobic on decaying submerged wood, known only from Southeast Asia, Thailand [192].
Notes: This species has lightly pigmented conidia that turn laurel green at maturity, making it easily distinguishable from Ta. aquatica with conidia hyaline at maturity.
3.5.7. The Genus Xyladelphia
Xyladelphia Réblová, A.N. Mill. & Hern.-Restr., gen. nov. MycoBank MB 842004.
Type species. Xyladelphia longiseta (F.A. Fernández & Huhndorf) Réblová, A.N. Mill. & Hern.-Restr.
Etymology: Xýlon (Greek) wood, referring to the lignicolous habitat; adélphia (Greek), siblings, referring to two morphs occurring together.
Colonies on natural substrate effuse, hairy, brown, composed of setae, conidiophores and ascomata, mycelium immersed. Anamorph. Setae grow singly, erect, straight or flexuous, septate, brown, unbranched, always sterile, tapering to an acute apex, sometimes two most apical cells dark brown. Conidiophores macronematous, mononematous, arise singly or in groups, scattered among the setae, unbranched, erect, straight or flexuous, septate, brown, smooth. Conidiogenous cells integrated, terminal, mono- and polyphialidic, extending percurrently and sympodially; collarettes flared. Conidia of two morphologically distinct types; macroconidia falcate to fusiform, aseptate, hyaline, with straight or gently curved setula at each end; microconidia (formed only in vitro) ellipsoidal, aseptate, hyaline to pale brown, without setulae; macroconidia and microconidia accumulate in slimy whitish fascicles. Teleomorph. Ascomata perithecial, non-stromatic, superficial, subglobose to broadly ovoid, papillate, dark brown, setose; setae sterile, acute at the apex, identical to those of the anamorph. Ostiole periphysate. Ascomatal wall, carbonaceous, two-layered. Paraphyses septate, tapering. Asci unitunicate, cylindrical-clavate, shortly-stipitate, apically rounded, ascal apex with a non-amyloid apical annulus. Ascospores broadly fusiform to ellipsoidal, hyaline, aseptate or transversely septate, without gelatinous sheath or appendages (Adapted after Fernández and Huhndorf [57]).
Habitat and geographical distribution: Saprobes on decaying plant matter, found in the Central, North and South America.
Notes: In the present phylogeny, Xyladelphia was shown distantly related to Codinaea and other morphologically similar genera. It formed a separate lineage near the base of the tree among taxa with non-setulate conidia.
Although the arrangement of setae and conidiophores is similar to members of Codinaeella, the setae are darker in the uppermost part and have sterile, acute apex. Xyladelphia clustered as a sister to Dictyochaeta brevis [30], which lack setae and somewhat resembles Tainosphaeria. Due to inconsistencies in morphology, the latter species is not accepted in Xyladelphia and for now we prefer to keep it separate until more morphological data, in vitro observations, teleomorph and other representatives are available for study.
Xyladelphia longiseta (F.A. Fernández & Huhndorf) Réblová, A.N. Mill. & Hern.-Restr., comb. nov. MycoBank MB 842226.
Basionym. Chaetosphaeria longiseta F.A. Fernández & Huhndorf, Fungal Divers. 18: 28. 2005.
For description and illustration, see Fernández and Huhndorf [57].
Habitat and geographical distribution: Saprobic on decaying wood of twigs and branches, known from the tropical zone of Central and South America from Costa Rica, Ecuador and Puerto Rico, and also from the subtropical zone of the USA, South Carolina [57].
Notes: Xyladelphia longiseta is the only member of the genus and a known representative of this conspicuous morphotype. It somewhat resembles Codinaea setosa [2], which differs in septate conidia without setulae. Dictyochaeta australiensis [7] can be compared with the present species, but differs in longer setae that are undulate in the upper part and shorter conidia with longer setulae.
4. Discussion
4.1. Phylogeny and Taxonomy of Codinaea: An Exercise in Morphology
In this study, we provide evidence to resolve the intriguing complex of Codinaea and similar fungi. The genus Codinaea was re-evaluated and newly circumscribed using molecular, morphological and geographical data. Several other Codinaea-like, Dictyochaeta-like and Tainosphaeria species were reclassified and segregated into new genera in the Chaetosphaeriaceae, namely Codinaeella, Nimesporella, Stilbochaeta, Tainosphaeriella and Xyladelphia. The morphological separation of Codinaea and five other genera listed above is consistent with their phylogenetic relationships. The results of the phylogenetic analyses based on the three-locus dataset strongly support the synonymy of Bahusutrabeeja, Codinaeopsis and Phialolunulospora under Codinaea. In addition, new combinations of three other Codinaea species were proposed in Tainosphaeria based on detailed morphological and geographical comparison. Genera and their morphotypes, historically associated with Codinaea and Dictyochaeta, are illustrated in Figure 46 and Figure 47.

Figure 46.
Morphotypes of Codinaea and similar genera with setulate conidia. Conidia and pigments formed in vitro are shown in the central (white) part of the wheel. The arrangement of conidiophores with setae, if present, of each genus, along with the morphology of the phialide (i.e., with a terminal or lateral opening) and colony characters are shown in the outer (grey) part of the wheel. Pigments diffusing in MLA and OA are shown by their respective colors and colony images; if no pigment is formed, the place at the centre is blank, n/a indicates that this information is not available.

Figure 47.
Morphotypes of Dictyochaeta and similar genera with non-setulate conidia. Legend as in Figure 46.
There are no known teleomorphs in Codinaea, Codinaeella and other segregates, and only one in Stilbochaeta and Tainosphaeria. Identification therefore depends largely on anamorphic microscopic characters, such as: (1) The presence or absence of setae, shape of the uppermost part and their arrangement with the conidiophores; (2) morphology of conidiophores, presence or absence of a sterile extension and their branching pattern; (3) shape, color and number of conidiogenous cells, position on the conidiophore, mode of elongation and morphology of the collarette; (4) septation, shape, color, and size of conidia; (5) presence or absence of setulae, their number and position on conidia; and finally (6) production of pigments in vitro.
The results of this study do not support the conclusions about the taxonomy of Codinaea proposed by Arambarri and Cabello [13]. Characters such as branched or unbranched conidiophores, mono- and polyphialides, percurrent or sympodial elongation of the conidiogenous cell were revealed to be uninformative at the generic level. On the other hand, some characteristics have been shown to be informative for distinguishing among genera, e.g., (1) the arrangement of setae and conidiophores, (2) morphology of the conidiogenous cell, (3) conidial septation (and to some extent also the shape), and (4) presence or absence of setulae. We found that conidial septation may be in some genera a diagnostic character, but in some genera like Menispora, species with both septate and aseptate conidia occur (ancestral polymorphism). Another example is the genus Stilbochaeta, where conidia with and without septa occur, but both types are present in every species. See also Section 3.3 and Section 4.4. on ancestral state reconstruction.
The phylogenetic analysis revealed that the evolution of some morphological traits is correlated and that these traits, which were previously used to delimit taxa at the genus rank, occur together in species newly shown to be congeneric. For example, we found that branched and unbranched conidiophores and lateral and terminal phialides can occur in species within the same genus. Of the above genera, only Codinaea and Codinaeella include species with more than one morphotype in terms of conidiophore morphology, arrangement of conidiophores and setae, and position of the phialides; and only Codinaea encompasses species with more than one conidial shape. On the other hand, morphology of species of the other genera is relatively uniform. Several different morphotypes and their combinations, which form a parallel to those revealed in Codinaea and Codinaeella, have evolved in genera such as Menispora and Chloridium sect. Chloridium, and offer an interesting comparison. In addition, these monophyletic genera reside in a strongly supported cluster (99/1.0) suggesting a shared evolutionary history. In Figure 2B, a robust clade (98/1.0) is marked, which includes most taxa with setulate conidia in the Chaetosphaeriaceae with a few exceptions, such as Flectospora, Phialoturbella and Phialogeniculata. Interestingly, taxa with setulate conidia are rare in the remaining part of the tree and are represented by Dictyochaeta brevis (inc. sedis) and Xyladelphia longiseta, which clustered near the base of the tree.
In the present phylogeny, Menispora (100/1.0) is represented by six species that exhibit four morphotypes (M1–M4, Figure 8) hitherto associated with the genus and distinguished based on the arrangement of setae and conidiophores and the conidiophore structure. Similar to Codinaea, phialides are integrated, terminal or discrete, lateral on the conidiophores, stalks or short branches. The Menispora morphotypes are as follows: (1) sterile acute setae are arranged in fascicles with simple, shorter conidiophores with a terminal phialide (morphotype M1: M. britannica), (2) the upper part of the conidiophore has a sterile, whip-like extension, while the lower part is fertile, phialides are lateral, borne singly directly on the conidiophore or stalks or they are terminal on short branches, conidiophores are sometimes accompanied by simple setae resembling conidiophores (M2: e.g., M. caesia, M. ciliata, M. glauca), (3) conidiophores are similar to the previous type, but setae are absent, phialides are lateral, borne in groups on densely branched stalks (M3: M. tortuosa), or (4) sterile setae with a whip-like sterile uppermost part are interspersed among shorter, simple conidiophores bearing a terminal phialide (M4: M. uncinata). Similar to Codinaea, conidia of Menispora also show a certain degree of variability, but mainly in the septation and presence or absence of setulae.
Although these four different morphotypes are widely recognized in Menispora, similar variability has never been considered in Codinaea. The Codinaea clade is delimited by a strongly supported node in the three-gene phylogeny and is associated with four different morphotypes (Figure 8C1–C4) that are irregularly distributed in this cluster. Molecular data suggest that the conidial shape varies within a genus. Conidia are predominantly falcate, lunate to navicular or occasionally vermiform, but sometimes also ellipsoidal, ellipsoidal-fusiform, and even globose to pyriform. In addition, the number of setulae and their position on conidia vary among species. However, color and septation seem to be constant features in the genus and conidia are always hyaline and aseptate. Species with the morphotypes C1, C3, and C4 always have falcate to lunate conidia, while the morphotype C2 is associated with a wide range of conidial shapes. The morphotypes C1 and C3 in Codinaea correlate with the morphotypes M1 and M3 in Menispora, respectively. However, while morphotype C1 in Codinaea is interspersed among the other three, in Menispora the equivalent morphotype M1 occupies a basal position and is shown as a sister to a more species-rich subclade. Although M. britannica, the only known representative of the M1 morphotype, was originally placed in Codinaea [199], later it was transferred to Menispora by Kirk [200].
Réblová [201] pointed out the remarkable similarity between Codinaea and Menispora and that species attributed to Menispora have exactly the same characteristics as Codinaea with the exception of the uppermost part of the phialide and the conidiophore structure. The author speculated that Codinaea could be included in Menispora as a synonym, but at the same time proposed that the relationship of Codinaea with Codinaeopsis, Dictyochaetopsis and Menispora required further investigation. The present phylogenetic analysis confirms the distinction of Codinaea and Menispora and that species, despite having similar morphotypes, should be retained in separate genera. The unifying feature of members of Menispora is the narrow, strongly recurved uppermost part of the conidiogenous cell ending in a short and indistinct collarette, having a beak-like appearance.
Codinaeella is another genus that shows similar variation in the conidiophore structure as Menispora. It has been associated with two morphotypes, CA1 and CA2, which are equivalent to M4 and M2 in Menispora, respectively (Figure 8). The characters of conidia of Codinaeella are uniform; species have hyaline, aseptate, falcate conidia with a single setula at each end.
Codinaea and Codinaeella are also comparable to Chloridium. In our phylogeny, four species and three morphotypes represent Chloridium sect. Chloridium (CH1–CH3, Figure 8). Chloridium virescens, the type species, is characterized by simple conidiophores with terminal monophialides interspersed among similar, but longer setiform conidiophores, which are sometimes associated in loose bundles (morphotype CH1). Morphotypes consisting of conidiophores forming a single layer are also common in Chloridium and they are represented by Chl. submersum (CH2) in the phylogeny. Although Chloridium historically included only species with unbranched conidiophores and terminal phialides [39], and later it was divided into three sections according to the presence of single or multiple conidiogenous loci and elongation of the conidiogenous cell [202], preliminary molecular analysis suggested that it is congeneric with Gonytrichum [203]. The latter genus included species with anamorphs and teleomorphs remarkably similar to those of Chloridium, but distinct in the presence of branched conidiophores and lateral conidiogenous cells arising on collar and nodose hyphae. In our phylogeny, Chl. caesium and Chl. gonytrichii represent the CH3 “Gonytrichum” morphotype. Chloridium and Codinaea (i.e., C. gonytrichodes) are the only genera in the family that include species with discrete phialides growing from collar and nodose hyphae. In both genera this morphological trait (C4 in Codinaea and CH3 in Chloridium) occurs together with a morphotype of unbranched solitary conidiophores without setae (C2 and CH2). The main Chloridium CH1 morphotype also correlates with the main CA1 morphotype of Codinaeella and partly also with the C1 of Codinaea. In these three genera we see that species with simple conidiophores and terminal phialides and species with branched conidiophores and lateral phialides occur together.
Although we have been able to collect a number of species that represent most of the known Codinaea, Codinaea-like and Dictyochaeta-like morphotypes, we lack information on the evolutionary relationships of species that exhibit morphotypes different from those analyzed in this study. For example, species of Codinaea with synnematous conidiophores [2,20,204] are missing in the current phylogeny. A unique morphotype of unknown systematic placement is represented by Codinaea eucalypti [31], which was described from leaves of Eucalyptus saligna from Brazil. The conidiogenous cells have flared to tubular collarette and are consistently intercalary along the entire length of the conidiophore with a single phialidic aperture per cell. The conidiophores are septate but the distance between the septa is significantly shorter than in the other known Codinaea or Codinaea-like species. Unfortunately, no ex-type or authentic strain or living cultures are available. Hernández-Restrepo et al. [81] introduced the genus Xyladictyochaeta in the Xylariales, which is similar to C. eucalypti, but differs in phialides with inconspicuous collarettes and denticles-like openings with multiple conidiogenous loci.
In the past, newly discovered morphological character(s) or their combinations often led to a proliferation of a new genus distinguished from Codinaea and Dictyochaeta, such as Codinaeopsis, Dictyochaetopsis, and Menisporella. Moreover, Dictyochaetopsis has become a heterogeneous collection of species, whose phylogenetic affiliations are largely unknown. Codinaeella filamentosa (formerly Dictyochaetopsis filamentosa) is the only representative of Dictyochaetopsis in the present phylogenetic analysis. However, the species is only the tip of the iceberg. Approximately six morphotypes can be recognized in Dictyochaetopsis, however, relationships of species with these morphotypes need to be verified using DNA sequences. These morphotypes (D1–D6) are illustrated in Figure 48.

Figure 48.
Morphotypes D1–D6 associated with Dictyochaetopsis s. lat. Morphotypes D1: Di. apicalis, Di. glauconigra (=Dictyochaetopsis s. str.), D2: Di. antillana, Di. maharashtrensis, D3: Di. hamata, D4: Di. dingleyae, D5: and D6: Di. elegantissima, Di. intermedia and Di. menisporoides.
They include: Dictyochaetopsis s. str. (morphotype D1: Di. apicalis, Di. glauconigra) [132] and other five Dictyochaetopsis-like morphotypes (D2: Di. antillana, Di. maharashtrensis) [205,206], (D3: Di. hamata) [21], (D4: Di. dingleyae) [2], (D5: Di. brasiliensis) [207] and (D6: Di. elegantissima, Di. intermedia and Di. menisporoides) [26,32]. The three species of the D6 morphotype match the concept of Ca. filamentosa (morphotype CA2) and are discussed in the notes to the latter species. Relationships of other Codinaea and Dictyochaeta species lacking ex-type strains or living cultures and molecular data and that resemble the genera Achrochaeta, Codinaea s. str., Dictyochaeta s. str., Phialoturbella, Tainosphaeria, Tainosphaeriella and Tubulicolla, are discussed in this study in the notes to respective genera and also Réblová et al. [12,49].
4.2. Impact of Morphological Data Quality and Their Availability on Taxonomy
Taxonomy of Codinaea and similar fungi has been controversial and traditionally it has been based on microscopic morphology of structures observed on natural substrates and to a lesser extent in vitro, but rarely have both types of observations been included for comparison and evaluation. With the increasing use and availability of molecular data, new species have been described as either Codinaea or Dictyochaeta, but surprisingly without comparisons to previously described species. When sequences from new material do not match any of those in public repositories, new names were introduced but older and valid names were rarely considered. In several cases, the new taxa were based solely on in vitro features, which, as we have shown above, can be problematic when used alone. We therefore focused on evaluating both sets of traits, verifying strains obtained from culture collections, designating epitypes when available, and generating reference sequences, in particular ITS and tef1-α barcode sequences, to populate the genetic repositories enabling rapid and accurate species identification.
We faced several obstacles during this study. In general, working with non-type strains available in the culture collections poses a risk because they may be misidentified. A proverb “trust but verify” applies here more than ever. The revealed phylogenetic placement of several non-type strains of Codinaea and Dictyochaeta indicated that they are misidentified, which are now corrected here to avoid future erroneous conclusions. Their identification was challenging. Sometimes no herbarium material was deposited along with the strain and some strains were isolated from soil or plant tissues, thus only microscopic characters in vitro were available. Therefore, we grew strains on sterile stems of U. dioica on CMA and sterile pine needles on SNA. These media proved to be the best option to provide semi-natural conditions and induce sporulation and formation of conidiophores and setae. On other media used in this study, such as CMD, MLA, OA and PCA, fungi sporulated but often formed only conidiophores without setae. One example is Codinaea acaciae [53], where prolonged incubation was required for the development of all morphological structures. The species was isolated from leaf spots of Acacia mangium, but only simple conidiophores were described in the protologue. Its placement in the Codinaea clade, which contains species that commonly form bundles of setae and conidiophores under natural conditions, has raised the suspicion that there may be other features that we have not yet observed. Growth of this strain on CMA with Urtica stems for >8 weeks revealed a typical Codinaea C1 morphotype.
To sum up, cultivation and verification of several strains of Codinaea and Dictyochaeta allowed for their correct identification: CBS 139907 [53] ex-type strain of C. acaciae is C. assamica, ICMP 14613 and ICMP 15540 deposited as C. fertilis are Ca. lutea; MUCL 41171 [129] as Codinaeopsis gonytrichodes is C. amazonensis; CBS 194.96 as C. vulgaris is C. siamensis; MUCL 34876 as D. fertilis is C. paniculata [46]; MUCL 28054 as D. simplex is Ca. parvilobata; CBS 115959 as D. parva is Ca. minuta, IMI 233824 as D. parva is C. fertilis, and IMI 358908 as D. daphnioides is N. capillacea. In addition, strain GZCC 18-0017 [30] identified as C. simplex is Ca. lutea.
The identity of the ex-type strain CBS 114070 of Dictyochaeta curvispora was a bit of a mystery because it clustered with Stilbochaeta species, which have entirely different morphology. According to the protologue [181], D. curvispora has never sporulated in vitro and formed only sterile mycelium that diffused a yellow pigment into the agar. The yellow, gold, honey to pale apricot pigments were also produced on nutrient media used in this study. To reveal its identity, the species was inoculated on sterile Urtica stems on CMA, where it sporulated for the first time. We confirm that the ex-type strain of D. curvispora is a contamination and that the fungus deposited in its place is Stilbochaeta aquatica (Figure 33).
Revision of type and other herbarium material without the relevant DNA sequences and living cultures may be only of some benefit and may not yield the desired result; especially in groups such as Codinaea, Tainosphaeria and their allies, where the dimensions of conidia, conidiophores and setae often overlap. Although we proposed three new combinations in the absence of molecular data, our conclusions were supported by detailed morphological comparisons and geographical data. Revision of the holotypes of three former species of Codinaea, such as C. parva, C. simplex and C. vulgaris, indicated that they belong to Tainosphaeria. However, the proposed combinations have yet to be verified using DNA data.
The study of Codinaea and related fungi combining data from nature and culture is quite challenging. The diagnostic morphological traits develop best under natural conditions and do not appear to be significantly affected by host or substrate type. To reliably identify Codinaea and similar fungi, we therefore recommend obtaining microscopic characteristics from both natural substrate and culture, as in vitro observations alone may not be sufficient. Knowledge of the wild type is also necessary to identify older species with valid names whose sequences are not available. Endophytic strains or those isolated from soil, air, and other substrates should be inoculated on sterilized plant pieces placed on nutrient agar media to provide the best semi-nature conditions for development of diagnostic microscopic structures. The formation of pigments in culture is usually a supplementary character. The pigments were abundantly formed especially on MLA and OA in Codinaeella and Stilbochaeta and former Codinaea species now classified in Multiguttulispora [49]. It has been reported that the pigment production may be affected by cultivation techniques [208]. We observed a correlation between the volume of medium and intensity of the pigment diffused into the agar, and a reduction of aerial mycelium and also reverse color in Ca. minuta (Figure 27F–H and Figure 28) and Ca. lambertiae (not shown). Our observations are consistent with Raper and Fennell [208], who reported that the volume of media had an effect on colony diameter and also on reverse color, sporulation, production of exudates, and formation of sclerotia in Penicillium. For some other groups of hyphomycetous fungi, especially ubiquitous or medically important, in vivo morphology is not as essential and instead the emphasis is on techniques aimed at standardizing cultivation parameters to make taxonomic work reproducible, as is notoriously the case with Penicillium and Aspergillus e.g., [209].
4.3. CBC Species Concept in Codinaea, Codinaeella and Stilbochaeta
The species concepts of Codinaea and two of its segregates, Codinaeella and Stilbochaeta, were corroborated by morphological, molecular, and geographical data. In addition, the interspecific relationships were studied using the CBC species concept. The in-depth analysis of the ITS2 molecule was performed on these three genera because they are species-rich and have available DNA data.
The CBC species concept is based on the identification of canonical pairs that are subject to mutual substitution in helices H1−H3 of the ITS2 molecule [104,105,107,108]. The CBC substitutions can serve as molecular signatures and can be used to delimit biological species. At the RNA structural level, species are further characterized by hCBCs and non-CBCs, which evolve rapidly and occur more frequently than CBCs. However, members of these three genera, with one exception, do not form sexual stages under natural conditions and sexual mating has never been observed under laboratory conditions. Therefore, the CBC criterion was assessed independently of sexual reproduction [108].
The CBC analysis corroborated only one species in Codinaea (although 13 species were distinguished based on morphological and molecular data), one in Codinaeella (8 species), and two in Stilbochaeta (8 species). The lack of CBCs and a greater number of detected hCBCs and some non-CBCs substitutions among their members may indicate that the speciation process has not been completed. Caisová et al. [210] suggested that the fast evolving hCBCs and short-lived non-CBCs substitutions may enable faster ecological adaptations of organisms followed by changes in morphology.
In Codinaea, the CBC occurred only in C. phasma, other hCBCs and non-CBCs substitutions were detected in C. amazonensis, C. gonytrichodes, and C. phasma. These species, which have the major changes in their primary and secondary structure, clustered near the base of the Codinaea clade, and represent three distinct morphotypes, C3, C4, and C1, respectively. A similar situation was observed in Codinaeella. The only CBC occurred in C. parvilobata. With the exception of Ca. pini, Ca. parvilobata has the longest branch of all species, corresponding to the greatest number of genetic changes. However, hCBCs were detected in all species; they were particularly common in Ca. lambertiae, Ca. mimusopis, and Ca. pini. In Stilbochaeta, we identified two CBCs for S. brevisetula in H2 and one CBC for S. aquatica in H3. Both species also had the most hCBCs of all Stilbochaeta species. Stilbochaeta brevisetula has the longest branch compared to other species in the genus and is shown as a sister to a subclade containing other members of the genus. In addition, two non-CBCs events occurred in the area identified as an asymmetrical loop in H3. It contained nine unpaired nucleotides in S. septata and seven in S. cangshanensis, whereas in other species the loop was smaller and consisted of only five nucleotides.
4.4. Ancestral State Reconstruction
Our evolutionary and ancestral state reconstructions showed that the distribution of morphological characters corresponds largely with the phylogenetic clustering. The reconstructions of the ancestral state typically showed the presence of all states in the ancestral nodes and subsequent evolution toward the lineages with a rather homogenous set of a single character. The exception is the genus Menispora, which still retains the ancestral polymorphism, with high morphological variability between closely related species. This also shows that morphological characters defined here are stable and are taxonomically informative in most genera.
We showed that the studied fungi evolved in the temperate regions of Eurasia and Americas and that presence in the tropics and on other continents is secondary. Needless to say, our analyses may also be affected by the sampling bias (fewer samples from the tropics and Africa) and by the fact that many geographic records have not been validated with molecular data.
4.5. Global Biogeography of Codinaea and Related Fungi
In this study, we compared geographic range and ecology known from literature and field records with those retrieved from metabarcoding data in GlobalFungi. Most literature and field data originate from plant debris, while dataming showed that 64% of all samples were obtained from the bulk soil in forests and others from the non-forest sites. Soil samples represent 43% of all samples in GlobalFungi. Therefore, we assume that the relatively high affinity of the studied fungi for soil is not an artefact of sampling; rather these fungi should also be considered soil dwellers, where they live in the form of mycelia, conidia, or ascospores (chlamydospores have never been observed in culture or on natural substrate).
Concerning geographical distribution, we can conclude that GlobalFungi and the previously known distribution patterns correspond in the case of ten species, such as C. amazonensis, C. assamica, C. fertilis, C. gonytrichodes, C. lignicola, C. phasma, C. terminalis, Ca. minuta, Ca. yunnanensis, and S. septata. In five species, the area of distribution was confirmed and further expanded within the same climatic zone, i.e., C. paniculata, Ca. lutea, Ca. parvilobata, S. cangshanensis, S. malaysiana. Two species, S. novae-guineensis and S. ramulosetula, were not found in the same geographical areas, but were nevertheless identified in the same climatic zone. For the other species, GlobalFungi data confirmed the already known area of distribution and further expanded it in terms of geography and climate (C. pandanicola, C. siamensis). The only notable exception from the generally good fit was Ca. pini, which was so far reported from the tropical Uganda only, but GlobalFungi shows it in temperate zone of North America. In the case of C. gonytrichodes and Ca. filamentosa, GlobalFungi results correspond with the geographical origin of the studied strains and published records that were not verified by DNA data, and show their distribution also in other continents and climatic zones.
Assigning three species of Codinaea, such as C. parva, C. simplex, and C. vulgaris from New Zealand, to Tainosphaeria in the absence of molecular data was challenging. Their transfer, based on the study of type material and morphological characters, was supported by biogeographic data. In addition, it was revealed that the interpretation of C. simplex varied among the authors and that the fungus could be misidentified as Codinaeella minuta with the main area of distribution in Holarctic realm in Europe and North America and partially in Asia in the Near East and Japan. According to GlobalFungi, members of Tainosphaeria are widely distributed in Australasia and Southeast Asia. Tainosphaeria jonesii and related species are abundant in New Zealand and Southeast Asia, which is consistent with the published records of T. jonesii and similar fungi [29,30,47]. Based on known data [49,57], the second centre of distribution is in Central America, where T. crassiparies, the type species, and T. cecropiae occur. This is also in agreement with the origin of T. parva, T. simplex and T. vulgaris, whereas the geographical distribution of Ca. minuta does not extend into Australia and New Zealand.
In the BLASTn search, GlobalFungi used the complete sequence similarity rule, which may limit the observed distribution in the case of more genetically variable species. Thus, study of additional haplotypes of the particular species can increase its observed range accordingly. Other option is to use more relaxed similarity threshold (e.g., 99.4%) to cover broader intraspecies variability. However, such step increases the risk of joining more biological species together. Using our rigorous approach, we found that the geographical distribution of the fungi studied primarily follows the climatic zones. This pattern is typical of filamentous, saprobic fungi [117,211].
5. Conclusions
The genus Codinaea has become a large heterogeneous group of phialidic dematiaceous hyphomycetes with hyaline, setulate conidia, and for more than 30 years was considered synonymous with the genus Dictyochaeta. The taxonomy of these fungi has relied mainly on morphological criteria. Little was known about their systematics and global biogeography. The morphotypes that have been associated with different species of Codinaea over time have never been investigated using molecular data. We studied morphological, molecular, and biogeographic data of a large set of species, including all available ex-type strains. The present study shows that Codinaea is a highly polyphyletic taxon unrelated to Dictyochaeta and that its original delimitation based on a single morphotype of C. aristata is too narrow and unsustainable. In fact, three additional morphotypes were assigned to the strongly supported monophyletic clade of Codinaea. Phylogenetic analyses and ancestral state reconstruction showed that the development of some morphological traits, previously considered significant at the generic level, seem to be evolutionarily correlated and can occur is species of a single genus. In this context, the morphotypes associated with Codinaea, Chloridium, and Menispora share similar variability and were compared. In the phylogenetic analysis of three nuclear markers (ITS, 28S and tef1-α), several former Codinaea and Dictyochaeta species clustered in five unknown lineages and were introduced as new genera, i.e., Codinaeella, Nimesporella, Stilbochaeta, Tainosphaeriella, and Xyladelphia. In addition, we designated two epitypes (S. brevisetula and S. ramulosetula) and a lectotype (C. aristata), and we also proposed four new species and 28 new combinations. For all ex-type and validated non-type strains the reference ITS and tef1-α barcode sequences were generated to allow for fast and accurate identification. The studied genera comprise fungi commonly occurring on decaying plant matter, such as decaying wood, bark, wooden fruits (often buried in soil), stems, leaf litter, bamboo and palm fronds, some of them exhibit endophytic lifestyle, occasionally they were isolated from soil or occur as plant pathogens.
Our research highlights the importance of studying the combination of microscopic morphological characters developed in culture and under natural conditions for identification. Some diagnostic characteristics, especially setae, and their arrangement with conidiophores, occur mainly on the natural substrate. However, when grown in culture, these features may not develop or their formation is delayed by weeks or months. Nutrient media such as CMA with sterile stems of U. dioica and SNA with sterile pine needles proved useful in obtaining morphological characteristics similar to those in nature. To improve our knowledge of the genus Codinaea and similar taxa we would like to support general efforts to obtain living culture and molecular data of these interesting and morphologically variable fungi. In the long-term, we hope to initiate studies that will result in a rational phylogeny-based classification of Codinaea and find answers regarding the value of morphological characters traditionally used to delimit hyphomycetous genera.
This study, together with Réblová et al. [86], demonstrates that GlobalFungi shows very good agreement with known reports on geographic distribution and provides additional valuable information. In particular, datamining of ITS barcodes from cultivation independent studies can fundamentally increase our knowledge about the diversity, biogeography, and ecology of studied taxa. Exceptions to the low agreement between the two approaches can be explained by gaps in sampling, i.e., understudied areas of South America and Africa and limited knowledge of intraspecies variation. The newly used approach can be especially helpful in the study of inconspicuous and rare fungi. The processing of metabarcoding data has expanded the known distribution, identified new biodiversity hotspots, and added new information on species ecology. In particular, environmental sequence data confirm that members of Codinaea, Codinaeella, and Stilbochaeta live also as pure soil fungi, even in the cropland soil. Their distribution pattern is restricted to Holarctic realm including Nearctic and Palearctic, tropical climate zones including Neotropics and Paleotropics and some species also occur in South Africa, Southeast Asia and Australasia. Interestingly, their distribution never reaches boreal climatic zone. The reconstruction of the ancestral geographical distribution showed Eurasia or Eurasia and Americas as ancestral, whereas the presence in African and Australasian areas as derived. In our study, we optimized the GlobalFungi datamining workflow, which includes (1) identifying of the barcoding gap for each spacer, (2) BLASTn searching with the full-length coverage requirement, and (3) checking for potential artefacts due to the misidentified ITS1 and ITS2 spacer ends in the GlobalFungi database (see Section 2.7.).
Supplementary Materials
The following are available online at https://www.mdpi.com/article/10.3390/jof7121097/s1, Figure S1: Ancestral state reconstruction of conidial shape calculated by Multistate function in Bayestraits implemented is Rasp v.4.2, Figure S2: Detailed maps of the geographical distribution of Codinaea, Codinaeella and Stilbochaeta species based on the GlobalFungi database, Figure S3: Colony morphology of Codinaeella minuta after four weeks (country of origin of each strain is indicated), Figure S4: Colony morphology of Codinaeella minuta after four weeks (country of origin of each strain is indicated), Table S1: Taxa, isolate information and accession numbers for sequences retrieved from GenBank, Table S2: Estimates of evolutionary divergence between ITS rDNA and tef1-α sequences of members of Codinaea, Codinaeella, and Stilbochaeta, Table S3: The biogeography, substrate and habitat affinity of Codinaea, Codinaeella, and Stilbochaeta inferred from the GlobalFungi database, Table S4: A synopsis table of accepted species of Codinaea based on observations from nature and culture, Table S5: A synopsis table of accepted species of Codinaeella based on observations from nature and culture, Table S6: A synopsis table of accepted species of Stilbochaeta based on observations from nature and culture.
Author Contributions
Conceptualization: M.K., M.H.-R. and M.R.; methodology: J.N., M.K., M.H.-R., K.R., F.S. and M.R.; formal analysis: M.K., F.S., K.R. and M.R.; investigation: A.N.M., J.N., M.K., M.H.-R., K.R., F.S. and M.R.; resources: M.H.-R. and M.R.; visualization: M.R.; writing—original draft: M.K., M.H.-R., K.R., F.S. and M.R.; writing—review and editing: A.N.M., J.N., M.K., M.H.-R., K.R., F.S. and M.R; funding acquisition: M.R. All authors have read and agreed to the published version of the manuscript.
Funding
This study was supported by the project of the Czech Science Foundation (GAČR 20-14840S), and as long-term research development projects of the Czech Academy of Sciences, Institute of Botany (RVO 67985939) (K.R., M.R., F.S.), BIOCEV (CZ.1.05/1.1.00/02.0109) (M.K., F.S.) and the University Hospital Hradec Králové MH CZ—DRO (UHHK, 00179906) (J.N.). This study was also supported by a National Science Foundation award (DEB-0515558) to A.N.M. The WM Keck Center at the University of Illinois Urbana-Champaign is thanked for sequencing services. The field work of M.R. in New Zealand was partly supported by Studienstiftung für mykologische Systematik und Ökologie (2003) and Manaaki Whenua Fellowship, Landcare Research Auckland (2005).
Institutional Review Board Statement
Not applicable.
Informed Consent Statement
Not applicable.
Data Availability Statement
All sequences generated in this study were submitted to GenBank (ITS: OL654076–OL654132; 28S: OL654133–OL654187; tef1-α: OL653988–OL654069).
Acknowledgments
Keith A. Seifert, Jacques Fournier and Gerald Bills are thanked for providing strains and specimens of the studied fungi. Peter Johnston is thanked for his assistance to M.R. in obtaining the Manaaki Whenua Fellowship and collecting permits for New Zealand. We thank Sabine Huhndorf for the use of her collections and DNA extracts. We thank Konstanze Bensch and Shaun Pennycook for grammatical review of new names. Cony Decock (MUCL), Dana Lančová (PRA), Charmaine van Eeden and Trix Merkx (CBS), Adrienne Stanton (PDD), and Megan Peterson (ICMP) are acknowledged for assistance with obtaining living cultures and herbarium loans and depositing new herbarium material and strains.
Conflicts of Interest
The authors declare no conflict of interest. The funders had no role in the design of the study; in the collection, analyses, or interpretation of data; in the writing of the manuscript, or in the decision to publish the results.
References
- Maire, R. Fungi Catalaunici: Series altera. Contributions a l’étude de la flore mycologique de la Catalogne. Publ. Inst. Bot. Barcelona 1937, 3, 1–128. [Google Scholar]
- Hughes, S.J.; Kendrick, W.B. New Zealand fungi 12. Menispora, Codinaea, Menisporopsis. N. Z. J. Bot. 1968, 6, 323–375. [Google Scholar] [CrossRef]
- Agnihothrudu, V. Notes on fungi from North-east India. XVII. Menisporella Assamica gen. et sp. nov. Proc. Natl. Acad. Sci. India Sect. B Biol. Sci. 1962, 56, 97–102. [Google Scholar]
- MycoBank Database. Available online: www.mycobank.org (accessed on 1 September 2021).
- Matsushima, T. Icones Microfungorum a Matsushima Lectorum; Matsushima: Kobe, Japan, 1975. [Google Scholar]
- Shearer, C.A.; Crane, J.L. Fungi of the Chesapeake Bay and its tributaries. I. Patuxent River. Mycologia 1971, 63, 237–260. [Google Scholar] [CrossRef]
- Sutton, B.C. Microfungi from Australian leaf litter. Proc. R. Soc. Qld. 1980, 91, 11–19. [Google Scholar]
- Maggi, O.; Persiani, A.M. Codinaea coffeae and Phialocephala xalapensis, two new Hyphomycetes from Mexico. Mycotaxon 1984, 20, 251–258. [Google Scholar]
- Granados, M.; Castañeda Ruiz, R.F.; Castro, O.; Minter, D.W.; Kendrick, B. Microfungi from Costa Rica. A new species and a new combination of Codinaea. Mycotaxon 2014, 127, 115–120. [Google Scholar] [CrossRef]
- Crous, P.W.; Wingfield, M.J.; Burgess, T.I.; Carnegie, A.J.; Hardy, G.S.J.; Smith, D.; Summerell, B.A.; Cano-Lira, J.F.; Guarro, J.; Houbraken, J.; et al. Fungal Planet description sheets: 625–715. Persoonia 2017, 39, 270–467. [Google Scholar] [CrossRef] [PubMed]
- Spegazzini, C. Algunos hongos de Tierra del Fuego. Physis (Buenos Aires) 1923, 7, 9–23. [Google Scholar]
- Réblová, M.; Nekvindová, J.; Kolařík, M.; Hernández-Restrepo, M. Delimitation and phylogeny of Dictyochaeta, and introduction of Achrochaeta and Tubulicolla genera nova. Mycologia 2021, 113, 390–433. [Google Scholar] [CrossRef]
- Arambarri, A.M.; Cabello, M.N. A numerical taxonomic study of some phialidic genera of Hyphomycetes: Cluster analysis. Mycotaxon 1989, 34, 679–696. [Google Scholar]
- Kuthubutheen, A.J.; Nawawi, A. Key to Dictyochaeta and Codinaea species. Mycol. Res. 1991, 95, 1224–1229. [Google Scholar] [CrossRef]
- Réblová, M.; Winka, K. Phylogeny of Chaetosphaeria and its anamorphs based on morphological and molecular data. Mycologia 2000, 92, 939–954. [Google Scholar] [CrossRef]
- Seifert, K.A.; Morgan-Jones, G.; Gams, W.; Kendrick, B. The Genera of Hyphomycetes; CBS Biodiversity Series no. 9: 1–997; CBS-KNAW Fungal Biodiversity Centre: Utrecht, The Netherlands, 2011. [Google Scholar]
- Matsushima, T. Microfungi of the Solomon Islands and Papua New Guinea; Matsushima: Kobe, Japan, 1971. [Google Scholar]
- Matsushima, T. Matsushima Mycological Memoirs. Matsushima Mycol. Mem. 1981, 2, 1–68. [Google Scholar]
- Kuthubutheen, A.J. Two new species of Dictyochaeta from Malaysia. Trans. Br. Mycol. Soc. 1987, 89, 353–358. [Google Scholar] [CrossRef]
- Kuthubutheen, A.J. A new synnematous Dictyochaeta from Malaysia. Trans. Br. Mycol. Soc. 1987, 89, 411–414. [Google Scholar] [CrossRef]
- Kuthubutheen, A.J.; Nawawi, A. Dictyochaeta hamata and D. pahangensis, two new species with lateral phialides. Mycol. Res. 1990, 94, 840–846. [Google Scholar] [CrossRef]
- Kuthubutheen, A.J.; Nawawi, A. Three new species of Dictyochaeta with non-setose conidiophores and non-septate setulate conidia from Malaysia. Mycol. Res. 1991, 95, 104–107. [Google Scholar] [CrossRef]
- Kuthubutheen, A.J.; Nawawi, A. Dictyochaeta macrospora sp. nov.: A litter-inhabiting hyphomycete from Malaysia. Mycol. Res. 1991, 95, 248–250. [Google Scholar] [CrossRef]
- Kuthubutheen, A.J.; Nawawi, A. Eight new species of Dictyochaeta (Hyphomycetes) from Malaysia. Mycol. Res. 1991, 95, 1211–1219. [Google Scholar] [CrossRef]
- Kuthubutheen, A.J.; Nawawi, A. Dictyochaeta guadalcanalensis comb. nov. and several new records of the genus in Malaysia. Mycol. Res. 1991, 95, 1220–1223. [Google Scholar] [CrossRef]
- Holubová-Jechová, V. Lignicolous hyphomycetes from Czechoslovakia 7. Chalara, Exochalara, Fusiclalara and Dictyochaeta. Folia Geobot. Phytotax. 1984, 19, 387–438. [Google Scholar] [CrossRef]
- Hewings, A.D.; Crane, J.L. The genus Codinaea. Three new species from the Americas. Mycotaxon 1981, 13, 419–427. [Google Scholar]
- Wei, M.J.; Zhang, H.; Dong, W.; Boonmee, S.; Zhang, D. Introducing Dictyochaeta aquatica sp. nov. and two new species of Chloridium (Chaetosphaeriaceae Sordariomycetes) from aquatic habitats. Phytotaxa 2018, 362, 187–199. [Google Scholar] [CrossRef]
- Luo, Z.L.; Hyde, K.D.; Liu, J.K.; Maharachchikumbura, S.S.N.; Jeewon, R.; Bao, D.F.; Bhat, D.J.; Lin, C.G.; Li, W.L.; Yang, J.; et al. Freshwater Sordariomycetes. Fungal Divers. 2019, 99, 451–660. [Google Scholar] [CrossRef]
- Lin, C.G.; McKenzie, E.H.C.; Liu, J.K.; Jones, E.B.G.; Hyde, K.D. Hyaline-spored chaetosphaeriaceous hyphomycetes from Thailand and China, with a review of the family Chaetosphaeriaceae. Mycosphere 2019, 10, 655–700. [Google Scholar] [CrossRef]
- Sutton, B.C.; Hodges, C.S., Jr. Eucalyptus microfungi: Codinaea and Zanclospora species from Brazil. Nova Hedw. 1975, 26, 517–525. [Google Scholar]
- Lunghini, D.; Rambelli, A.; Onofri, S. New Codinaea species from tropical forest litter. Mycotaxon 1982, 14, 116–124. [Google Scholar]
- Castañeda-Ruíz, R.F. Fungi Cubenses I; Instituto de Investigaciones Funfamentales en Agricultura Tropical ‘Alejandro de Humboldt’: Habana, Cuba, 1986. [Google Scholar]
- Kirschner, R.; Chen, C.-J. Dictyochaeta multifimbriata, a new species from Taiwan. Mycol. Prog. 2002, 1, 287–289. [Google Scholar] [CrossRef]
- Rambelli, A.; Mulas, B.; Pasqualetti, M. Comparative studies on microfungi in tropical ecosystems in Ivory Coast forest litter: Behaviour on different substrata. Mycol. Res. 2004, 108, 325–336. [Google Scholar] [CrossRef]
- Santos, R.F.; Sotão, H.M.P.; Monteiro, J.S.; Gusmão, L.F.P.; Gutiérrez, A.H. Conidial fungi associated with leaf litter of red cedar (Cedrela odorata) in Belém, Pará (eastern Brazilian Amazon). Acta Amaz. 2018, 48, 230–238. [Google Scholar] [CrossRef]
- Barbosa, F.R.; Raja, H.A.; Shearer, C.A.; Gusmão, L.F.P. Some freshwater fungi from the Brazilian semi-arid region, including two new species of hyphomycetes. Cryptogam. Mycol. 2013, 34, 243–258. [Google Scholar] [CrossRef]
- Crous, P.W.; Wingfield, M.J.; Schumacher, R.K.; Summerell, B.A.; Giraldo, A.; Gené, J.; Guarro, J.; Wanasinghe, D.N.; Hyde, K.D.; Camporesi, E.; et al. Fungal Planet Description Sheets: 281–319. Persoonia 2014, 33, 212–289. [Google Scholar] [CrossRef]
- Link, H.F. Observationes in ordines plantarum naturales. Dissertatio, I. Sber. Ges. naturf. Freunde Berl. 1809, 3, 3–42. [Google Scholar]
- Nees von Esenbeck, C.G.D.; Nees von Esenbeck, T.F.L. De plantis nonnullis e mycetoidearum regno tum nuper detectis, tum minus cognitis commentatio prior doctoris Nees ab Esenbeck et Friderici Nees fratrum. Nova Acta Phys.-Med. Acad. Caes. Leop.-Carol. Nat. Cur. 1818, 9, 226–262. [Google Scholar]
- Persoon, C.H. Mycologia Europaea 1: I-[ii], 1-356, [iii-iv], plates 1-12; J.J. Palmius: Erlangen, Germany, 1822. [Google Scholar]
- Morgan-Jones, G. Notes on Hyphomycetes. X. Codinaeopsis gen. nov. Mycotaxon 1976, 4, 166–170. [Google Scholar]
- Arambarri, A.M.; Cabello, M.N. Considerations about Dictyochaeta, Codinaeopsis and a new genus, Dictyochaetopsis. Mycotaxon 1990, 38, 11–14. [Google Scholar]
- Whitton, S.R.; McKenzie, E.H.C.; Hyde, K.D. Dictyochaeta and Dictyochaetopsis species from the Pandanaceae. Fungal Divers. 2000, 4, 133–158. [Google Scholar]
- Samuels, G.J.; Müller, E. Life-history studies of Brazilian Ascomycetes. 1. Two new genera of Sphaeriaceae having, respectively, Sporoschisma-like and Codinaea anamorphs. Sydowia 1978, 31, 126–136. [Google Scholar]
- Réblová, M.; Nekvindová, J.; Fournier, J.; Miller, A.N. Delimitation, new species and teleomorph-anamorph relationships in Codinaea, Dendrophoma, Paragaeumannomyces and Striatosphaeria (Chaetosphaeriaceae). MycoKeys 2020, 74, 17–74. [Google Scholar] [CrossRef]
- Liu, J.K.; Yang, J.; Maharachchikumbura, S.S.N.; McKenzie, E.H.C.; Jones, E.B.G.; Hyde, K.D.; Liu, Z.Y. Novel chaetosphaeriaceous hyphomycetes from aquatic habitats. Mycol. Prog. 2016, 15, 1157–1167. [Google Scholar] [CrossRef]
- Tibpromma, S.; Hyde, K.D.; McKenzie, E.H.C.; Bhat, D.J.; Phillips, A.J.L.; Wanasinghe, D.N.; Samarakoon, M.C.; Jayawardena, R.S.; Dissanayake, A.J.; Tennakoon, D.S.; et al. Fungal diversity notes 840–928: Micro-fungi associated with Pandanaceae. Fungal Divers. 2018, 93, 1–160. [Google Scholar] [CrossRef]
- Réblová, M.; Nekvindová, J.; Hernández-Restrepo, M. Reflections on Menisporopsis, Multiguttulispora and Tainosphaeria using molecular and morphological Data. J. Fungi 2021, 7, 438. [Google Scholar] [CrossRef]
- Zheng, H.; Wan, Y.; Li, J.; Castañeda-Ruiz, R.F.; Yu, Z. Phialolunulospora vermispora (Chaetosphaeriaceae, Sordariomycetes), a novel asexual genus and species from freshwater in southern China. MycoKeys 2020, 76, 17–30. [Google Scholar] [CrossRef]
- Toyazaki, N.; Udagawa, S. An undescribed pleomorphic species of Codinaea. Mycotaxon 1981, 13, 450–456. [Google Scholar]
- MyCoPortal. Available online: http://mycoportal.org (accessed on 18 October 2021).
- Crous, P.W.; Wingfield, M.J.; Guarro, J.; Hernández-Restrepo, M.; Sutton, D.A.; Acharya, K.; Barber, P.A.; Boekhout, T.; Dimitrov, R.A.; Dueñas, M.; et al. Fungal Planet description sheets: 320–370. Persoonia 2015, 34, 167–266. [Google Scholar] [CrossRef] [PubMed]
- Menzies, S.A. Root rot of clover caused by Codinaea fertilis. N. Z. J. Agric. Res. 1973, 16, 239–245. [Google Scholar] [CrossRef]
- Morgan-Jones, G. Notes on Hyphomycetes. XL. New species of Codinaea and Veronaea. Mycotaxon 1982, 14, 175–180. [Google Scholar]
- Skipp, R.A.; Christensen, M.J. Fungi invading roots of perennial ryegrass (Lolium perenne L.) in pasture. N. Z. J. Agric. Res. 1989, 32, 423–431. [Google Scholar] [CrossRef]
- Fernández, F.A.; Huhndorf, S.M. New species of Chaetosphaeria, Melanopsammella and Tainosphaeria gen. nov. from the Americas. Fungal Divers. 2005, 18, 15–57. [Google Scholar]
- Sayers, E.W.; Cavanaugh, M.; Clark, K.; Ostell, J.; Pruitt, K.D.; Karsch-Mizrachi, I. GenBank. Nucleic Acids Res. 2019, 47, D94–D99. [Google Scholar] [CrossRef]
- Nilsson, R.H.; Larsson, K.-H.; Taylor, A.F.S.; Bengtsson-Palme, J.; Jeppesen, T.S.; Schigel, D.; Kennedy, P.; Picard, K.; Glöckner, F.O.; Tedersoo, L.; et al. The UNITE database for molecular identification of fungi: Handling dark taxa and parallel taxonomic classifications. Nucleic Acids Res. 2019, 47, D259–D264. [Google Scholar] [CrossRef] [PubMed]
- Větrovský, T.; Morais, D.; Kohout, P.; Lepinay, C.; Algora, C.; Hollá, S.A.; Bahnmann, B.D.; Bílohnědá, K.; Brabcová, V.; D’Alò, F. GlobalFungi, a global database of fungal occurrences from high-throughput-sequencing metabarcoding studies. Sci. Data 2020, 7, 1–14. [Google Scholar] [CrossRef]
- GlobalFungi Database. Available online: Globalfungi.com (accessed on 25 October 2021).
- Malloch, D. Moulds: Their Isolation, Cultivation and Identification; University of Toronto Press: Toronto, ON, Canada, 1981. [Google Scholar]
- Crous, P.W.; Verkley, G.J.M.; Groenewald, J.Z.; Houbraken, J. Fungal Biodiversity. CBS Laboratory Manual Series 1; CBS-KNAW Fungal Biodiversity Centre: Utrecht, The Netherlands, 2019. [Google Scholar]
- de Hoog, G.S.; Weenink, X.O.; Gerrits van den Ende, A.H.G. Taxonomy of the Phialophora verrucosa complex with the description of two new species. Stud. Mycol. 1999, 43, 107–121. [Google Scholar]
- Vilgalys Mycology Lab—Duke University. Conserved Primer Sequences for PCR Amplification of Fungal rDNA. Available online: https://sites.duke.edu/vilgalyslab/rdna_primers_for_fungi (accessed on 3 January 2017).
- Rehner, S.; Buckley, E. A Beauveria phylogeny inferred from nuclear ITS and EF1-alpha sequences: Evidence for cryptic diversification and links to Cordyceps teleomorphs. Mycologia 2005, 97, 84–98. [Google Scholar] [CrossRef]
- Vilgalys, R.; Hester, M. Rapid genetic identification and mapping of enzymatically amplified ribosomal DNA from several Cryptococcus species. J. Bacteriol. 1990, 172, 4238–4246. [Google Scholar] [CrossRef] [PubMed]
- White, T.J.; Bruns, T.; Lee, S.; Taylor, J. Amplification and direct sequencing of fungal ribosomal RNA genes for phylogenetics. In PCR Protocols: A Guide to Methods and Applications; Innis, M.A., Gelfand, D.H., Sninsky, J.J., White, T.J., Eds.; Academic Press: San Diego, CA, USA, 1990; pp. 315–322. [Google Scholar]
- Landvik, S. Neolecta, a fruit-body-producing genus of the basal ascomycetes, as shown by SSU and LSU DNA sequences. Mycol. Res. 1996, 100, 199–202. [Google Scholar] [CrossRef]
- Huhndorf, S.M.; Fernández, F.A. Teleomorph-anamorph connections: Chaetosphaeria raciborskii and related species, and their Craspedodidymum-like anamorphs. Fungal Divers. 2005, 19, 23–49. [Google Scholar]
- Fernández, F.A.; Miller, A.N.; Huhndorf, S.M.; Lutzoni, F.M.; Zoller, S. Systematics of the genus Chaetosphaeria and its allied genera: Morphological and phylogenetic diversity in north temperate and neotropical taxa. Mycologia 2006, 98, 121–130. [Google Scholar] [CrossRef]
- Atkinson, T.J.; Miller, A.N.; Huhndorf, S.M.; Orlovich, D.A. Unusual new Chaetosphaeria species from New Zealand: Intrafamilial diversity and elucidations of the Chaetosphaeriaceae—Lasiosphaeriaceae relationship (Sordariomycetes, Ascomycotina). N. Z. J. Bot. 2007, 45, 685–706. [Google Scholar] [CrossRef]
- Somrithipol, S.; Sakayaroj, J.; Rungjindamai, N.; Plaingam, N.; Jones, E.B.G. Phylogenetic relationship of the coelomycete genus Infundibulomyces based on nuclear rDNA data. Mycologia 2008, 100, 735–741. [Google Scholar] [CrossRef]
- Prabhugaonkar, A.; Bhat, D.J. Rattania setulifera, an undescribed endophytic hyphomycete on rattans from Western Ghats, India. Mycotaxon 2009, 108, 217–222. [Google Scholar] [CrossRef]
- Crous, P.W.; Verkley, G.J.M.; Christensen, M.; Castañeda-Ruíz, R.F.; Groenewald, J.Z. How important are conidial appendages? Persoonia 2012, 28, 126–137. [Google Scholar] [CrossRef] [PubMed]
- Hashimoto, A.; Sato, G.; Matsuda, T.; Matsumura, M.; Hatakeyama, S.; Harada, Y.; Ikeda, H.; Tanaka, K. Taxonomic revision of Pseudolachnea and Pseudolachnella, and establishment of Neopseudolachnella and Pseudodinemasporium genera nova. Mycologia 2015, 107, 383–408. [Google Scholar] [CrossRef]
- Lu, Y.Z.; Liu, K.J.; Hyde, K.D.; Bhat, D.J.; Xiao, Y.P.; Tian, Q.; Wen, T.C.; Boonmee, S.; Kang, J.C. Brunneodinemasporium jonesii and Tainosphaeria jonesii spp. nov. (Chaetosphaeriaceae, Chaetosphaeriales) from southern China. Mycosphere 2016, 7, 1322–1331. [Google Scholar] [CrossRef]
- Ma, Y.-R.; Xia, J.-W.; Gao, J.-M.; Li, Z.; Zhang, X.-G. Anacacumisporium, a new genus based on morphology and molecular analyses from Hainan, China. Cryptogam. Mycol. 2016, 37, 45–59. [Google Scholar] [CrossRef]
- Magyar, D.; Shoemaker, R.A.; Bobvos, J.; Crous, P.W.; Groenewald, J.Z. Pyrigemmula, a novel hyphomycete genus on grapevine and tree bark from Hungary. Mycol. Prog. 2011, 10, 307–314. [Google Scholar] [CrossRef][Green Version]
- Hernández-Restrepo, M.; Schumacher, R.K.; Wingfield, M.J.; Ahmad, I.; Cai, L.; Duong, T.A.; Edwards, J.; Gené, J.; Groenewald, J.Z.; Jabeen, S.; et al. Fungal Systematics and Evolution: FUSE 2. Sydowia 2016, 68, 193–230. [Google Scholar] [CrossRef]
- Hernández-Restrepo, M.; Gené, J.; Castañeda-Ruíz, R.F.; Mena-Portales, J.; Crous, P.W.; Guarro, J. Phylogeny of saprobic microfungi from Southern Europe. Stud. Mycol. 2017, 86, 53–97. [Google Scholar] [CrossRef]
- Crous, P.W.; Schumacher, R.K.; Wingfield, M.J.; Akulov, A.Y.; Denman, S.; Roux, J.; Braun, U.; Burgess, T.I.; Carnegie, A.J.; Váczy, K.Z.; et al. New and Interesting Fungi. 1. FUSE 2018, 1, 169–215. [Google Scholar] [CrossRef]
- Yang, J.; Liu, N.G.; Liu, J.K.; Hyde, K.D.; Jones, E.B.G.; Liu, Z.Y. Phylogenetic placement of Cryptophiale, Cryptophialoidea, Nawawia, Neonawawia gen. nov. and Phialosporostilbe. Mycosphere 2018, 9, 1132–1150. [Google Scholar] [CrossRef]
- Vu, D.; Groenewald, M.; de Vries, M.; Gehrmann, T.; Stielow, B.; Eberhardt, U.; Al-Hatmi, A.; Groenewald, J.Z.; Cardinali, G.; Houbraken, J.; et al. Large-scale generation and analysis of filamentous fungal DNA barcodes boosts coverage for kingdom fungi and reveals thresholds for fungal species and higher taxon delimitation. Stud. Mycol. 2019, 92, 135–154. [Google Scholar] [CrossRef]
- Réblová, M.; Nekvindová, J.; Miller, A.N. Phylogeny and taxonomy of Catenularia and similar fungi with catenate conidia. MycoKeys 2021, 81, 1–44. [Google Scholar] [CrossRef]
- Réblová, M.; Kolařík, M.; Nekvindová, J.; Miller, A.N.; Hernández-Restrepo, M. Phylogeny, global biogeography and pleomorphism of Zanclospora. Microorganisms 2021, 9, 706. [Google Scholar] [CrossRef] [PubMed]
- Katoh, K.; Standley, D.M. MAFFT multiple sequence alignment software version 7: Improvements in performance and usability. Mol. Biol. Evol. 2013, 30, 772–780. [Google Scholar] [CrossRef]
- Miller, M.A.; Pfeiffer, W.; Schwartz, T. Creating the CIPRES Science Gateway for inference of large phylogenetic trees. In Proceedings of the Gateway Computing Environments Workshop (GCE), New Orleans, LA, USA, 14 November 2010; pp. 1–8. [Google Scholar]
- CIPRES Science Gateway. Available online: www.phylo.org (accessed on 19 October 2021).
- Hall, T.A. BioEdit 5.0.9: A user-friendly biological sequence alignment editor and analysis program for Windows 95/98/NT. Nucleic Acids Symp. Ser. 1999, 41, 95–98. [Google Scholar]
- Gutell, R.R.; Gray, M.W.; Schnare, M.N. A compilation of large subunit (23S and 23 S-like) ribosomal RNA structures. Nucleic Acids Res. 1993, 21, 3055–3074. [Google Scholar] [CrossRef] [PubMed]
- Nylander, J.A.A. MrModeltest v2. Program Distributed by the Author. Evolutionary Biology Centre; Uppsala University: Uppsala, Sweden, 2004. [Google Scholar]
- Stamatakis, A. RAxML Version 8: A tool for Phylogenetic analysis and post-analysis of large phylogenies. Bioinformatics 2014, 30, 1312–1313. [Google Scholar] [CrossRef]
- Ronquist, F.; Teslenko, M.; van der Mark, P.; Ayres, D.L.; Darling, A.; Höhna, S.; Larget, B.; Liu, L.; Suchard, M.A.; Huelsenbeck, J.P. MrBayes 3.2: Efficient Bayesian phylogenetic inference and model choice across a large model space. Syst. Biol. 2012, 61, 539–542. [Google Scholar] [CrossRef]
- Kumar, S.; Stecher, G.; Li, M.; Knyaz, C.; Tamura, K. MEGA X: Molecular Evolutionary Genetics Analysis across computing platforms. Mol. Biol. Evol. 2018, 35, 1547–1549. [Google Scholar] [CrossRef]
- Kimura, M. A simple method for estimating evolutionary rates of base substitutions through comparative studies of nucleotide sequences. J. Mol. Evol. 1980, 16, 111–120. [Google Scholar] [CrossRef]
- Sükösd, Z.; Knudsen, B.; Kjems, J.; Pedersen, C.N.S. PPfold 3.0: Fast RNA secondary structure prediction using phylogeny and auxiliary data. Bioinformatics 2012, 28, 2691–2692. [Google Scholar] [CrossRef]
- Markham, N.R.; Zuker, M. UNAFold: Software for Nucleic Acid Folding and Hybridization. Methods Mol. Biol. 2008, 453, 3–31. [Google Scholar] [CrossRef]
- UNAfold Web Server. Available online: www.unafold.org (accessed on 29 July 2021).
- Zuker, M. Mfold web server for nucleic acid folding and hybridization prediction. Nucleic Acids Res. 2003, 31, 3406–3415. [Google Scholar] [CrossRef]
- Darty, K.; Denise, A.; Ponty, Y. VARNA: Interactive drawing and editing of the RNA secondary structure. Bioinformatics 2009, 25, 1974–1975. [Google Scholar] [CrossRef] [PubMed]
- Wolf, M.; Friedrich, J.; Dandekar, T.; Müller, T. CBC Analyzer: Inferring phylogenies based on compensatory base changes in RNA secondary structures. Silico Biol. 2005, 5, 0027. [Google Scholar]
- Coleman, A.W.; Mai, J.C. Ribosomal DNA ITS-1 and ITS-2 sequence comparisons as a tool for predicting genetic relatedness. J. Mol. Evol. 1997, 45, 168–177. [Google Scholar] [CrossRef]
- Coleman, A.W. The significance of a coincidence between evolutionary landmarks found in mating affinity and a DNA sequence. Protist 2000, 151, 1–9. [Google Scholar] [CrossRef] [PubMed]
- Coleman, A.W. Pan-eukaryote ITS2 homologies revealed by RNA secondary structure. Nucleic Acids Res. 2007, 35, 3322–3329. [Google Scholar] [CrossRef] [PubMed]
- Coleman, A.W. Is there a molecular key to the level of “biological species” in eukaryotes? A DNA guide. Mol. Phyl. Evol. 2009, 50, 197–203. [Google Scholar] [CrossRef]
- Coleman, A.W.; Vacquier, V.D. Exploring the phylogenetic utility of ITS sequences for animals: A test case for abalone (Haliotis). J. Mol. Evol. 2002, 54, 246–257. [Google Scholar] [CrossRef] [PubMed]
- Müller, T.; Philippi, N.; Dandekar, T.; Schultz, J.; Wolf, M. Distinguishing species. RNA 2007, 13, 1469–1472. [Google Scholar] [CrossRef]
- Leontis, N.B.; Stombaugh, J.; Westhof, E. The non-Watson-Crick base pairs and their associated isostericity matrices. Nucleic Acids Res. 2002, 30, 3497–3531. [Google Scholar] [CrossRef] [PubMed]
- Yu, Y.; Blair, C.; He, X.J. RASP (Reconstruct Ancestral State in Phylogenies): A tool for historical biogeography. Mol. Biol. Evol. 2020, 37, 604–606. [Google Scholar] [CrossRef] [PubMed]
- Posada, D. jModelTest: Phylogenetic model averaging. Mol. Biol. Evol. 2008, 25, 1253–1256. [Google Scholar] [CrossRef]
- Zhang, Z.; Schwartz, S.; Wagner, L.; Miller, W. A greedy algorithm for aligning DNA sequences. J. Comput. Biol. 2000, 7, 203–214. [Google Scholar] [CrossRef]
- Bengtsson-Palme, J.; Ryberg, M.; Hartmann, M.; Branco, S.; Wang, Z.; Godhe, A.; Wit, P.; Sánchez-García, M.; Ebersberger, I.; Sousa, F. Improved software detection and extraction of ITS1 and ITS2 from ribosomal ITS sequences of fungi and other eukaryotes for analysis of environmental sequencing data. Methods Ecol. Evol. 2013, 4, 914–919. [Google Scholar] [CrossRef]
- Beck, H.E.; Zimmermann, N.E.; McVicar, T.R.; Vergopolan, N.; Berg, A.; Wood, E.F. Present and future Köppen-Geiger climate classification maps at 1-km resolution. Sci. Data 2018, 5, 1–12. [Google Scholar] [CrossRef]
- Bayranvand, M.; Akbarinia, M.; Salehi Jouzani, G.; Gharechahi, J.; Kooch, Y.; Baldrian, P. Composition of soil bacterial and fungal communities in relation to vegetation composition and soil characteristics along an altitudinal gradient. FEMS Microb. Ecol. 2020, 97, fiaa201. [Google Scholar] [CrossRef]
- Peay, K.G.; Baraloto, C.; Fine, P.V. Strong coupling of plant and fungal community structure across western Amazonian rainforests. ISME J. 2013, 7, 1852–1861. [Google Scholar] [CrossRef]
- Tedersoo, L.; Bahram, M.; Põlme, S. Global diversity and geography of soil fungi. Science 2014, 346, 1256688. [Google Scholar] [CrossRef]
- Urbina, H.; Scofield, D.G.; Cafaro, M.; Rosling, A. DNA-metabarcoding uncovers the diversity of soil-inhabiting fungi in the tropical island of Puerto Rico. Mycoscience 2016, 57, 217–227. [Google Scholar] [CrossRef]
- Zhou, J.Z.; Deng, Y.; Shen, L.N.; Wen, C.Q.; Yan, Q.Y.; Ning, D.L.; Qin, Y.J.; Xue, K.; Wu, L.Y.; He, Z.L.; et al. Temperature mediates continental-scale diversity of microbes in forest soils. Nat. Commun. 2016, 7, 12083. [Google Scholar] [CrossRef] [PubMed]
- Subramanian, C.V.; Bhat, D.J. Bahusutrabeeja, a new genus of the Hyphomycetes. Can. J. Bot. 1977, 55, 2202–2206. [Google Scholar] [CrossRef]
- da Cruz, A.C.R.; Leão-Ferreira, S.M.; Barbosa, F.R.; Gusmão, L.F.P. Conidial fungi from semi-arid Caatinga biome of Brazil. New and interesting Dictyochaeta species. Mycotaxon 2008, 106, 15–27. [Google Scholar]
- Goh, T.K.; Hyde, K.D. Fungi on submerged wood and bamboo in the Plover Cove Reservoir, Hong Kong. Fungal Divers. 1999, 3, 57–85. [Google Scholar]
- Bhat, D.J.; Sutton, B.C. Some phialidic Hyphomycetes from Ethiopia. Trans. Br. Mycol. Soc. 1985, 84, 723–730. [Google Scholar] [CrossRef]
- Oliveira, M.S.; Malosso, E.; Castañeda-Ruíz, R.F. A new species and a new combination in Codinaea from Brazil. Mycotaxon 2015, 130, 1045–1049. [Google Scholar] [CrossRef]
- Barbosa, M.A.; Costa, P.M.O.; Malosso, E.; Castañeda-Ruíz, R.F. Codinaea leomaiae sp. nov. from the Brazilian Atlantic Forest. Mycotaxon 2016, 131, 423–428. [Google Scholar] [CrossRef]
- Bhat, D.J.; Kendrick, W.B. Twenty-five new conidial fungi from the Western Ghats and the Andaman Islands (India). Mycotaxon 1993, 49, 19–90. [Google Scholar]
- Castañeda-Ruíz, R.F.; Gusmão, L.F.P.; Guarro, J.; Stchigel, A.M.; Stadler, M.; Saikawa, M.; Leão-Ferreira, S.M. Two new anamorphic fungi from Brazil: Dictyochaetopsis polysetosa and Myrothecium compactum. Mycotaxon 2008, 103, 1–8. [Google Scholar]
- Matsushima, T. Matsushima mycological memoirs. Matsushima Mycol. Mem. 1993, 7, 1–141. [Google Scholar]
- Castañeda-Ruíz, R.F.; Guarro, J.; Velázquez-Noa, S.; Gené, J. A new species of Minimelanolocus and some hyphomycete records from rain forests in Brazil. Mycotaxon 2003, 85, 231–239. [Google Scholar]
- Czeczuga, B.; Orłowska, M. Hyphomycetes in rain water, melting snow and ice. Acta Mycol. 1999, 34, 181–200. [Google Scholar] [CrossRef]
- Icones Fungorum Hucusque Cognitorum 3; Calve, J.G., Ed.; Prague, Czech Republic, 1839; Available online: https://bibdigital.rjb.csic.es/ (accessed on 1 November 2021).
- Hughes, S.J.; Kendrick, W.B. Microfungi. IX. Menispora Persoon. Canadian J. Bot. 1963, 41, 693–718. [Google Scholar] [CrossRef]
- Réblová, M.; Seifert, K.A.; White, G.P. Chaetosphaeria tortuosa, the newly discovered teleomorph of Menispora tortuosa, with a key to known Menispora species. Mycol. Res. 2006, 110, 104–109. [Google Scholar] [CrossRef]
- Minter, D.W.; Rodríguez Hernández, M.; Mena-Portales, J. Fungi of the Caribbean: An Annotated Checklist; PDMS Publishing: Isleworth, Middlesex, UK, 2001. [Google Scholar]
- Pratibha, J.; Raghukumar, S.; Bhat, D.J. Diversity of litter degrading microfungi from the forests of Western Ghats, India. In Biodiversity and Taxonomy; BijuKumar, A., Nayar, M.P., Varma, R.V., Peethambaran, C.K., Eds.; Narendra Publishing House: New Delhi, India, 2012; pp. 195–210. [Google Scholar]
- Gomes, S.I.; Merckx, V.S.; Saavedra, S. Fungal-host diversity among mycoheterotrophic plants increases proportionally to their fungal-host overlap. Ecol. Evol. 2017, 7, 3623–3630. [Google Scholar] [CrossRef] [PubMed]
- Tsui, C.K.M.; Goh, T.K.; Hyde, K.D.; Hodgkiss, I.J. New species or records of Cacumisporium, Helicosporium, Monotosporella and Bahusutrabeeja on submerged wood in Hong Kong streams. Mycologia 2001, 93, 389–397. [Google Scholar] [CrossRef]
- Wu, W.P.; McKenzie, E.H.C. Obeliospora minima sp. nov. and four other hyphomycetes with conidia bearing appendages. Fungal Divers. 2003, 12, 223–234. [Google Scholar]
- McKenzie, E.H.C. Bahusutrabeeja bunyensis sp. nov. (Hyphomycetes) from Queensland, Australia, and a new name for Chalara australis McKenzie. Mycotaxon 1997, 61, 303–306. [Google Scholar]
- Rao, V.G.; de Hoog, G.S. New or critical Hyphomycetes from India. Stud. Mycol. 1986, 28, 1–84. [Google Scholar]
- Marvanová, L. New or noteworthy aquatic hyphomycetes. Trans. Br. Mycol. Soc. 1980, 75, 221–231. [Google Scholar] [CrossRef]
- Grandi, R.A.P. Hyphomycetes decompositores 1. Espécies associadas às raízes de Calathea stromata (horticultural). Rev. Brasil. Biol. 1989, 50, 123–132. [Google Scholar]
- Grandi, R.A.P. Hyphomycetes decompositores 2. Táxons associados às raízes de Maranta bicolor Ker. Rev. Bras. Biol. 1991, 51, 133–141. [Google Scholar]
- Grandi, R.A.P. Hyphomycetes decompositores 3. Espécies associadas às raízes de Stromanthe sanguinea Sond. Rev. Bras. Biol. 1992, 52, 275–282. [Google Scholar]
- McKenzie, E.H.C.; Buchanan, P.K.; Johnston, P.R. Checklist of fungi on Nothofagus species in New Zealand. N. Z. J. Bot. 2000, 38, 635–720. [Google Scholar] [CrossRef]
- Marques, M.F.O.; Gusmão, L.F.P.; Maia, L.C. Riqueza de espécies de fungos conidiais em duas áreas de Mata Atlântica no Morro da Pioneira, Serra da Jibóia, BA, Brasil. Acta Bot. Brasilica 2008, 22, 954–961. [Google Scholar] [CrossRef]
- Santa Izabel, T.S.; Gusmão, L.F.P. Fungal succession on plant debris in three humid forests enclaves in the Caatinga biome of Brazil. Braz. J. Bot. 2016, 39, 1065–1076. [Google Scholar] [CrossRef]
- Monteiro, J.S.; Sarmento, P.S.M.; Sotão, H.M.P. Saprobic conidial fungi associated with palm leaf litter in eastern Amazon, Brazil. An. Acad. Bras. Cienc. 2019, 91, e20180545. [Google Scholar] [CrossRef]
- Campbell, C.L. Root rot of ladino clover induced by Codinaea fertlis. Plant Dis. 1980, 64, 9659–9960. [Google Scholar] [CrossRef]
- Campbell, C.L. Cultural characteristics and host range of Codinaea fertilis. Phytopathology 1982, 72, 501–504. [Google Scholar] [CrossRef]
- Lim, L.L.; Cole, A.L.J. Infection and colonisation of white clover seedling roots by fungi. N. Z. J. Agric. Res. 1984, 27, 459–465. [Google Scholar] [CrossRef]
- Tubaki, K. Descriptive catalogue of IFO fungus collection IV. IFO Res. Commun. 1975, 7, 113–142. [Google Scholar]
- Barbosa, F.R.; Gusmão, L.F.P. Conidial fungi from semi-arid Caatinga Biome of Brazil. Rare freshwater hyphomycetes and other new records. Mycosphere 2011, 4, 475–485. [Google Scholar]
- Walker, D.M.; Lawrence, B.R.; Esterline, D.; Graham, S.P.; Edelbrock, M.A.; Wooten, J.A. A metagenomics-based approach to the top-down effect on the detritivore food web: A salamanders influence on fungal communities within a deciduous forest. Ecol. Evol. 2014, 4, 4106–4116. [Google Scholar] [CrossRef] [PubMed]
- Park, K.H.; Oh, S.Y.; Yoo, S.; Fong, J.J.; Kim, C.S.; Jo, J.W.; Lim, Y.W. Influence of Season and Soil Properties on Fungal Communities of Neighboring Climax Forests (Carpinus cordata and Fraxinus rhynchophylla). Front. Microbiol. 2020, 11, 572706. [Google Scholar] [CrossRef]
- Tu, B.; Domene, X.; Yao, M.; Li, C.; Zhang, S.; Kou, Y.; Wang, Y.; Li, X. Microbial diversity in Chinese temperate steppe: Unveiling the most influential environmental drivers. FEMS Microbiol. Ecol. 2017, 93, fix031. [Google Scholar] [CrossRef]
- Schroeder, J.W.; Martin, J.T.; Angulo, D.F.; Arias-Del Razo, I.; Barbosa, J.M.; Perea, R.; Sebastián-González, E.; Dirzo, R. Host plant phylogeny and abundance predict root-associated fungal community composition and diversity of mutualists and pathogens. J. Ecol. 2019, 107, 1557–1566. [Google Scholar] [CrossRef]
- Kerfahi, D.; Tripathi, B.M.; Dong, K.; Go, R.; Adams, J.M. Rainforest Conversion to Rubber Plantation May Not Result in Lower Soil Diversity of Bacteria, Fungi, and Nematodes. Microb. Ecol. 2016, 72, 359–371. [Google Scholar] [CrossRef]
- David, A.S.; May, G.; Schmidt, D.; Seabloom, E.W. Beachgrass invasion in coastal dunes is mediated by soil microbes and lack of disturbance dependence. Ecosphere 2016, 11, e01527. [Google Scholar] [CrossRef]
- Johnson, J.; Evans, C.; Brown, N.; Skeates, S.; Watkinson, S.; Bass, D. Molecular analysis shows that soil fungi from ancient semi-natural woodland exist in sites converted to non-native conifer plantations. Forestry 2014, 87, 705–717. [Google Scholar] [CrossRef][Green Version]
- Guo, J.; Ling, N.; Chen, Z.; Xue, C.; Li, L.; Liu, L.; Gao, L.; Wang, M.; Ruan, J.; Guo, S.; et al. Soil fungal assemblage complexity is dependent on soil fertility and dominated by deterministic processes. New Phytol. 2019, 226, 232–243. [Google Scholar] [CrossRef] [PubMed]
- Song, H.; Singh, D.; Tomlinson, K.W.; Yang, X.; Ogwu, M.C.; Slik, J.F.; Adams, J.M. Tropical forest conversion to rubber plantation in southwest China results in lower fungal beta diversity and reduced network complexity. FEMS Microbiol. Ecol. 2019, 95, fiz092. [Google Scholar] [CrossRef] [PubMed]
- Arambarri, A.; Cabello, M.; Mengascini, A. New hyphomycetes from Santiago River (Buenos Aires Province, Argentina). Mycotaxon 1987, 29, 29–35. [Google Scholar]
- Reddy, S.M.; Reddy, S.S. A new species of Codinaea. Sydowia 1978, 30, 186–188. [Google Scholar]
- Matsushima, T. Matsushima Mycological Memoirs. Matsushima Mycol. Mem. 1987, 5, 1–100. [Google Scholar]
- Li, D.W.; Kendrick, B.; Chen, J.Y. Two new hyphomycetes: Codinaea sinensis sp. nov. and Parapleurotheciopsis quercicola sp. nov., and two new records from Quercus phillyraeoides leaf litter. Mycol. Prog. 2012, 11, 899–905. [Google Scholar] [CrossRef]
- Anthony, M.; Frey, S.; Stinson, K. Fungal community homogenization, shift in dominant trophic guild, and appearance of novel taxa with biotic invasion. Ecosphere 2017, 8, e01951. [Google Scholar] [CrossRef]
- Trevathan-Tackett, S.M.; Allnutt, T.R.; Sherman, C.D.; Richardson, M.F.; Crowley, T.M.; Macreadie, P.I. Spatial variation of bacterial and fungal communities of estuarine seagrass leaf microbiomes. Aquat. Microb. Ecol. 2020, 84, 59–74. [Google Scholar] [CrossRef]
- Bissett, A.; Fitzgerald, A.; Meintjes, T.; Mele, P.M.; Reith, F.; Dennis, P.G.; Breed, M.F.; Brown, B.; Brown, M.V.; Brugger, J.; et al. Introducing BASE: The Biomes of Australian Soil Environments soil microbial diversity database. GigaScience 2016, 5, 21. [Google Scholar] [CrossRef]
- George, P.B.; Lallias, D.; Creer, S.; Seaton, F.M.; Kenny, J.G.; Eccles, R.M.; Griffiths, R.I.; Lebron, I.; Emmett, B.A.; Robinson, D.A. Divergent national-scale trends of microbial and animal biodiversity revealed across diverse temperate soil ecosystems. Nat. Commun. 2019, 10, 1–11. [Google Scholar] [CrossRef]
- Boeraeve, M.; Honnay, O.; Mullens, N.; Vandekerkhove, K.; De Keersmaeker, L.; Thomaes, A.; Jacquemyn, H. The impact of spatial isolation and local habitat conditions on colonization of recent forest stands by ectomycorrhizal fungi. For. Ecol. Manag. 2018, 429, 84–92. [Google Scholar] [CrossRef]
- Frøslev, T.G.; Kjøller, R.; Bruun, H.H.; Ejrnæs, R.; Hansen, A.J.; Læssøe, T.; Heilmann-Clausen, J. Man against machine: Do fungal fruitbodies and eDNA give similar biodiversity assessments across broad environmental gradients? Biol. Conserv. 2019, 233, 201–212. [Google Scholar] [CrossRef]
- Duan, Y.; Xie, N.; Song, Z.; Ward, C.S.; Yung, C.-M.; Hunt, D.E.; Johnson, Z.I.; Wang, G. A high-resolution time series reveals distinct seasonal patterns of planktonic fungi at a temperate coastal ocean site (Beaufort, North Carolina, USA). Appl. Environ. Microbiol. 2018, 84, e00967-18. [Google Scholar] [CrossRef]
- Tubaki, K. Studies on the Japanese Hyphomycetes. V. Leaf & stem group with a discussion of the classification of the Hyphomycetes and their perfect stages. J. Hattori Bot. Lab. 1958, 20, 142–244. [Google Scholar]
- VanMiddlesworth, F.; Omstead, M.N.; Schmatz, D.; Bartizal, K.; Fromtling, R.; Bills, G.; Nollstadt, K.; Honeycutt, S.; Zweerink, M.; Garrity, G.; et al. L-687,781, a new member of the papulacandin family of beta-1,3-d-glucan synthesis inhibitors. I. Fermentation, isolation, and biological activity. J. Antibiot. Tokyo 1991, 44, 45–51. [Google Scholar] [CrossRef] [PubMed]
- VanMiddlesworth, F.; Dufresne, C.; Smith, J.; Wilson, K.E. Structure elucidation of L-687,781, a new β-1,3-d-glucan synthesis inhibitor. Tetrahedron 1991, 47, 7563–7568. [Google Scholar] [CrossRef]
- Wilhelm, R.C.; Cardenas, E.; Leung, H.; Maas, K.; Hartmann, M.; Hahn, A.; Hallam, S.; Mohn, W.W. A metagenomic survey of forest soil microbial communities more than a decade after timber harvesting. Sci. Data 2017, 4, 1–8. [Google Scholar] [CrossRef] [PubMed][Green Version]
- Oono, R.; Rasmussen, A.; Lefèvre, E. Distance decay relationships in foliar fungal endophytes are driven by rare taxa. Environ. Microbiol. 2017, 19, 2794–2805. [Google Scholar] [CrossRef] [PubMed]
- Liu, J.; Jia, X.; Yan, W.; Zhong, Y.; Shangguan, Z. Changes in soil microbial community structure during long-term secondary succession. Land Degrad. Dev. 2020, 31, 1151–1166. [Google Scholar] [CrossRef]
- Onofri, S.; Zucconi, L. Hyphomycetes rari o interessanti della foresta tropicale. I. Codinaea novae-guineensis. Emendamento della diagnosi specifica. Micl. Ital. 1984, 1, 53–54. [Google Scholar]
- Cai, L.; Zhang, K.; McKenzie, E.H.C.; Hyde, K.D. Linocarpon bambusicola sp. nov. and Dictyochaeta curvispora sp. nov. from bamboo submerged in freshwater. Nova Hedw. 2004, 78, 439–445. [Google Scholar] [CrossRef]
- Réblová, M.; Gams, W. Life-history of Ascomycetes: Two new species of Chaetosphaeria with Chloridium- and Chloridium-Dictyochaeta anamorphs. Mycoscience 2000, 41, 129–138. [Google Scholar] [CrossRef]
- Cregger, M.; Veach, A.; Yang, Z.; Crouch, M.; Vilgalys, R.; Tuskan, G.; Schadt, C. The Populus holobiont: Dissecting the effects of plant niches and genotype on the microbiome. Microbiome 2018, 6, 1–14. [Google Scholar] [CrossRef]
- Saitta, A.; Anslan, S.; Bahram, M.; Brocca, L.; Tedersoo, L. Tree species identity and diversity drive fungal richness and community composition along an elevational gradient in a Mediterranean ecosystem. Mycorrhiza 2018, 28, 39–47. [Google Scholar] [CrossRef] [PubMed]
- De Gannes, V.; Bekele, I.; Dipchansingh, D.; Wuddivira, M.N.; De Cairies, S.; Boman, M.; Hickey, W.J. Microbial community structure and function of soil following ecosystem conversion from native forests to teak plantation forests. Front. Microbiol. 2016, 7, 1976. [Google Scholar] [CrossRef] [PubMed]
- Da Cruz, A.C.R.; Gusmão, L.F.P. Fungos conidiais na Caatinga: Espécies associadas ao folhedo. Acta Bot. Bras. 2009, 23, 999–1012. [Google Scholar] [CrossRef]
- Crous, P.W.; Wingfield, M.J.; Koch, S.H. New and interesting records of South African fungi. X. New records of Eucalyptus leaf fungi. S. Afr. J. Bot. 1990, 56, 583–586. [Google Scholar] [CrossRef]
- Egidi, E.; Delgado-Baquerizo, M.; Plett, J.M.; Wang, J.; Eldridge, D.J.; Bardgett, R.D.; Maestre, F.T.; Singh, B.K. A few Ascomycota taxa dominate soil fungal communities worldwide. Nat. Commun. 2019, 10, 1–9. [Google Scholar] [CrossRef]
- Yan, D.; Mills, J.G.; Gellie, N.J.; Bissett, A.; Lowe, A.J.; Breed, M.F. High-throughput eDNA monitoring of fungi to track functional recovery in ecological restoration. Biol. Cons. 2018, 217, 113–120. [Google Scholar] [CrossRef]
- Kamutando, C.N.; Vikram, S.; Kamgan-Nkuekam, G.; Makhalanyane, T.P.; Greve, M.; Le Roux, J.J.; Richardson, D.M.; Cowan, D.; Valverde, A. Soil nutritional status and biogeography influence rhizosphere microbial communities associated with the invasive tree Acacia dealbata. Sci. Rep. 2017, 7, 6472. [Google Scholar] [CrossRef]
- Kobayasi, Y. Mycological reports from New Guinea and the Solomon Islands (1–11). Bull. Nat. Sci. Mus. Tokyo 1971, 14, 367–551. [Google Scholar]
- Li, C.X.; Yu, X.D.; Dong, W.; Hu, D.M.; Boonmee, S.; Zhang, H. Freshwater hyphomycetes in Sordariomycetes: Two new species of Tainosphaeria (Chaetosphaeriaceae, Chaetosphaeriales) from Thailand. Phytotaxa 2021, 509, 56–68. [Google Scholar] [CrossRef]
- Jiang, Y.L.; Wu, Y.M.; Zhang, T.Y. New species of Dictyochaeta and Wardomyces from soil. Mycotaxon 2016, 131, 385–390. [Google Scholar] [CrossRef]
- Morgan-Jones, G.; Ingram, E.G. Notes on hyphomycetes. XV. Two new species of Codinaea. Mycotaxon 1976, 4, 504–509. [Google Scholar]
- Holubová-Jechová, V. Studies on hyphomycetes from Cuba VII. Seven new taxa of dematiaceous hyphomycetes. Česká Mykol. 1988, 42, 23–30. [Google Scholar]
- Kirk, P.M. New or interesting microfungi III. A preliminary account of microfungi colonizing Laurus nobilis leaf litter. Trans. Br. Mycol. Soc. 1981, 77, 457–473. [Google Scholar] [CrossRef]
- Borowska, A. Dematiaceae aus der Umgebung von Görlitz (DDR). Mikol. Mitt.-Bl. Halle 1975, 19, 108–112. [Google Scholar]
- Matsushima, T. Saprophytic microfungi from Taiwan Part 1. Hyphomycetes. Matsushima Mycol. Mem. 1980, 1, 1–82. [Google Scholar]
- Ellis, M.B. More Dematiaceous Hyphomycetes; Commonwealth Mycological Institute: Kew, Surrey, UK, 1976. [Google Scholar]
- Kirk, P.M. New or interesting microfungi XIV. Dematiaceous hyphomycetes from Mt Kenya. Mycotaxon 1985, 23, 305–352. [Google Scholar]
- Réblová, M. The genus Chaetosphaeria and its anamorphs. Stud. Mycol. 2000, 45, 149–168. [Google Scholar]
- Gams, W.; Holubová-Jechová, V. Chloridium and some other dematiaceous hyphomycetes growing on decaying wood. Stud. Mycol. 1976, 13, 1–99. [Google Scholar]
- Réblová, M.; Miller, A.N.; Rossman, A.Y.; Seifert, K.A.; Crous, P.W.; Hawksworth, D.L.; Abdel-Wahab, M.A.; Cannon, P.F.; Daranagama, D.A.; De Beer, Z.W.; et al. Recommendations for competing sexual-asexually typified generic names in Sordariomycetes (except Diaporthales, Hypocreales, and Magnaporthales). IMA Fungus 2016, 7, 131–153. [Google Scholar] [CrossRef]
- Almeida, D.A.C.; Miller, A.N.; Gusmão, L.F.P. New species and combinations of conidial fungi from the semi-arid Caatinga biome of Brazil. Nova Hedw. 2014, 98, 431–447. [Google Scholar] [CrossRef]
- Castañeda-Ruíz, R.F. Fungi Cubenses III; Instituto de Investigaciones Funfamentales en Agricultura Tropical ‘Alejandro de Humboldt’: Habana, Cuba, 1988. [Google Scholar]
- Pirozynski, K.A.; Patil, S.D. Some setose Hyphomycetes of leaf litter in south India. Can. J. Bot. 1970, 48, 567–581. [Google Scholar] [CrossRef]
- Calduch, M.; Gené, J.; Stchigel, A.M.; Guarro, J. New species of Dictyochaetopsis and Paraceratocladium from Brazil. Mycologia 2002, 94, 1071–1077. [Google Scholar] [CrossRef]
- Raper, K.B.; Fennel, D.I. The Genus Aspergillus; The Williams and Wilkins Company: Baltimore, MD, USA, 1965. [Google Scholar]
- Okuda, T.; Klich, M.A.; Seifert, K.A.; Ando, K. Media and incubation effects on morphological characteristics of Penicillium and Aspergillus. In Integration of Modern Taxonomic Methods for Penicillium and Aspergillus Classification; Samson, R.A., Pitt, J.I., Eds.; Harwood Academic Publishers: Amsterdam, The Netherlands, 2000; pp. 83–99. [Google Scholar]
- Caisová, L.; Marin, B.; Melkonian, M. A close-up view on ITS2 evolution and speciation—A case study in the Ulvophyceae (Chlorophyta, Viridiplantae). BMC Evol. Biol. 2011, 11, 262. [Google Scholar] [CrossRef]
- Větrovský, T.; Kohout, P.; Kopecký, M.; Machac, A.; Man, M.; Bahnmann, B.D.; Brabcová, V.; Choi, J.; Meszárošová, L.; Human, Z.R.; et al. A meta-analysis of global fungal distribution reveals climate-driven patterns. Nat. Commun. 2019, 10, 5142. [Google Scholar] [CrossRef]
Publisher’s Note: MDPI stays neutral with regard to jurisdictional claims in published maps and institutional affiliations. |
© 2021 by the authors. Licensee MDPI, Basel, Switzerland. This article is an open access article distributed under the terms and conditions of the Creative Commons Attribution (CC BY) license (https://creativecommons.org/licenses/by/4.0/).